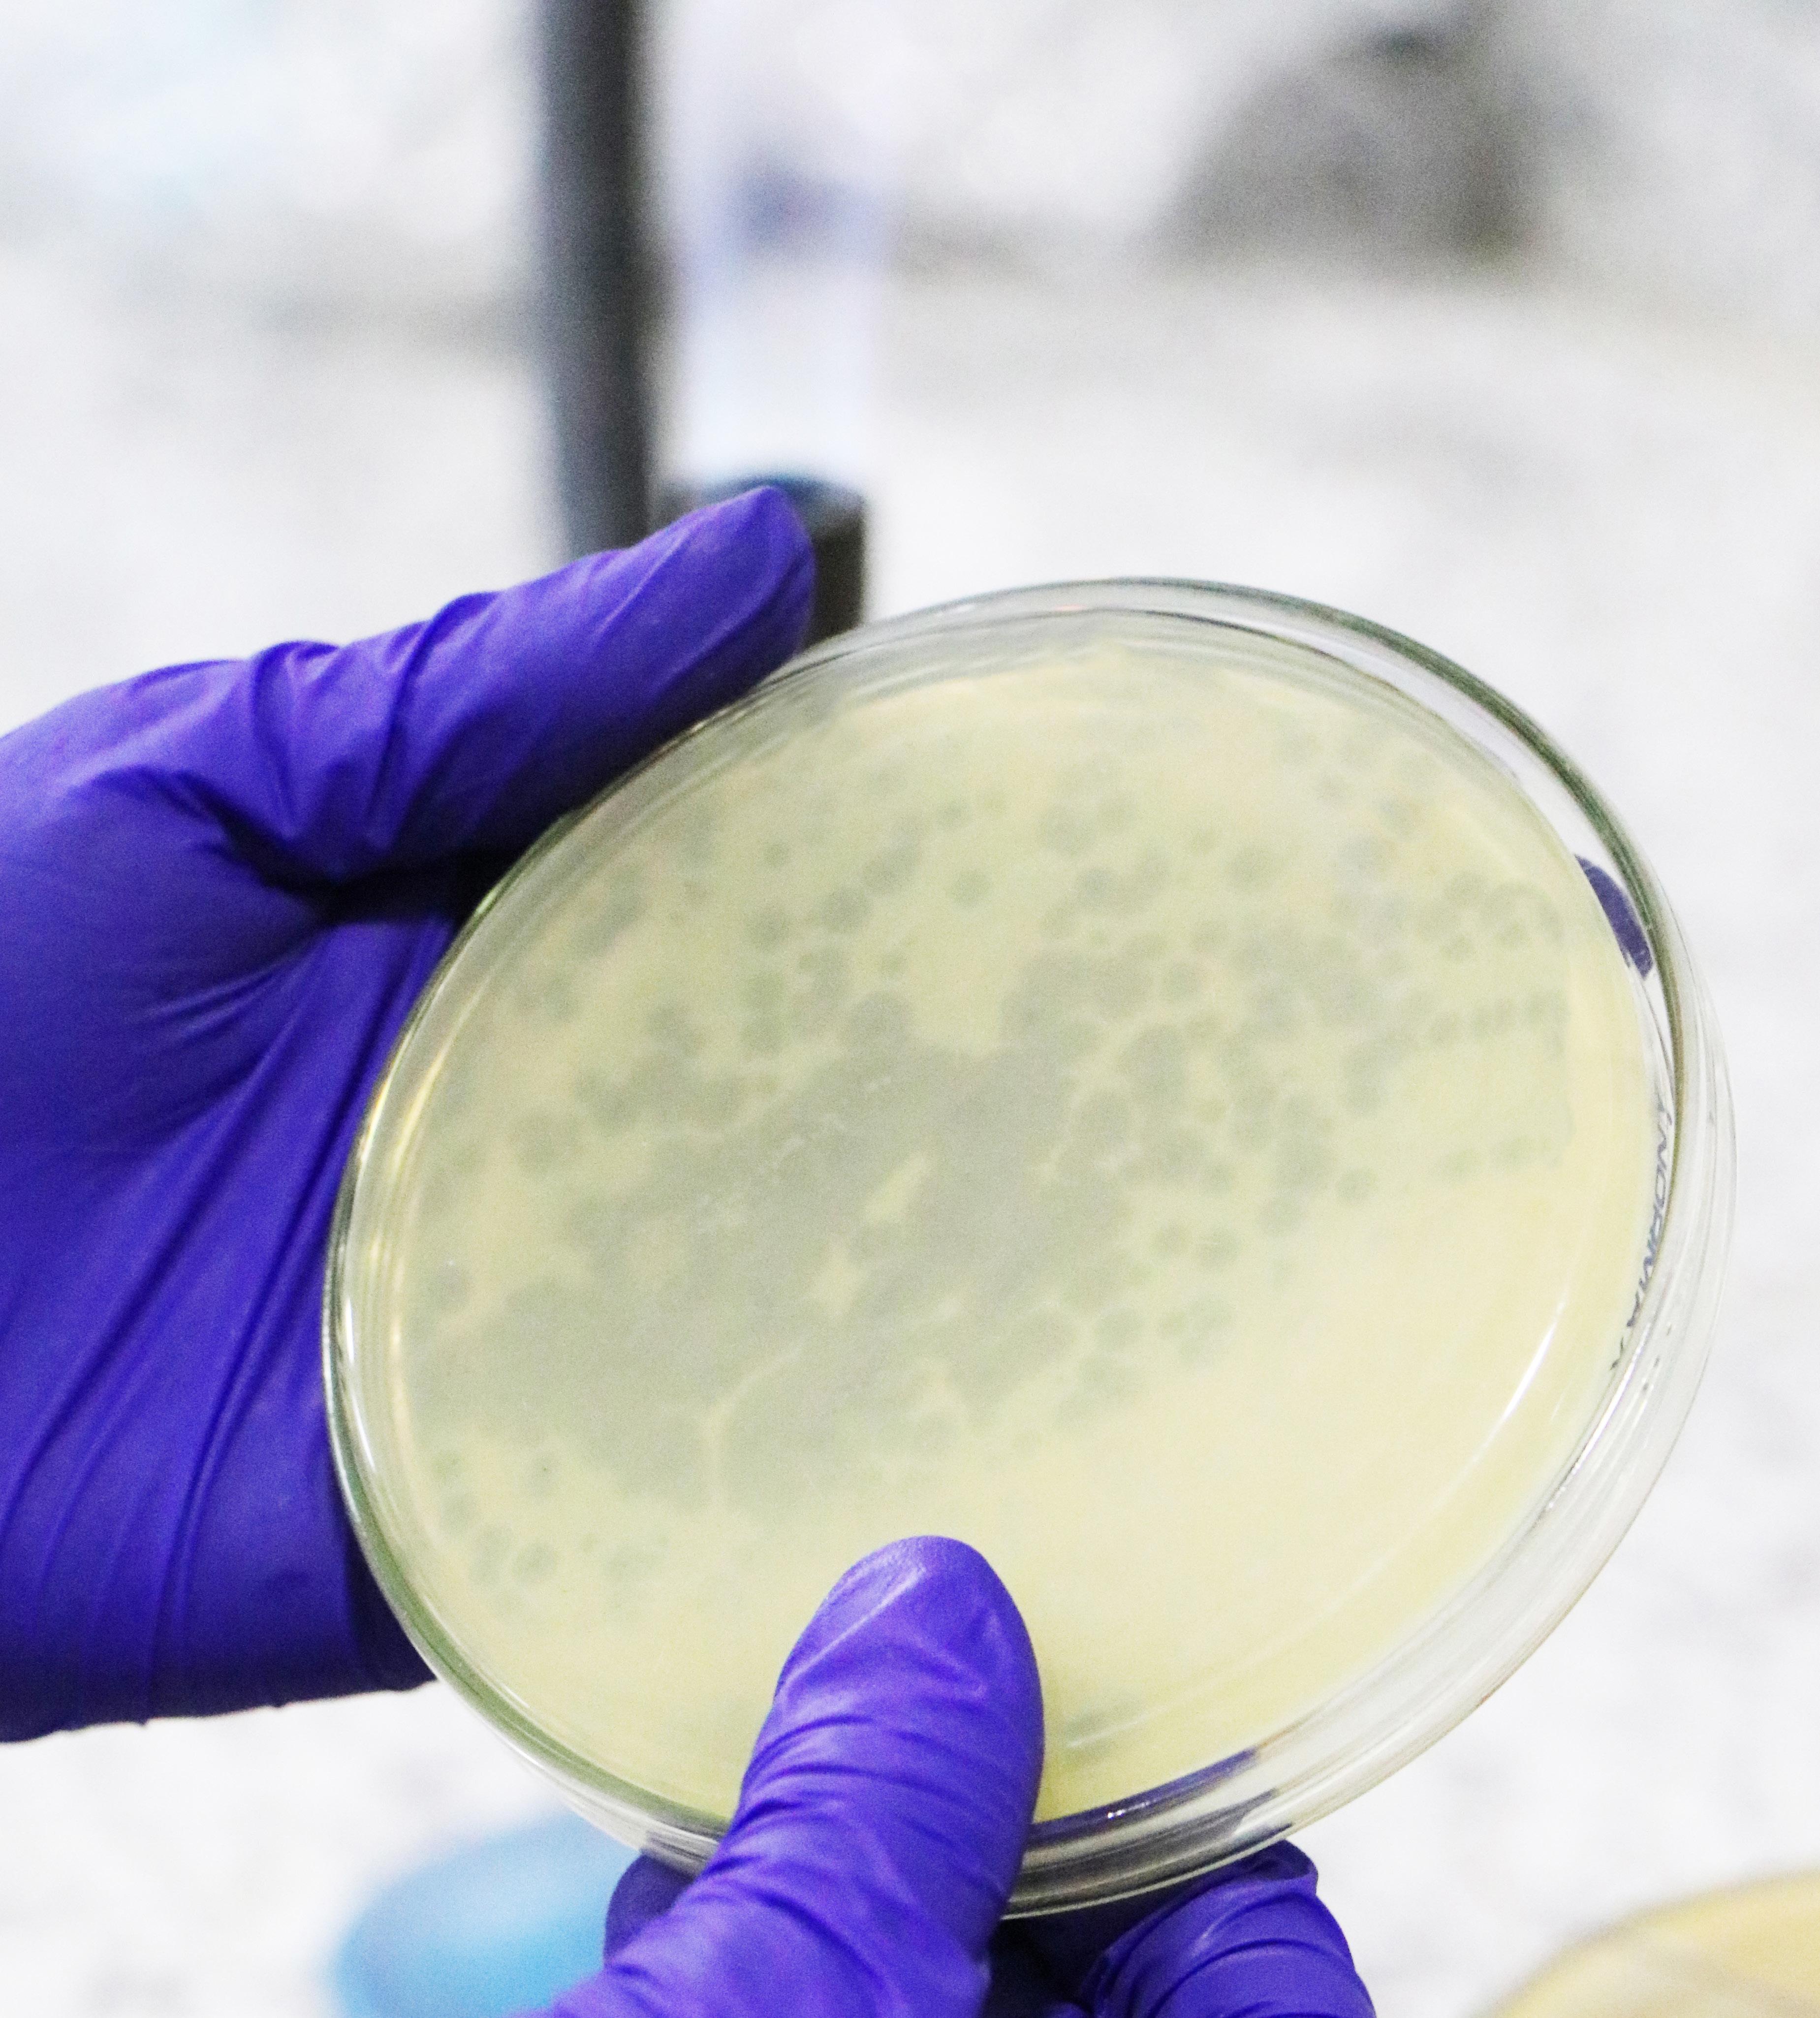
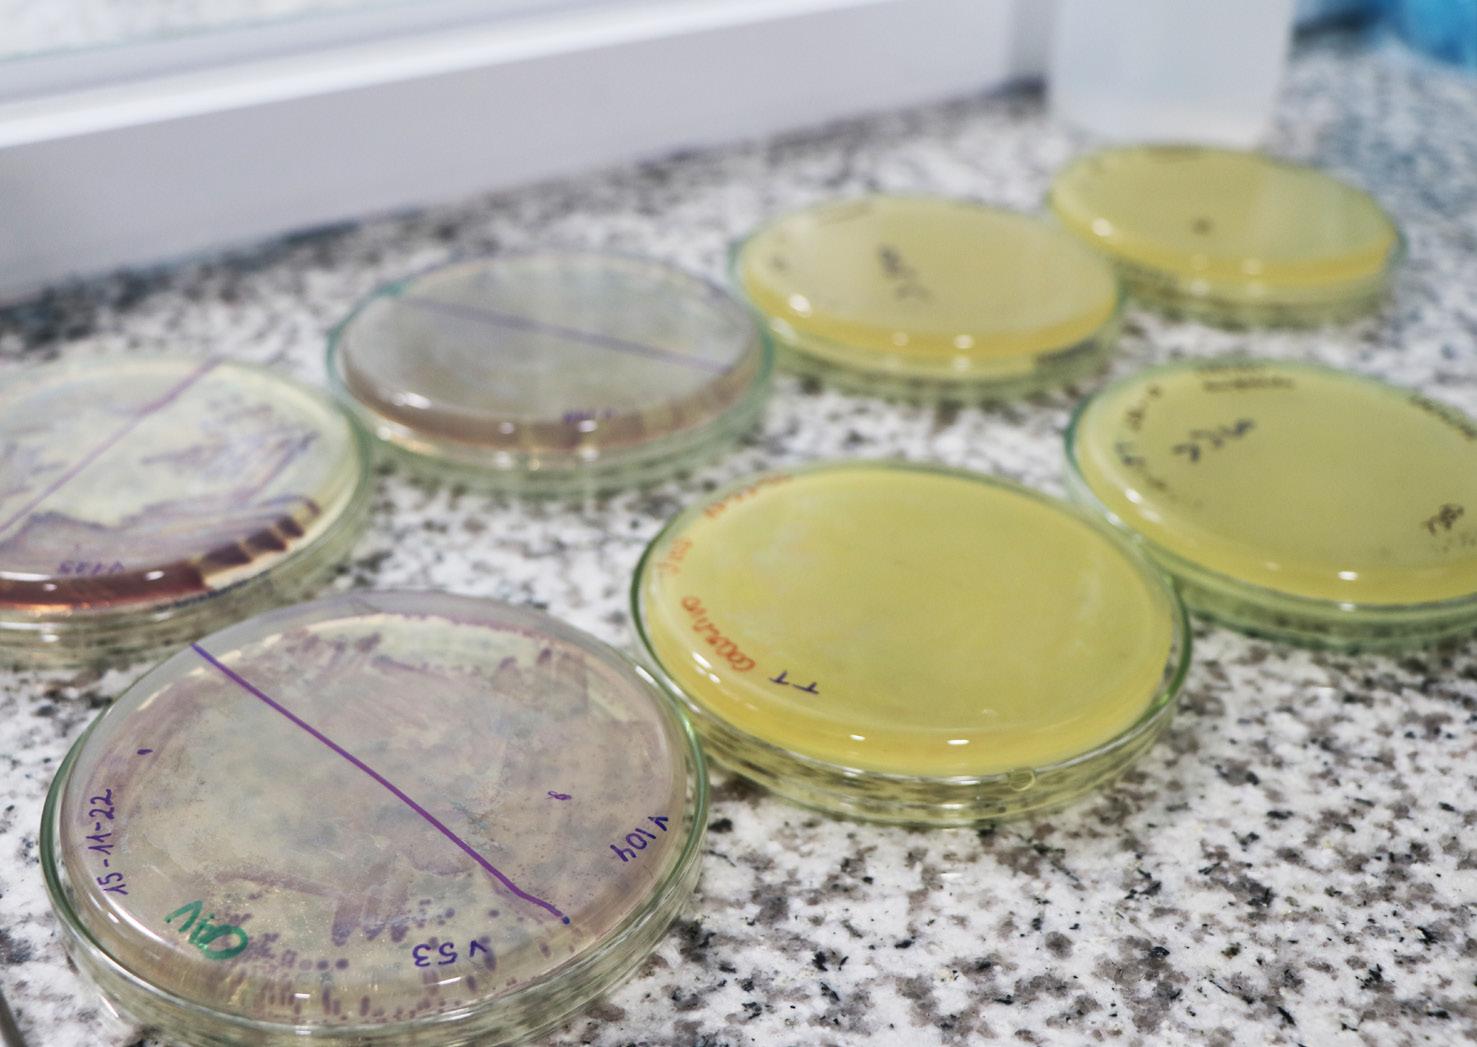

Edición 150 - Diciembre 2022
WWF y la Cámara Nacional de Acuacultura firman convenio de cooperación para proteger los ecosistemas naturales
El camarón ecuatoriano conquistó París
Pabellón Ecuador “First Class Shirmp” aumentó su presencia en ferias internacionales
Sustainable Shrimp Partnership seleccionado como ejemplo a escala mundial por el no uso de antibióticos
Aqua Expo 2022 recibió a más de 10 mil personas en su feria comercial y congreso durante el evento más grande de su historia
150 ediciones Revista Aquacultura

Respuestas tempranas en Penaeus vannamei durante una infección experimental con esporas de Enterocytozoon hepatopenaei (EHP) por inyección y vía oral
Biotecnología para el control de patologías de origen bacteriano en los cultivos de camarón. Estudio de caso de utilización de bacteriófagos líticos endémicos contra Vibrio parahaemolyticus
Dando sentido a la taxonomía de los camarones de mayor importancia comercial Penaeus Fabricius, 1798 s. l. (Crustacea: Decapoda: Penaeidae), un camino a seguir
Proliferación de dinoflagelados en camaroneras, alternativas de control
Capacidad de carga de las piscinas camaroneras
Eficiencia del uso de salvado vegetal en sistemas de fertilización simbiótico sobre la calidad del agua y la composición del zooplancton en la fase de cría de Litopenaeus vannamei
Mejores prácticas tecnológicas en transformación digital: automatización de procesos contables y financieros en las empresas ecuatorianas
Tecnología portátil no intrusiva para el control de seguridad a la carga y el contenedor
Exportaciones de camarón y tilapia
Reporte de mercado de China
Reporte de mercado de EE. UU.
NOTICIAS
Noticias de interés Noticias empresariales
Presidente Ejecutivo Ing. José Antonio Camposano
Editora “AquaCultura” Msc. Shirley Suasnavas ssuasnavas@cna-ecuador.com
Consejo Editorial MSc. Yahira Piedrahita PhD. Leonardo Maridueña Ing. José Antonio Lince Econ. Danny Vélez Ing. Alex de Wind
Diseño y diagramación Ing. Orly Saltos osaltos@cna-ecuador.com
Ing. Roberto Peñafiel rpenafiel@cna-ecuador.com
Corrección de estilo Silvia Idrovo Valverde
Comercialización Gabriela Nivelo gnivelo@cna-ecuador.com
ÍNDICE
INFORMACIÓN DE
ARTÍCULOS TÉCNICOS ESTADÍSTICAS
COYUNTURA
8 10 27 12 14 16 20 38 45 56 62 67 72 78 84 88 92
98 99
Al iniciar este mes de diciembre, el Gobierno nacional anunció la eliminación del precio diferenciado del combustible para el sector camaronero, según las autoridades, para generar un ahorro aproximado de USD 167 millones, a pesar de que dicha cifra no es correcta si se toma en consideración el precio promedio de los combustibles de los últimos ocho años que dejan un cálculo muy inferior al dato utilizado por la actual administración.
Si bien el Ecuador necesita debatir ampliamente sobre las diversas políticas públicas que distorsionan la economía nacional, entre ellas la política de subsidios a los combustibles, esta discusión debe hacerse de forma integral y no parcializada hacia las prioridades del Estado como se hizo con el precio del diésel para el sector camaronero.
Seguramente, si en lugar de emitir un decreto que afecta a más del 90% de la superficie dedicada a la cría de camarón, el Gobierno hubiera revisado junto con los actores del gremio los planes y acciones complementarios que se propuso desde que hacían campaña por la Presidencia, hoy en día estuviéramos hablando de una salida paulatina, ordenada y sin impacto negativo para la actividad que más divisas atrae a la economía nacional, una de las que más ha invertido en los últimos años y la que sostiene a más de 275,000 familias en el Ecuador.
A pesar de lo antes indicado, el Ministerio de Economía y Finanzas, autor del Decreto número 614 que elimina el subsidio, decidió que los camaroneros de 31 hectáreas en adelante cuentan con los niveles de productividad que les permiten absorber un golpe de tal magnitud dejando por fuera de su ligero análisis la crisis de precios internacionales que afecta al sector, el considerable aumento de costos de los últimos 24 meses así como las cargas excesivas que debemos pagar y que nos restan competitividad en los mercados de exportación.
Por ello, el reclamo enérgico que se ha hecho desde la Cámara Nacional de Acuacultura invita a la sociedad ecuatoriana en general a preguntarse ¿Quién subsidia a quién? en un país
José Antonio Camposano Presidente Ejecutivo

¿Quién subsidia a quién?
plagado por la ineficiencia estatal que traslada costos en exceso a la actividad privada, aquella que en total soledad hace colosales esfuerzos por crecer y producir más oportunidades de empleo en el país.
¿Quién subsidia a quién? es la pregunta que desde el sector camaronero hacemos a todos los ecuatorianos, incluida a la actual administración, pues si queremos realmente sincerar la economía debemos apuntar al desmonte total de los subsidios y no como se hace ahora, abordando menos del 7% del monto total cuando aún el Ecuador destinará más de USD 2,5000 millones a subsidios ineficientes a combustibles en 2023. De la misma manera, si la economía debe liberarse entonces el Estado debe inmediatamente cumplir con su obligación de garantizar la seguridad de la cadena de valor del sector camaronero y así evitarle un gasto anual de USD 80 millones de dólares en guardias, custodios a vehículos, sistemas de vigilancia y otros costos relacionados.
Si desde el Gobierno se quiere ser más eficiente en el uso de los recursos disponibles entonces se debe impulsar de verdad, no en el papel o PowerPoint, una política energética real que lleve el servicio de energía eléctrica a zonas rurales con tarifas competitivas y sin recargos absurdos como el alumbrado público o la recolección de basura. De igual forma, prestar más atención a polos industriales que, hoy en día, están amenazados por falta de dotación de energía eléctrica ante la creciente demanda.
Asimismo, como desde el Gobierno se dice que se debe dar uso adecuado a los recursos entonces es necesario que se deje sin efecto la política de fijación de precios y obligación de absorción de grano de soya local, situación que esta administración aún no corrige y que le cuesta al sector privado USD 15 millones al año, es decir un subsidio agrícola creado por el Gobierno, pero que sale del bolsillo del sector camaronero.
Si se quiere debatir sobre la permanencia de los subsidios en el Ecuador entonces que se abra el debate, hagamos cuentas y terminaremos viendo ¿Quién subsidia a quién?•
EDITORIAL
DIRECTORIO
PRIMER VICEPRESIDENTE
Ing. José Antonio Lince PRESIDENTE DEL DIRECTORIO Econ. Carlos Miranda
Ing. Ricardo Solá Blgo. Carlos Sánchez Ing. Alex Olsen Ing. Ori Nadan Ing. Luis Francisco Burgos Ing. Jorge Redrovan Sr. Isauro Fajardo Tinoco Ing. Kléber Sigúenza Ing. Oswin Crespo Econ. Sandro Coglitore Ing. Rodrigo Laniado Ing. Diego Puente
VOCALES
Ing. Bastien Hurtado Ing. Alejandro Ruiz Ing. Alex Elghoul Ing. Humberto Dieguez Ing. Rodrigo Vélez Dr. Marcos Tello Ing. Santiago León Cap. Segundo Calderón Ing. Miguel Loaiza Ing. Freddy Arias Sr. Leonardo de Wind Ing. Fabricio Vargas
SEGUNDO VICEPRESIDENTE

Ing. Marcelo Vélez
Ing. Francisco Pons Dr. Alejandro Aguayo Econ. Heinz Grunauer Ing. Víctor Ramos Ing. David Eguiguren Ing. Eduardo Seminario Ing. Roberto Aguirre Ing. Johnny Adum Ing. Miguel Uscocovich Ing. Iván Rodríguez Sra. Verónica Dueñas Econ. Danny Vélez Sr. Telmo Romero

WWF Ecuador y la Cámara Nacional de Acuacultura firman convenio de cooperación para proteger los ecosistemas naturales
The World Wildlife Fund WWF de Estados Unidos y la Cámara Nacional de Acuacultura (CNA) de Ecuador firmaron un acuerdo para mitigar la deforestación e impulsar la conversión de ecosistemas naturales. Este acuerdo marca el compromiso nacional para la acuicultura sin conversión.
Ecuador alberga el bosque de manglar más grande del hemisferio oriental. El nuevo acuerdo entre WWF-Ecuador y CNA utilizará datos geoespaciales generados por Clark Labs para analizar y clasificar la cobertura terrestre en las regiones costeras, donde el cultivo de camarón es más común. Usando esta investigación y datos basados en evidencia científica, la CNA podrá establecer una línea base y repetir este análisis de forma periódica para reducir y, en última instancia, terminar con toda conversión.

8
El último Informe Planeta Vivo de WWF reveló que las poblaciones de vida silvestre en América Latina y el Caribe han disminuido en un 94% desde 1970. Esta devastadora estadística subraya la importancia de invertir en el monitoreo de las tasas de conversión en la industria de cultivo de camarón de Ecuador, para garantizar que tanto la biodiversidad, como los ecosistemas naturales permanezcan intactos.
WWF busca identificar una línea base para sustentar futuros monitoreos y así asegurar la integridad ecológica de estos importantes ecosistemas. “Ojalá algún día cuando la gente pregunte cuál es el país con la producción de camarón más sostenible, señale a Ecuador como un ejemplo de buenas prácticas de producción de camarón”, agregó Tarsicio Granizo, Director WWF-Ecuador.
Es el momento adecuado para que Ecuador se comprometa a detener la deforestación y la conversión del hábitat en fincas camaroneras, manteniendo los beneficios de la captura de carbono que brindan los manglares de Ecuador y el liderazgo que tanto se necesita para crear una industria de producción de mariscos más sostenible.
El anuncio se realizó en el marco del Aqua Expo 2022 que se realizó del 17 al 20 de octubre en el Centro de Convenciones de Guayaquil. La presentación fue liderada por Aaron McNevin líder de la red global de Acuacultura WWF y José Antonio Camposano, Presidente Ejecutivo de la Cámara Nacional de Acuacultura•



“Es hora de un cambio en la forma en que producimos <commodities> como el camarón, de una manera más amigable con el medio ambiente, particularmente respetando los manglares y no contribuyendo a su degradación. Un gran sector de la industria del camarón ahora está comprometido en avanzar hacia una producción más sostenible y organizaciones como WWF están aquí para ayudar a que eso suceda”.
Tarsicio Granizo Director WWF-Ecuador
“El sector camaronero ecuatoriano se ha caracterizado por ser una industria cuidadosa del ambiente y protectora de los ecosistemas circundantes. Este convenio nos permitirá fortalecer aún más el compromiso de nuestra industria con la conservación de ecosistemas tan valiosos como los bosques de manglar, y servir de ejemplo para otras industrias en el Ecuador y el mundo”.

José Antonio Camposano
Presidente Ejecutivo de la Cámara Nacional de Acuacultura
9
Presentación de Acuerdo de cooperación para proteger los ecosistemas naturales entre WWF y CNA.
El camarón ecuatoriano conquistó París
Con el propósito de promocionar el camarón ecuatoriano en la ciudad europea, considerada un ícono mundial del arte, la moda y la gastronomía; la Embajada del Ecuador en Francia, junto con Pro Ecuador, El Presidente Ejecutivo de la Cámara Nacional de Acuacultura CNA, José Antonio Camposano, la Directora de Sustainable Shrimp Partnership SSP, Pamela Nath y una delegación de la Escuela de los Chefs, realizaron una demostración culinaria especializada en camarón en Maison De L’Alsace (Rooftop) de París, el pasado 8 de noviembre.

El evento contó con la presencia de importadores franceses, representantes de importantes supermercados de Francia como Intermarché y Leclerc, así como también Chefs de reconocida trayectoria y destacados medios de comunicación.
“Este evento fue una oportunidad para demostrar que la industria ecuatoriana no solo cumple con los más altos estándares de calidad, sino que está comprometida con las prácticas más exigentes en materia de sostenibilidad y cuidado de los ecosistemas en el mundo. Como SSP nos enorgullece ser parte de este tipo de actividades que permiten dar a conocer las bondades del mejor camarón ecuatoriano”. Pamela Nath, Directora de Sustainable Shrimp Partnership.
Durante el encuentro, se hizo la entrega de la Guía Máster del Camarón, que contiene una variedad de técnicas culinarias que permiten resaltar al máximo las características excepcionales que tiene el camarón ecuatoriano, y de esta forma compartir experiencias con expertos culinarios de todo el mundo.
El 10 de noviembre, se realizó un máster class en Le Cordon Blue de París, en el que los chefs ecuatorianos: Angelo Elizalde y Daniela Valverde compartieron varias recetas para la preparación del camarón ecuatoriano, como constan en la Guía Máster del Camarón que fue entregada a los medios de comunicación y estudiantes de gastronomía que se dieron cita en el encuentro.



La actividad se realizó como parte de la agenda de promoción del camarón ecuatoriano en Francia, con el objetivo de mostrar la calidad premium de nuestro producto destacado como el Mejor Camarón del Mundo•

- DICIEMBRE 2022 COYUNTURA 10
Máster class en Le Cordon Blue de París
Expertos de la Escuela de los Chefs, realizaron una demostración culinaria especializada en camarón en Maison De L’Alsace (Rooftop) de París.


PABELLÓN ECUADOR “FIRST CLASS SHRIMP” AUMENTÓ SU PRESENCIA EN FERIAS INTERNACIONALES

Luego de dos años de enfrentar la crisis mundial de COVID-19 se retomó paulatinamente la presencialidad en las Ferias internacionales especializadas en productos del mar a nivel mundial. El pabellón Ecuador “First Class Shrimp” estuvo integrado por establecimientos exportadores de camarón ecuatoriano, bajo la organización por la Cámara Nacional de Acuacultura CNA, entidad que por más de dos décadas impulsa la presencia del producto en importantes destinos en el mundo.
En el marco de la pandemia, la primera feria que se realizó de manera presencial fue CONXEMAR 2021, en la que se aplicaron rigurosos protocolos de protección ante el COVID-19. Luego en 2022 en las diferentes ferias internacionales se mantuvieron las medidas de control para seguir precautelando la seguridad de sus participantes y visitantes
El panorama cambió porque la gente se mostraba adaptada a la “nueva realidad”. El Pabellón Ecuador incrementó en área y número de expositores en las ferias tradicionales para el sector, como lo son
las ferias de Boston, Barcelona y Vigo; pero debido a la situación política de COVID-19 que aplicó China para los extranjeros, no se realizaron las ferias World Seafood Shanghai ni China Fisheries & Seafood Expo. Ante esto, la CNA buscó estar presente en ferias en Asia y confirmó su primera participación como pabellón en Seafood Expo Asia que se celebró en Singapur en septiembre pasado.
A continuación un repaso a la participación de Ecuador en ferias internacionales.

• Seafood Expo North America (Boston, USA)
En marzo 2022 participación de 15 empresas. Cofimar, Crimasa, Edpacif, Expalsa, Langosmar, Natluk, Nirsa, Omarsa, Procamaronex, Proexpo, Santa Priscila, Songa, SSP, Total Seafood y Winrep.

El crecimiento en comparación con Boston 2019, evidenció un incremento del 25% más de empresas y el 17% más de área de exposición.
• Seafood Expo Asia (Singapur, Singapur)
En septiembre 2022, la CNA participó con el primer pabellón colectivo de su historia en Singapur, dónde además, fue la primera vez que se celebró Seafood Expo Asia (antes celebrada en Hong Kong). El pabellón de la CNA, con su imagen Ecuador First Class Shrimp, contó con 144 m2 de exposición y tuvo la participación de 10 empresas: Edpacif, Excamecor, Expalsa, Expotuna, Frigolandia, Nirsa, Omarsa, Procamaronex, Songa y Total Seafood.
presencia con nuestros pabellones y llevar la imagen
• Seafood Expo Global (Barcelona, España)
En abril 2022, la feria de Barcelona representó un reto al ser el pabellón más grande organizado por la CNA. Contó con 23 expositores: Cofimar, Crimasa, Docapes, Edpacif, Empacreci, Expalsa, Exportquilsa, Expotuna, Frigolandia, GLuna Shrimp, Langosmar, Nirsa, Omarsa, PCC Congelados y Frescos, Procamaronex, Proexpo, Promarosa, Santa Priscila, Songa, Sopase, SSP, Total Seafood y Winrep
El área de exposición fue de 436 m2, convirtiéndose en el pabellón más grande que un producto de exportación no petrolera haya contado en una feria comercial.

En comparación con Bruselas 2019, hubo un crecimiento del 92% en participación empresarial ecuatoriana, en un área 74% más grande.
•CONXEMAR (Vigo, España)
En octubre se realizó la feria internacional Conxemar, donde se triplicó su área de pabellón (de 100m2 a 300m2 y se cuadruplicó el número de empresas expositoras de 4 a 16: Cofimar, Edpacif, Expalsa, Frigolandia, Grupo Almar, Langosmar, Natluk, Nirsa, Omarsa, Procamaronex, Proexpo, Promarosa, Songa, SSP, Total Seafood y Winrep.
Sin embargo, las ferias internacionales que no se celebraron fueron Shanghai International Fisheries and Seafood Exhibition (Shanghai, China) y China Fisheries & Seafood Expo (Qingdao, China).


Desafíos 2023

Desde el punto de vista de la organización del pabellón Ecuador, el desafío es seguir identificando las oportunidades para mejorar el servicio que otorga la CNA a sus miembros.
“Como CNA y país, seguir creciendo en
La CNA ha confirmado la participación en 4 ferias internacionales para el 2023
1. Seafood Expo North America (12 al 14 de marzo, en Boston – USA.)
2. Seafood Expo Global (25 al 27 de abril, en Barcelona – España)
3. Seafood Expo Asia (11 al 13 de septiembre, en Singapur – Singapur)
4. Conxemar (3 al 5 de octubre, en Vigo –España)
En lo que respecta a las ferias en China: la CNA está pendiente de la confirmación a las ferias: World Seafood Shanghai (Agosto 23 al 25) y China Fisheries & Seafood Expo (25 al 27 de octubre)•
“El crecimiento que hemos experimentado en Ferias Internacionales, tanto en número de empresas como en m2 de exposición y nuevos eventos, es el reflejo del crecimiento de la industria camaronera ecuatoriana y los esfuerzos que hace el sector exportador en la búsqueda de nuevos mercados para continuar exportando y que el camarón ecuatoriano – el mejor del mundo – siga llegando a los consumidores del mundo entero cada vez más. Para la CNA es un gusto poder brindar este servicio a sus miembros. Nos es grato que siga creciendo, sin olvidar el compromiso de trabajar día a día para lograr que el servicio otorgado y la experiencia de participar con nosotros sea cada vez mejor”.
María Fernanda Vilches Gerente de Ferias internacionales
 de Ecuador First Class Shrimp a todos los eventos en los que Ecuador ha participado tradicionalmente y todos los nuevos necesarios, que nos permitan llegar a nuevos mercados y más consumidores”.
de Ecuador First Class Shrimp a todos los eventos en los que Ecuador ha participado tradicionalmente y todos los nuevos necesarios, que nos permitan llegar a nuevos mercados y más consumidores”.
Sustainable Shrimp Partnership es ejemplo en la campaña de Resistencia Antimicrobiana
La iniciativa ecuatoriana Sustainable Shrimp Partnership (SSP) fue escogida como ejemplo para la elaboración de una campaña mundial de concientización del uso responsable de los antimicrobianos en la producción de proteína animal.

La resistencia antimicrobiana es uno de los principales problemas para la Organización Mundial de la Salud, organismo que ha advertido públicamente que es una de las principales amenazas que enfrenta la humanidad; en tal sentido la Organización de las Naciones Unidas para la Alimentación FAO y ReAct, una red internacional cuyo objetivo es abogar y estimular el compromiso global sobre la resistencia a los antibióticos mediante la colaboración con una amplia gama de organizaciones, personas y partes interesadas, están elaborando una campaña de concientización que aborda la importancia del uso responsable de los antimicrobianos.
En el caso del camarón, ReAct escogió a Sustainable Shrimp Partnership para mostrar cómo los productores que forman parte de esta iniciativa están comprometidos en proveer productos de máxima calidad, pero también seguros para sus consumidores. La selección por parte de la red global se registró porque SSP ha podido demostrar que sus miembros tienen una política de cero uso de antibióticos en el cultivo de camarón y se someten a verificaciones constantes en cada ciclo de producción, además de ser auditados periódicamente y de forma rigurosa, para demostrar su cumplimiento.

Nos cuenta Pamela Nath, Directora SSP en una breve entrevista para la Revista Aquacultura.
la historia que hay detrás de nuestro camarón.
Para empezar, la delegación conoció de cerca el sistema de producción del camarón en Ecuador. Cuando se recorren las fincas camaroneras, los visitantes pueden evidenciar las condiciones en las cuales se cultiva nuestro camarón, en ecosistemas naturales, lo más cercano a su hábitat natural, además del clima privilegiado.
Como segundo punto, entra el factor humano Aprender sobre el cuidado que proveen nuestros productores camaroneros da como resultado un producto de características premium. La implementación de las buenas prácticas para preservar el ecosistema, y el compromiso de hacer de esta industria cada vez más eficiente, teniendo siempre presente al consumidor, para que tenga a su alcance productos de calidad superior y seguros para su consumo.
¿Cómo ReACt va a mostrar lo que hace SSP sobre el control antimicrobiano?
Como parte de la campaña se realizarán una serie de documentales que serán publicados en las próximas semanas, con el objetivo de continuar generando conciencia mundial sobre la resistencia antimicrobiana, demostrando que hay industrias que abordan este tema de manera responsable.
ACERCA DE SSP
Sustainable Shrimp Partnership (SSP) representa a un grupo de empresas líderes que están comprometidas a transformar el futuro de la acuicultura del camarón. Pioneros en Ecuador, los miembros de la SSP están comprometidos en lograr y promover productos de la más alta calidad, producidos con los más altos estándares sociales y ambientales, a través de una mayor colaboración y transparencia•
Ellos pudieron experimentar
- DICIEMBRE 2022 COYUNTURA 14
¿Qué evidenció ReACt en su visita a fincas camaroneras de Ecuador?

RECIBIÓ A MÁS DE 10 MIL PERSONAS EN SU FERIA COMERCIAL Y CONGRESO DURANTE EL EVENTO MÁS GRANDE DE SU HISTORIA GUAYAQUIL
El evento técnico camaronero más importante del continente se realizó del 17 al 20 de octubre en el Centro de Convenciones de Guayaquil, fue organizado por la Cámara Nacional de Acuacultura, entidad que a través de sus redes sociales agradeció a sus asistentes por el éxito alcanzado este año.

El acto inaugural se realizó el 17 de octubre pasado en el salón Presidentes del Centro de Convenciones de Guayaquil y contó con la presencia de Julio José Prado, Ministro de Producción Comercio Exterior, Inversiones y Pesca; Susana González, Prefecta de la Provincia del Guayas; Carola Ríos, Directora General del Servicio Nacional de Aduana del Ecuador, SENAE; Carlos Miranda, Presidente del Directorio de la Cámara Nacional de Acuacultura y José Antonio Camposano, Presidente Ejecutivo de la Cámara Nacional de Acuacultura.



"La Cámara Nacional de Acuacultura ha trabajado arduamente por décadas para construir una plataforma para la difusión de conocimiento técnico e innovación en la cría de camarón, así como la feria comercial de mayor impacto en el continente. El mundo ha puesto la mirada en el Ecuador por ser un líder en innovación y sostenibilidad en la cría de camarón en cautiverio por más de 50 años”.
José Antonio Camposano
Presidente Ejecutivo Cámara Nacional de Acuacultura
16
2022
Durante la ceremonia se otorgó reconocimientos a tres líderes vinculados al sector acuícola que se han destacado por su aporte al gremio y trayectoria. Los condecorados fueron: Riccardo Carlo Delfini Mechelli, Attilio Eduardo Cástano Baquerizo y Francisco Pons Neumane.
La exposición comercial tuvo un área de alrededor de 7 mil metros cuadrados, donde se realizó el montaje de más de 200 stands. Empresas nacionales y extranjeras mostraron la innovación de la industria, a través de productos y servicios para todos los eslabones de la cadena acuícola. Alrededor de 15 mil personas visitaron la feria comercial.



Expositor proveniente de México
"Tuve la fortuna de asistir a Aqua Expo hace 17 años por primera vez y darme cuenta de que esta era la puerta para quien está dentro del sector acuícola. Es un no perdérselo. Este es un obligatorio para el que va a estar dentro de este sector".


Giselle de la Hoz Expositora proveniente de Panamá
"Esta es la tercera vez que visitamos Aqua Expo. Excelente. Tremenda ventana de oportunidades y también de alianzas".
Expositor proveniente de Asia

"Sabemos que la feria Aqua Expo es muy importante. Es una oportunidad para conocer y para comunicar con las empresas de acá y entonces, creo que, en el futuro, vamos a tener un beneficio muy bueno".

- DICIEMBRE 2022 COYUNTURA 17
Julio Castañeda
Alberto Huang
Riccardo Carlo Delfini Mechelli Condecorado Aqua Expo 2022
Attilio Eduardo Cástano Baquerizo Condecorado Aqua Expo 2022
Francisco Pons Neumane Condecorado Aqua Expo 2022
Flores Expositor
"Esta es una feria excepcional, muy grande, muy profesional, muy bien diseñada, muy bien programada".
"Hemos logrado establecer más de una decena de citas de negocios".
"No habíamos tenido la oportunidad de compartir con la industria por casi tres años a raíz de la pandemia y ha sido todo un gusto ver el interés, la presencia, la respuesta de toda la industria de la acuacultura en venir, participar, exponer y visitarnos durante estos días de la feria".
 Jorge Pérez-Bouzada Expositor
Jorge Pérez-Bouzada Expositor
"Para nosotros esta es una oportunidad fantástica de estar con el sector, de poder ver a nuestros clientes actuales; futuros clientes, potenciales clientes, tener toda la oportunidad de ver al sector aquí congregado, tecnologías, ver competidores también, ver cómo se mueve la industria. O sea que es, no solo una buena vitrina, sino la mejor vitrina posible".

Por otra parte, el congreso Aqua Expo 2022 contó con un programa técnico que se desarrolló en dos salas de forma simultánea, abordando temas de salud animal, nutrición y manejo de la alimentación, calidad e inocuidad, procesos eficientes de producción, uso de nuevas tecnologías y proyecciones del mercado del camarón. Más de 60 conferencistas nacionales y extranjeros participaron en exposiciones y paneles•



 Lexi Vera Expositora
Lexi Vera Expositora
"Nosotros hemos contado con la visita de productores muy importantes. Definitivamente es una gran oportunidad para seguir afianzándonos dentro de esta industria y seguir contribuyendo".
"Estoy muy impresionado por la innovación tecnológica, por la calidad de la presentación de los stands, de las conferencias, de la cordialidad con la que hemos sido recibidos. Así que, realmente me voy más que satisfecho. Ustedes dicen que es el encuentro camaronero más importante del continente y yo, que viajo bastante, diría que a nivel mundial son los primeros".

- DICIEMBRE 2022 COYUNTURA 18
Fernando
Bryan Wilhelm Expositor
Claudio Paredes Expositor Proveniente de EE. UU.
Carlos Beltrán Conferencista



20
ALEJANDRO AGUAYO
Presidente Fundador de la Cámara Nacional de Acuacultura (1994 – 1995) y mentalizador de la Revista Aquacultura



“En aquella época, el sector camaronero tuvo que enfrentar muchos problemas, entre ellos: el Síndrome de las Gaviotas, el Síndrome de Taura, entre otras dificultades en temas de seguridad. Aparecían brujos y shamanes con soluciones muy creativas y nada eficientes, por lo que la revista tenía la misión de informar oficialmente los problemas, su magnitud y avances científicos buscando solución. Teníamos en el directorio, muchos empresarios, como Juan Xavier Cordovez, Attilio Cástano, Rodrigo Laniado y muchos otros que trabajaron con seriedad contratando estudios con la Universidad de Auburn, la Universidad de Arizona, y otros científicos, finalmente encontramos los camarones que genéticamente eran resistentes a la Mancha Blanca, y como teníamos que hacer esa selección genética, nació la idea del ‘programa genético’, que es una de las bases de nuestro vigoroso crecimiento como sector”.
Por su parte, Nancy Cely, quien fue designada la primera editora de la Revista Aquacultura nos contó cómo inició este medio de comunicación conocido como “La voz oficial del sector”.
Directora Ejecutiva de la Cámara Nacional de Acuacultura y primera editora de la Revista Acuacultura del Ecuador 1994 - 1999

"Fue un honor trabajar con Alejandro Aguayo y un equipo heredado de previas asociaciones del sector que desaparecieron al integrarse a la CNA (Fedecam, Cámara de Productores y Asociación de Laboratorios).
Muchos eran los problemas que enfrentaba el sector y existían serias dificultades tanto para una comunicación rápida como para informar de los avances que se iban dando en el área técnica, en afectaciones a la producción local, en cambios tarifarios o técnicos en los mercados internacionales, así como también en legislación nacional o internacional que podía afectar al sector. Esto llevó a que Alejandro proponga que elaboremos una publicación que llegue y se quede más tiempo con el afiliado, como lo hacían otras Cámaras.
Reuniéndome con personas que podían aportar, una de ellas Hernán Dupré que tenía experiencia en publicaciones institucionales, asi como Rodolfo Barniol, líder en investigación a esa fecha, vislumbramos una Revista completa, periódica, que pueda, incluso, generar ingresos importantes para la Cámara".
Cely explica que fue todo un desafío resolver los detalles técnicos de imagen: tipo de papel, diseño de la portada y presentación de contenido, así como el número de ejemplares, costo de impresión y distribución.
NANCY CELY HERNÁN DUPRÉ
Primer prensista de la Revista Acuacultura del Ecuador
“La producción de la revista en esa época era dura, los procesos eran lentos, no había internet solo fax, era lo más rápido para comunicarse, cuando apareció la computación la cosa cambió, hoy en día se puede hacer una revista de 64 páginas en ocho días con publicidad y artículos a todo color.
Los apuros más grandes lo tuvimos en la época que se tomó la decisión de llevar la revista a las ferias Internacionales y debía tener dos idiomas, fue una tarea ardua. Nancy Cely traducía los textos comerciales y se contrató un traductor especializado para artículos ténicos. A nivel gráfico y de imprenta le dimos forma rápidamente a la revista, mejorando en cada edición”.
21
Incialmente la editora Nancy Cely propuso que la revista tenga contenido con temas de actualidad que afectaban al sector y mitad con publicaciones científicas que aporten al sector. “Finalmente, coincidimos en lanzar una primera edición de una revista que surja con nivel internacional. Ese momento nació la Revista de la Cámara en formato completo: Para su producción dividimos el contenido. Una primera parte, a mi cargo, con el articulo central sobre el tema más importante para el sector a esa fecha, noticias institucionales,
legislación relevante, estadísticas de comercio exterior, evolución del sector en todos los frentes, artículos de prospectiva, y, una segunda parte a continuación, con artículos seleccionados por un Comité Técnico que presidía el Dr. Rodolfo Barniol, brillante investigador nacional", expresó Cely.

Con el apoyo técnico de Rodolfo Barniol Zerega, se publicaban los artículos científicos y que a su vez eran supervisados por el Dr. Roberto Jiménez, además el Comité de
RODOLFO BARNIOL
Primer editor técnico de la revista
Cultura del Directorio aportaba con artículos de biólogos reconocidos y publicidades de los propios miembros del directorio. Rodolfo Barniol recuerda que tomaron como ejemplo la elaboración de una revista técnica que contenía los aportes del primer congreso de acuicultura realizado por la Subsecretaría de Pesca y la Asociación de Cultivadores de Especies Bioacuáticas (ACEBA) en la década del 80, y que continuó con la revista de la Cámara de Productores Camaroneros CPC.
“Mi aporte científico lo realicé con la colaboración de valiosísimos profesionales que me acompañaron y actualemente me acompañan en la labor de investigación. Decidimos participar en conjunto en foros y aportamos con varios papers y muchas ponencias en la WAS. Era información recogida de una muy productiva comunidad técnica y científica de camarón en Ecuador y alrededor del mundo. Igualmente se aplicó una simbiosis de lo técnico con lo comercial que permitió llegar al biólogo y empresario de campo. Identificados los problemas se buscaba la etiología y se avanzaba en el manejo, para muestra: el Síndrome de las Gaviotas, el Síndrome de Taura, enteritis bacteriana, infecciones de bacterias intracelulares, bacterias luminiscentes, gregarinas, entre otros.
Era una evolución del pensamiento de la industria que discutía si la larva natural de “cogollos” de esteros era superior a la pescada en playa abierta. Luego con el advenimiento de los laboratorios, si el nauplio de hembras grávidas y fecundadas en el medio natural era mejor que el nauplio de maduración y este a su vez mejor de los obtenidos con inseminación artificial. Luego si los reproductores libre de patógenos (SPF) importados eran mejores… Hoy nadie duda que el ciclo cerrado de reproductores adaptados a los lugares de cría y madurados en cautiverio, con criterios de selección (incluida la genética) son el camino para un presente sustentable y un futuro muy promisorio”.
Falta de recursos
Nancy Cely recuerda que el mayor limitante era la falta de recursos económicos. “Nos convertimos en diseñadores y vendedores de espacios publicitarios en los primeros meses. Estaré siempre agradecida por la colaboración que ofrecieron varios exportadores que tenían fotos de alta resolución, varias muy hermosas y significativas para el sector, las que se fueron utilizando como portadas en las ediciones iniciales. Sin embargo, la portada para la primera revista sí queríamos que fuera especial y única, por lo que se escogió el logo (tipo escudo) que se había creado para la nueva Cámara y se convirtió en una edición histórica”, explicó.
Primera edición

Cely indicó que la primera revista fue un gran éxito y las siguientes se esperaban con gran expectativa. “Con humildad, me atrevo a decir que impulsó tanto la investigación científica como la investigación aplicada, por parte del personal especializado que trabajaba directamente en los laboratorios, en las piscinas y en las empacadoras, en la confianza de que los resultados presentados --luego de
la revisión y aceptación del Comité-- tenían la posibilidad sea de aplicación inmediata. Por otro lado, se convirtió en el medio de difusión de los temas de importancia inmediata para el sector: regulaciones de los diferentes Ministerios, niveles de exportación, información de mercado, regulaciones sanitarias en mercados de destino, análisis de los principales problemas que afectaban al sector a esa fecha e incluso la promoción de actividades dentro y fuera del país para la apertura de nuevos mercados se hicieron incluso ediciones bilingües para las ferias".
El contar con un medio impreso, llenó de información actualizada y de valor, lograba que muchos camaroneros conozcan las gestiones que se estaban realizando a su nombre, los logros, los problemas, las actividades gremiales: ferias, seminarios, conferencias. Esto contribuía a la participación cada vez mayor en actividades de capacitación, participación en congresos nacionales y en el exterior, así como la presencia conjunta en las principales ferias del mundo, entre las que destaco las Ferias en China, un gran desafío inicial.
Sin embargo, durante la época más difícil de la Acuacultura: La Mancha Blanca, el sector sufrió grandes pérdidas y la revista también debió bajar su tiraje, pero luego como se dio cuenta que era la revista la que las mejores recomendaciones técnicas, se amplió rápidamente el tiraje llegando a más lugares, recuerda el Dr. Leonardo Maridueña, Director Ejecutivo CNA 2000 - 2004.
Internacionalización
“Se comenzó a vender en México, Panamá y Estados Unidos; y por ende llegó publicidad desde esos países promocionando sus productos. Es de destacar el esfuerzo que hacían todos los directores y ejecutivos de esa época cuando había ferias Internacionales cada persona que viajaba tenía que llevar un paquete de Revista de 20 unidades así no se gastaba en envío comercial, yo debía dejar en domicilios, en el aeropuerto dos horas antes del viaje, en las madrugadas muchas veces repartir en las maletas de mano de manera que llegara a las ferias”, precisó Dupré.
“Una lectura continua de la Revista, desde sus inicios hasta el día de hoy, refleja en
22
alto grado la evolución que fue dándose en el sector: de una actividad relativamente pequeña pero con un alto grado de integración, logró ir posicionándose como el sector ecuatoriano con un futuro cada vez más prometedor, capaz de superar etapas muy duras en la producción, cambios en el acceso a mercados internacionales, problemas con cambios de legislación nacional, adaptación a nuevas regulaciones sanitarias para exportar, desarrollo de métodos de producción únicos, consolidación de una calidad reconocida, evolución cada
vez mayor de dietas alimenticias con menor impacto ambiental, y lograr el reconocimiento nacional como el primer rubro de ingresos por exportaciones del país y uno de los principales proveedores de camarón de calidad y cantidad en el mundo”. Expresó Cely.
Para la primera editora de la Revista “Aquacultura del Ecuador” ahora conocida como “Revista Aquacultura” este medio de comunicación cuenta la historia del desarrollo de la industria acuícola en Ecuador. “Si yo
LAURENCE MASSAUT
Editora que logró indexar la revista
tuviese que destacar una única cualidad de su publicación, sería la de haber acercado y unificado a los involucrados en el sector al actuar como medio de comunicación y unión. En lo personal, aún hoy, cada avance del sector lo siento y lo celebro pensando en todos aquellos que iniciaron esta actividad, los que la consolidaron y los que han tomado la posta".
Durante su trayectoria la Revista Aquacultura tuvo varios editores una de ellas fue Laurence Massaut quien comparte sus principales logros:
"Mi primera labor como Editora fue gestionar ante la Secretaría Nacional de Educación Superior, Ciencia, Tecnología e Innovación (SENESCYT), la asignación del código ISSN (Número Internacional Normalizado de Publicaciones Seriadas) proporcionando así la identificación internacional de la revista. Desde la edición #85 (abril-mayo del 2011) la revista se identifica con el código ISSN 1390-6372 y se la conoce oficialmente como revista “Aqua Cultura: La voz oficial del sector”. La obtención de ese número refleja el impulso que el Comité Editorial quiso dar a la revista, durante mi paso como Editora. Desde varios programas de trabajo en la CNA, se incrementó la generación de información técnica sobre el sector que representamos, dándole mayor formalidad a estas publicaciones y acentuando el aporte de la industria camaronera a la economía del país. Además, se aumentó la inclusión de artículos científicos con información relevante para todos los actores de la cadena de producción y se firmó un Convenio de colaboración con Urner Barry Publications, Inc., ampliando así la sección de “Estadísticas y Mercados”.
Nueva imagen y nuevas secciones

28 años después la Revista Aquacultura tiene nueva imagen, posee secciones de coyuntura, reportaje en territorio y los artículos técnicos divididos en: patología, salud animal, nutrición, producción, manejo, genética, tecnología y ambiente. Su tiraje promedio es de 3 mil ejemplares impresos. También se distribuye de manera virtual a sus suscriptores y los no suscriptores pueden visualizarla de manera gratuita en cna-ecuador.com/revista.
Su editora actual es Shirley Suasnavas, quien desde hace más de 5 años asumió esa función y reinstauró el Comité Técnico liderado por el Presidente Ejecutivo, José Antonio Camposano y sus directores: Leonardo Maridueña, Yahira Piedrahita y Luis Robles. La conceptualización gráfica está a cargo de Orly Saltos y cuenta con el soporte en diseño de Roberto Peñafiel.


En esta edición 150 es preciso concluir este espacio agradeciendo el aporte de todos los editores, diseñadores,
vendedores y empresarios que han impulsado el crecimiento de este medio de comunicación que sigue sirviendo al sector acuícola ecuatoriano y su contenido tiene trascendencia internacional y credibilidad•

“La Revista Aquacultura es una importante herramienta informativa, que no solo permite a todos los técnicos de la cadena del camarón mantenerse al día con los avances científicos sino también compartir sus investigaciones y aportar al intercambio de conocimientos del sector acuícola".
Shirley Suasnavas
Editora actual
23
Roberto Peñafiel, Orly Saltos y Shirley Suasnavas en reunión de producción de la Revista Aquacultura.


ARTÍCULOS TÉCNICOS ÍNDICE
Edición 150 - Diciembre 2022 27 38 45 56 62 67 72 78
Respuestas tempranas en Penaeus vannamei durante una infección experimental con esporas de Enterocytozoon hepatopenaei (EHP) por inyección y vía oral
Biotecnología para el control de patologías de origen bacteriano en los cultivos de camarón. Estudio de caso de utilización de bacteriófagos líticos endémicos contra Vibrio parahaemolyticus
Dando sentido a la taxonomía de los camarones de mayor importancia comercial Penaeus Fabricius, 1798 s. l. (Crustacea: Decapoda: Penaeidae), un camino a seguir
Proliferación de dinoflagelados en camaroneras, alternativas de control
Capacidad de carga de las piscinas camaroneras
Eficiencia del uso de salvado vegetal en sistemas de fertilización simbiótico sobre la calidad del agua y la composición del zooplancton en la fase de cría de Litopenaeus vannamei
Mejores prácticas tecnológicas en transformación digital: automatización de procesos contables y financieros en las empresas ecuatorianas
TECNOLOGÍA PORTÁTIL
NO INTRUSIVA para el control de seguridad a la carga y el contenedor
Respuestas tempranas en Penaeus vannamei durante una infección experimental con esporas de Enterocytozoon hepatopenaei (EHP) por inyección y vía oral
Autores:
Palaniappan Subasha
Arumugam Umaa, b, * Baboonsundaram Ahilana
a Departamento de Gestión Sanitaria de Animales Acuáticos, Dr. M.G.R. Escuela Superior de Pesca e Instituto de Investigación, Universidad de Pesca Tamil Nadu Dr. J. Jayalalithaa, Ponneri 601204, Tamil Nadu, India bLaboratorio Estatal de Referencia para la Salud de Animales Acuáticos, Universidad de Pesca Tamil Nadu Dr. J. Jayalalithaa, Madhavaram Campus, Madhavaram milk colony 600051, Chennai, Tamil Nadu, India
uma@tnfu.ac.in www.elsevier.com/locate/jip https://doi.org/10.1016/j.jip.2022.107740
Penaeus vannamei es el crustáceo más ampliamente cultivado y contribuye con alrededor del 50.3% de la producción total de crustáceos (9,862 tm) y 6% de la producción total acuícola mundial de 82,095 tm. La intensificación de las prácticas de cultivo de P. vannamei para hacer frente a la creciente demanda de camarón ha hecho camino a varias enfermedades causadas por diversos patógenos, como virus, bacterias, hongos y parásitos que han tenido un impacto negativo en el cultivo y la producción de P. vannamei en EE. UU., China, India y muchos países asiáticos (Subasinghe, 2017).

Enterocytozoon hepatopenaei (EHP), es un microsporidio fúngico que causa microsporidiosis hepatopancreática en P. vannamei, provocando un retraso del crecimiento y graves pérdidas de producción en la acuicultura (Tourtip et al., 2009; Ha et al., 2010; Flegel, 2012; Tangprasittipap et al., 2013; Liu et al., 2015; Tang et al., 2016; Rajendran et al., 2016; Giridharan y Uma, 2017).
Se sabe que EHP infecta el hepatopáncreas del camarón, que sirve como la principal glándula digestiva (glándula del intestino medio) que secreta enzimas digestivas, absorbe los productos digeridos y mantiene las reservas minerales (Díaz et al., 2010). Por lo tanto, la infección por EHP afecta las funciones digestivas y de absorción, lo que da como resultado un crecimiento deficiente y un deterioro de la
- DICIEMBRE 2022 27
inmunidad (Otta et al., 2016). Sin embargo, la disponibilidad de data sobre la respuesta inmune a la infección por EHP en P. vannamei es escasa.
El mecanismo de defensa no específico o innato que desempeña un papel importante en la protección del camarón contra la infección incluye el recuento total de hemocitos (THC), la actividad de profenoloxidasa (proPO), la actividad de explosión respiratoria (RBA), la actividad de superóxido dismutasa (SOD), catalasa, fagocitosis, aglutinación, melanización, formación de nódulos, péptidos antimicrobianos, glutationes, actividades de lisozima, etc (Johansson and Soder-hall, 1989; Warner,1994; Fridovich, 1998; Broderick et al., 2009; Coates and Söderhäll, 2021). Todos estos parámetros inmunológicos no específicos se basan en patrones moleculares asociados a patógenos (PAMPs) que son detectados por los PRRs (receptores de reconocimiento de patrones) de camarón. Los receptores Toll han sido reconocidos como los principales PRRs que desempeñan un papel esencial en el reconocimiento de microbios y en la provocación de respuestas inmunitarias no específicas durante la defensa del huésped (Akira et al., 2001; Beutler, 2004; Uma et al., 2012; Dechamma et al., 2015). En el camarón, se identificó que el gen del receptor Toll desempeña un papel en el desencadenamiento de la inmunidad innata contra moléculas extrañas (Yang et al., 2008). Sucesivamente, el papel del gen Toll en el camarón se ha estudiado ampliamente durante la infección con patógenos importantes como el virus del síndrome de la mancha blanca (WSSV) (Deepika et al., 2014), Vibrio harveyi (Dechamma et al., 2015), enfermedad de necrosis hepatopancreática aguda (AHPND) (Boonchuen et al., 2021) e incluso el recién surgido virus iridiscente de hemocitos de camarón (SHIV) (Liu et al., 2021). Sin embargo, la expresión de genes Toll durante la infección por EHP en camarón no ha sido reportada hasta el momento.
La infección experimental en P. vannamei sanos con EHP ha sido demostrada por varios investigadores luego de la cohabitación con camarones infectados con EHP (Tang et al., 2016); alimentación oral de hepatopáncreas infectados con EHP (Santhoshkumar et al., 2016); inmersión de PL sanas en un homogeneizado de tejido animal infectado
Tabla 1.- Tejidos seleccionados para la detección de enfermedades de la lista de la OIE en muestras de camarón recolectadas.
No. Enfermedad
Enterocytozoon hepatopenaei (EHP)
Enfermedad de necrosis hepatopancreática aguda (AHPND)
Virus de la Cabeza Amarilla (YHV)
Virus de la necrosis hipodérmica y hematopoyética infecciosa (IHHNV)
Virus de la mionecrosis infecciosa (IMNV)
Hepatopancreatitis necrosante (NHP)
Virus del síndrome de Taura (TSV)
Virus del síndrome de la Mancha Blanca (WSSV)
con EHP (Karthikeyan y Sudhkaran, 2019); inyección de un homogeneizado de tejido infectado con EHP directamente en el lóbulo dorsal de HP y sonda inversa a través de la abertura anal del camarón (Mai et al., 2020); alimentación oral con hilos fecales infectados con EHP (Aranguren Caro et al., 2021); alimentación oral con poliquetos infectados con EHP (Krishnan et al., 2021) y alimentación con esporas de EHP purificadas (Munkongwongsiri et al., 2021). Las respuestas del huésped en P. vannamei a la infección por EHP durante el ensayo experimental con EHP se han documentado en base a cambios bioquímicos como la actividad de AST, ALT y AP (Santhoshkumar et al., 2016) y la expresión de varios genes inmunitarios como genes de profenoloxidasa, superóxido dismutasa y “crustin” en P. vannamei (Karthikeyan y Sudhakaran, 2019). Como hay poca información disponible sobre las respuestas del huésped a la infección por EHP, en este estudio, las respuestas inmunitarias del huésped en P. vannamei durante la infección experimental con EHP, se estudiaron en función de ensayos inmunológicos y la expresión del gen Toll.
Materiales y métodos
Muestras de P. vannamei
Se recolectaron P. vannamei (91 g) con signos clínicos de infección por EHP, es decir, crecimiento retardado, variación de tamaño, heces blancas y síndrome de caparazón suelto, de una camaronera en
Hepatopáncreas
Tejidos asociados al intestino (hepatopáncreas e intestino)
Órgano Linfoide, Intestino Branquias Músculos Hepatopáncreas
Músculos, branquias, órgano linfoide
Tejidos seleccionados Resultados PCR 1. 2. 3. 4. 5. 6. 7. 8.
Branquias, Pereiópodos
Positivo Negativo Negativo Negativo Negativo Negativo Negativo Negativo
el distrito de Tiruvallur (13°21′36.0′′N, 80°17′06.0′′E), Tamil Nadu, sur de India y se transportaron vivos al laboratorio en bolsas de plástico aireadas. También se recolectaron P. vannamei saludables (10 1 g) de una camaronera en el distrito de Tiruvallur, sur de la India (13°19′19.2′′N, 80°13′51.6′′E) y se transportaron al laboratorio para el estudio experimental. Al llegar al laboratorio, los camarones fueron anestesiados sumergiéndolos en agua helada, los tejidos clave fueron conservados asépticamente para la detección de EHP y otras enfermedades del camarón enlistados en la OIE (Tabla 1) (OIE, 2016). Los hepatopáncreas de camarones infectados con EHP fueron recolectados y procesados para el aislamiento de esporas de EHP que se utilizaron para la infección experimental.
Extracción de ácido nucleico
Los tejidos clave se homogeneizaron individualmente en tampón NTE (0.02 M EDTA, 0.2 M NaCl y 0.02 M Tris-HCl, pH 7.4) y se preparó una suspensión de 10% de tejido homogeneizado en tubos de centrífuga de 1.5 mL. Luego, la suspensión se centrifugó a 3000 g durante 15 min a 4 °C y el sobrenadante se recogió en un tubo separado. Luego, el sobrenadante se mezcló con un volumen igual de tampón de digestión (100 mM NaCl, 50 mM EDTA, pH 8.0, 10 mM Tris-HCl, pH 8.0, dodecilsulfato de sodio al 5% y 0.1 mg mL—1 de proteinasa K) y se
- DICIEMBRE 2022 28
PATOLOGÍA
incubaron a 65 °C durante 2 h. Luego, se desproteinizó el tejido digestivo mediante extracción sucesiva con fenol/cloroformo/ alcohol isoamílico y el ADN se recuperó mediante precipitación con etanol, se secó, se suspendió en agua libre de nucleasas y se usó como molde para el ensayo de PCR. La pureza (A 260/280 ~ 1.8) y la cantidad (10 ng) de ADN se determinó utilizando Nanodrop Onec (Thermo Fisher).
El ARN total se extrajo con un kit comercial (NucleoSpin RNA Plus, Takara Bio Inc.) para la detección de ARN de virus de la lista de la OIE y para el estudio de la expresión del gen Toll. Se colectó tejido hepatopancreático de camarones infectados con EHP y de camarones control sanos a las 0, 6, 12, 24, 36, 48, 60 y 72 hpi para la extracción de ARN. La cuantificación del ARN se realizó mediante Nanodrop onec (Thermo Fisher Scientific, EE. UU.). Aproximadamente 2 µg de ARN total de las muestras se transcribieron por separado usando Revert Aid First Strand cDNA Synthesis Kit (Thermo Fisher Scientific, EE. UU.).
Purificación de esporas de EHP del tejido hepatopancreático
La purificación y concentración de esporas microsporidianas del hepatopáncreas de camarones infectados con EHP se realizó mediante el método de centrifugación gradiente de densidades siguiendo el protocolo descrito por Aldama-Cano et al., (2018), suspendidas en solución salina tampón fosfato (137 mM NaCl, 2.7 mM KCl, 10 mM Na2HPO4, 1.8 mM KH2PO4, pH 7.4) y almacenado a temperatura ambiente como stock inicial. La concentración de las esporas se determinó mediante hemocitómetro y se ajustó a un stock de trabajo de ~ 1 108 esporas/ml. La viabilidad de las esporas purificadas se determinó mediante un ensayo de extrusión en tubo polar (AldamaCano et al., 2018). Brevemente, se incubaron 2 µL de suspensión de esporas con 10 µL de PhloXine B solución al 2% (p/v) y 10 µL de carboximetilcelulosa sódica (0.1% p/v en agua destilada estéril) en un portaobjetos de microscopio durante 10 min a temperatura ambiente (25 °C). Las esporas se observaron en un microscopio óptico (Olympus) en tres réplicas para contar las esporas extruidas. La extrusión media (%) se obtuvo contando el número de esporas extruidas en un total de 100 esporas. Se seleccionaron para el estudio los lotes de esporas que tenían >
70% de esporas viables antes del uso para la infección experimental.
PCR anidada para EHP
La amplificación por PCR de EHP se llevó a cabo siguiendo el protocolo de Jaroenlak et al. (2016). El primer paso de la amplificación por PCR se llevó a cabo utilizando los primers SWP_1F y SWP_1R con una desnaturalización inicial a 95 °C durante 5 min seguido de 30 ciclos de desnaturalización a 95 °C durante 30 s, hibridación a 58 °C durante 30 s, extensión a 68 °C durante 45 s y extensión final a 68 °C durante 5 min. La PCR anidada se llevó a cabo con los productos de la PCR del primer paso (1 μL) utilizando los primers SWP_2F y SWP_2R con una desnaturalización inicial a 95°C durante 5 min seguida de 20 ciclos de desnaturalización a 95 °C durante 30 s, hibridación a 64 °C durante 30 s y extensión a 68 °C durante 20 s y una extensión final a 68 °C durante 5 min. Los productos amplificados por PCR fueron obtenidos por electroforesis en gel de agarosa en un gel de agarosa al 1.5%. Aproximadamente 10 μL de los productos de la PCR amplificados se cargaron en un gel de agarosa al 1.5% junto con un marcador de peso molecular de 100 pb (New England Biolabs, EE. UU.). Los productos fueron sometidos a electroforesis a 120 V durante 30 min en una unidad de electroforesis en gel (BioRad, EE. UU.), visualizados y documentados en un sistema de documentación de gel UV (BioRad, EE. UU.) para bandas de PCR amplificadas a 514 pb (primer paso) y 148 pb (paso anidado).
Estudio de infección experimental Los P. vannamei saludables se mantuvieron y aclimataron durante dos semanas en las instalaciones del laboratorio húmedo del Laboratorio Estatal de Referencia para la Salud de Animales Acuáticos, Universidad de Pesca Tamil Nadu Dr. J. Jayalalithaa con aireación y alimentación adecuada (alimentos CP).
Tres grupos, llamados HPI (alimentados con tejido hepatopancreático infectado con EHP), SPI (inyectados con esporas de EHP purificadas), Control (camarones control alimentados con hepatopáncreas no infectados/inyectados con PBS) que consistían de 40 camarones cada uno, se mantuvieron en acuarios de plástico (45- L) por triplicado. Al comienzo de los experimentos, para la alimentación oral en
el grupo HPI, cada camarón se alimentó con tejido hepatopancreático infectado con EHP (~1 105 esporas/g) a razón del 10% del peso corporal fresco. Para la infección experimental por inyección en el grupo SPI, a cada camarón se le inyectó 1 µL de suspensión de esporas de EHP (~1 105 esporas) diluido en PBS (50 µL) directamente en el seno ventral del cefalotórax con una jeringa de 1 mL (aguja de calibre 25). Al grupo control se le inyectó un volumen igual de PBS (50 µL) o se lo alimentó con hepatopáncreas no infectado (1 g/camarón). Los camarones en todos los grupos fueron mantenidos y alimentados con alimento comercial (alimentos CP).
Se seleccionaron al azar alrededor de cinco camarones de las tres réplicas del grupo HPI, SPI y Control para la recolección de muestras de hemolinfa y hepatopáncreas a las 0, 6, 12, 24, 36, 48, 60 y 72 hpi para el análisis de parámetros inmunológicos y tasa de infección de EHP.
Se recolectó hemolinfa del seno ventral del cefalotórax usando una jeringa de 2 mL con aguja calibre 26 que contenía 100 µL de solución anticoagulante (100 mM glucosa, 30 mM citrato trisódico, 26 mM ácido cítrico, 510 mM NaCl y 10 mM EDTA. Na2: pH 7.3) (Vargas-Albores et al., 1993). El hepatopáncreas de todos los grupos se diseccionó asépticamente y se fijó en etanol al 90% para PCR y en Trizol (Invitrogen, EE. UU.) para evaluar la expresión del gen Toll.
Respuestas inmunes en P. vannamei infectados experimentalmente con EHP Recuento total de hemocitos (THC)
Se tomó una muestra de hemolinfa (100 μl) en un tubo de microcentrífuga, fijada en un volumen igual de fijador de hemolinfa (formalina al 10% en 0.45 M NaCl) y se dejó reposar durante 10 min. Aproximadamente 20 μL de la suspensión fija de hemocitos se transfirieron a un nuevo tubo de microcentrífuga que contenía el mismo volumen de solución de Rosa de Bengala (1.2% de Rosa de Bengala en 50% de etanol) para la tinción de hemocitos y se incubó a temperatura ambiente durante 20 min. Los hemocitos totales se contaron en 5/25 cuadrados en una cámara Neubauer mejorada (Vol de cuadrados = 0.2 × 0.2 × 0.1 mm3) por triplicado (Ananda Raja et al., 2012).
- DICIEMBRE 2022 29 PATOLOGÍA
Actividad de profenoloxidasa (proPO)
La actividad proPO se midió espectrofotométricamente (por triplicado) registrando la formación de dopacromo a partir de L-dihidroX- yfenilalanina (L-DOPA) (Gollas-Galván et al., 1999). La suspensión celular (100 μL) se preincubó con 50 μL de laminarin (1 mg/ml en tampón cacodilato) o solo con tampón cacodilato en el caso de los controles, durante 1 h a 20 °C antes de agregar 50 μL L -DOPA (3 mg/mL en tampón cacodilato). Después de la incubación, se añadieron 800 μL de tampón de cacodilato y se dejó que la reacción prosiguiera durante 10 min a 20 °C seguido de la medición de la absorbancia a 490 nm en un lector ELISA (BioTek, EE. UU.)
Actividad de explosión respiratoria (RBA)
La actividad de estallido respiratorio se evaluó siguiendo los métodos de Anderson y Siwiki (1995). Se incubaron aproximadamente 100 μL de muestra de hemolinfa con un volumen igual de solución de NBT al 0.2% durante 30 min a temperatura ambiente. Se añadieron aproximadamente 50 μL de suspensión de hemolinfa NBT con N, N-dimetilformamida (DMF) (1 mL) y se centrifugó (Eppendorf 5810R) a 5000 rpm durante 5 min. Se separó el sobrenadante y se midió la absorbancia a 540 nm.
Actividad de superóxido dismutasa (SOD)
Para la evaluación de la actividad SOD (Campa-Córdova et al., 2002), se diluyeron aproximadamente 40 μL de la muestra de hemolinfa con 10 volúmenes de solución tampón fosfato salino (PBS) y se centrifugaron (Eppendorf 5810R) a 6000 g, 4 °C durante 7 min. Luego, el sobrenadante se calentó a 65 °C durante 5 min en un baño de agua para obtener el extracto crudo de SOD. Se agregaron aproximadamente 150 μL de extracto crudo de SOD con 50 μL de reactivo Nitro blue tetrazolium (NBT) y se incubó durante 2 min. La densidad óptica se midió a 630 nm utilizando un lector ELISA (BioTek, EE. UU.).
Actividad de catalasa
Para la evaluación de la actividad de la catalasa (Takahara et al., 1960), se mezclaron aproximadamente 2.5 ml de tampón fosfato y 0.5 μl de hemolinfa y se inició la reacción enzimática mediante la adición de 1.0 mL de solución de peróxido de hidrógeno. Los cambios en la absorbancia
Primers de genes Toll Secuencia (5′ a 3′)
se monitorearon a 240 nm cada 30 s hasta 3 min para evaluar la actividad enzimática.
Actividad de lisozima
La actividad de la lisozima se analizó siguiendo el método descrito por Ellis (1990). Aproximadamente 100 μL de hemolinfa se complementaron con Micrococcus lysodeikticus (Sigma) suspendido (0.15 mg/ mL) en 0.02 M de tampón fosfato de sodio a temperatura ambiente. La absorbancia de la muestra se midió entre 0.5 y 4.5 min con un espectrofotómetro (590 nm). Se calculó una unidad de actividad de lisozima como la cantidad de hemolinfa que produce una disminución en la absorbancia de 0.001 min—1
Transcripción inversa cuantitativa- PCR (qRT-PCR)
La expresión del gen Toll se evaluó siguiendo los primers y protocolos de Dechamma et al. (2015) (Cuadro 2). La qRT-PCR se realizó en un equipo Bio-Rad CFX96 Touch RealTime PCR (Bio-Rad, EE.UU.) en un volumen de reacción total de 15 µL que contenía 8 µL de SYBR green master miX (TB GreenTM premiX EX TaqTMll) (Takara, Japón), 2.5 μl de primer forward, 2.5 μl de primer inverso, 2 μl de enzima Taq y 1 μl de plantilla de ADNc (6 μg/μl). La amplificación por PCR se realizó con una desnaturalización inicial a 95 °C durante 3 min; seguido de 40 ciclos de desnaturalización a 95 °C durante 30 s; recocido a 60 °C durante 20 s; extensión a 72 °C durante 30 s seguida de una extensión final a 72 °C durante 4 min. Se siguió el método comparativo 2
(Livak y Schmittgen, 2001) para analizar los niveles de expresión del gen Toll.
Análisis estadístico
Toda la data de este estudio se analizó con IBM SPSS 26 (SPSS Inc.). Se comprobó la normalidad de la data (N = 27) mediante la prueba de Shapiro-Wilk y se considera que se distribuyen normalmente cuando p > 0.05. Se calcularon las estadísticas descriptivas (medias y desviaciones estándar) para todos los parámetros. Los efectos de dos factores (variables independientes) a saber, los grupos (HPI, SPI y Controles), los intervalos
Referencia
de tiempo (0, 6, 12, 24, 36, 48, 60 y 72 hpi) y las interacciones (intervalos de tiempo de los grupos) en la variable dependiente (parámetros inmunológicos) se determinó mediante ANOVA de dos vías. El análisis de efecto medio simple se llevó a cabo para detectar la presencia de diferencias significativas entre los grupos a lo largo de los diferentes intervalos de tiempo (p < 0.05). Para comparar las diferencias entre los tres grupos experimentales (HPI x Control, SPI x Control y SPI x HPI) sobre la variable dependiente (parámetros inmunes), se utilizó la prueba post hoc de Tukey para comparaciones múltiples al nivel de significancia p < 0.05.
Resultados
Infección experimental
Los camarones sometidos a infección experimental de EHP tanto por alimentación oral (HPI) como por inyección en el seno ventral de esporas de EHP purificadas (SPI) resultaron ser débilmente positivos (PCR anidada positiva) para EHP a las 24 hpi. Se observó que los camarones estaban severamente infectados a las 72 hpi, ya que dieron positivo en la primera fase de PCR para EHP. Tanto los grupos HPI como SPI tuvieron una tasa de infección similar (100%) ya que todas las muestras de camarón (5/5) dieron positivo para EHP mediante PCR (Fig. 1).
Ensayos inmunológicos
Recuento total de hemocitos
Los valores de THC en los grupos SPI y HPI infectados experimentalmente disminuyeron significativamente (p < 0.05) en comparación con los grupos control de 6 a 72 hpi según lo determinado por ANOVA de dos vías (grupos*intervalos de tiempo - F (12,48) = 68.96, P < 0.001), análisis de efectos principales simples (p < 0.05) y prueba post hoc de Tukey para comparaciones múltiples de medias (p < 0.05) (Tabla 3). Se observó una reducción máxima del 47% en THC a las 72 hpi con EHP en grupos infectados experimentalmente. No se observaron cambios significativos en el THC en los camarones control (Fig. 2).
- DICIEMBRE 2022 30
PATOLOGÍA
— ΔΔCT
Tabla 2.- Primers utilizados para la detección de la expresión del gen Toll
Forward AGTCCCAAGCGGTGATGTG Dechamma et. al (2015) Reverso AGGGAGTCCAAGTGCCATTCT
Actividad profenoloxidasa
Los resultados de ANOVA de dos vías (grupos*intervalos de tiempo - F (14,48) = 65.22, P < 0.001) seguido de análisis de efectos principales simples (p < 0.05) y la prueba post hoc de Tukey (p < 0.05) mostraron la presencia de actividad proPO estadísticamente significativa tras la infección experimental con EHP en los grupos SPI y HPI en diferentes intervalos de tiempo en comparación con los controles (Tabla 3). La actividad de proPO en los camarones infectados con EHP en los grupos HPI y SPI fue significativamente mayor (p < 0.05) en comparación con el grupo control de 6 a 72 hpi con un valor máximo a las 48 hpi. Se observó una ligera caída en la actividad de proPO en los grupos infectados a las 72 hpi. Sin embargo, no se observaron cambios en los niveles de proPO en los camarones control sin infecciones por EHP durante el ensayo (Fig. 3).
Actividad de estallido respiratorio
La RBA fue significativamente más alta (p < 0.05) en el grupo infectado con EHP en comparación con los controles sanos de 6 a 48 hpi, según lo determinado por el análisis de efecto principal simple. Se observó que el valor aumentaba significativamente (p < 0.05) hasta las 24 hpi y luego disminuía. Sin embargo, no se observaron variaciones significativas en la RBA entre los grupos infectados y el control después de 48 hpi (Fig. 4). Los resultados fueron confirmados estadísticamente por ANOVA de dos vías (grupos*intervalos de tiempo - F (14,48) = 14.611, P < 0.001) seguido por la prueba post hoc de Tukey (p < 0.05) (Tabla 3).
Actividad de superóxido dismutasa (SOD)
La actividad de SOD en los grupos HPI y SPI fue significativamente más alta (p < 0.05) entre las 6 y las 48 hpi con la actividad máxima a las 24 hpi en comparación con los controles. Sin embargo, los niveles disminuyeron después de 48 hpi. No se observaron cambios significativos en la actividad de SOD en los grupos control. Los resultados de la actividad de SOD se representaron en la Fig. 5. Los resultados de ANOVA de dos vías (grupos*intervalos de tiempo – F (14,48) = 20.99, P < 0.001), análisis de efecto principal simple (p < 0.05) y la prueba post hoc de Tukey para comparaciones múltiples de medias para la actividad de SOD se proporcionaron en la
Fig. 1. Electroforesis en gel de agarosa de los productos de la PCR de camarones experimentalmente infectados con EHP. A. Productos de amplificación de la PCR obtenidos de PCR del paso I (gel superior) y PCR anidada (gel inferior) del grupo SPI en cada punto de tiempo que muestra amplificación detectable de productos de PCR anidada a las 24 hpi y productos de PCR del paso I a las 72 hpi. B. Productos de amplificación de PCR obtenidos de PCR del paso I (gel superior) y PCR anidada (gel inferior) del grupo HPI en cada punto de tiempo que muestra amplificación detectable de productos de PCR anidada a las 24 hpi y productos de PCR de paso I a las 72 hpi. [Carriles: marcador M de ADN (100 pb); 0 h a 72 h - productos de amplificación de PCR en cada punto de tiempo donde 1, 2, 3 son sus réplicas; N- Control negativo; P-Control positivo]

Tabla 3.
Actividad de catalasa
Las interacciones entre los efectos de los grupos y los intervalos de tiempo sobre la actividad de la catalasa fueron significativamente diferentes (grupos*intervalos de tiempo - F (14,48) = 10.9, p < 0.001) según lo determinado por ANOVA de dos vías. El análisis de efecto principal simple mostró que hay una disminución significativa (p < 0.05) de la actividad CAT en los grupos HPI y SPI en comparación con los controles de 24 a 72 hpi con el valor más bajo observado a las 72 hpi. La prueba post hoc de Tukey reveló la diferencia significativa en la actividad CAT entre los grupos (Fig. 6 y Tabla 3).
Actividad de lisozima
Los camarones infectados experimentalmente con EHP tanto en SPI como en HPI mostraron una reducción significativa (p < 0.05) en la actividad de LYS después de 24 hpi con una disminución máxima en el valor (50%) a las 72 hpi en comparación con el grupo control no infectado según lo determinado
por la ANOVA de dos vías (grupos*intervalos de tiempo – F (14,48) = 23.51, p < 0.001), análisis efecto principal simple (p < 0.05) y comparaciones múltiples de Tukey entre SPI, HPI y controles (Fig. 7 y Tabla 3) . No se observaron variaciones significativas en los valores de LYS dentro de los grupos de control.
Expresión del gen Toll
Se observó que la expresión del gen Toll estaba modulada en el hepatopáncreas durante la infección por EHP. Se observó una regulación ascendente significativa (p < 0.05) del gen Toll a partir de 12 hpi en camarones en grupos experimentalmente infectados, HPI (0.7 veces) y SPI (1.2 veces). Se observó un marcado aumento en la expresión del gen Toll de HPI (1.8 veces) y SPI (2.3 veces) a las 24 hpi, seguido de la expresión máxima en HPI (5.25 veces) y SPI (5.73 veces) a las 72 hpi. No se observaron cambios significativos en los niveles de expresión del gen Toll en el grupo control a las 0, 6, 12, 24, 36, 48, 60 y 72 hpi (Fig. 8). Los resultados de ANOVA de dos vías (grupo-s*intervalos de tiempo – F (14,48) = 1153.2, p < 0.001),
- DICIEMBRE 2022 31 PATOLOGÍA
Recuento total hemocitos x107 cel/ml
Postinfección (h)
Fig. 2. Recuento total de hemocitos en P. vannamei después de la infección experimental con EHP. El gráfico de barras verticales representa la media ± SD de tres tanques réplica por tanque (n = 3). Los asteriscos (***) indican la presencia de THC significativamente diferente entre los grupos (SPI, HPI y controles) en diferentes intervalos de tiempo como se determinó por análisis de efectos principales simples (p < 0.05). ns representa una diferencia no significativa entre los grupos. Las diferentes letras (a,b,c) sobre barras indican las diferencias significativas (p < 0.05) entre los grupos en un determinado intervalo de tiempo.


análisis de efecto principal simple (p < 0.05) y comparaciones múltiples de Tukey por parejas se proporcionan en la Tabla 3.

Discusión
La microsporidiosis hepatopancreática causada por EHP es un desafío importante que enfrenta el cultivo de P. vannamei a nivel mundial. Por lo tanto, se ha llevado a cabo una amplia investigación sobre su prevalencia (Tourtip et al., 2009; Ha et al., 2010; Flegel, 2012; Tangprasittipap et al., 2013; Liu et al., 2015; Tang et al., 2015; Rajendran et al., 2016; Biju et al., 2016; Giridharan y Uma,
Actividad profenoloxidasa μmol. min1 .mg -1
Postinfección (h)
Fig. 3. Actividad profenoloxidasa en P. vannamei después de la infección experimental con EHP. El gráfico de barras verticales representa la media ± SD de tres tanques réplica por tanque (n = 3). Los asteriscos (***) indican la presencia de THC significativamente diferente entre los grupos (SPI, HPI y Controles) en diferentes intervalos de tiempo determinados por análisis de efectos principales simples (p < 0.05). ns representa una diferencia no significativa entre los grupos. Las diferentes letras (a,b,c) sobre barras indican las diferencias significativas (p < 0.05) entre los grupos en un intervalo de tiempo determinado.
2017), la patogenicidad (Tourtip et al., 2009) y las medidas preventivas (Chaijarasphong et al., 2020). Sin embargo, la información sobre la respuesta inmunitaria del huésped a la infección por EHP es muy limitada (Santhoshkumar et al., 2016; Pan et al., 2018). El EHP infecta principalmente al hepatopáncreas, la principal glándula digestiva, lo que provoca una absorción nutricional deficiente que provoca un retraso grave del crecimiento o un crecimiento atrofiado y una inmunidad deficiente (Anderson et al., 1989; Chayaburakul et al., 2004; Tourtip et al., 2009; Tangprasittipap et
al., 2013; Tang et al., 2016).
Un estudio sobre la patogenicidad de EHP y la respuesta del huésped en camarones basado en la alimentación oral experimental de hepatopáncreas infectado con EHP dio como efecto, resultados positivos débiles a los 2 días posteriores al ensayo (dpc) y resultados positivos fuertes a los 4 y 7 dpc, como lo confirmó la PCR (Tangprasittipap et al., 2013). Esto es similar a las observaciones realizadas en este estudio, donde se encontró que los camarones infectados experimentalmente en los grupos
- DICIEMBRE 2022 32 PATOLOGÍA
Tabla 3.- Pruebas de Efectos Entre Sujetos y Comparaciones Múltiples para los parámetros inmunes analizados en este estudio.
Actividad de estallido respiratorio unidades/ml
Postinfección (h)
Fig. 4. Actividad de estallido respiratorio en P. vannamei después de una infección experimental con EHP. El gráfico de barras verticales representa la media ± SD de tres tanques réplica por tanque (n = 3). Los asteriscos (***) indican la presencia de THC significativamente diferente entre los grupos (SPI, HPI y Controles) en diferentes intervalos de tiempo determinados por análisis de efectos principales simples (p < 0.05). Ns representa una diferencia no significativa entre los grupos. Las diferentes letras (a,b,c) sobre barras indican las diferencias significativas (p < 0.05) entre los grupos en un intervalo de tiempo particular.
Actividad de superóxido dismutasa μmol. min -1 .mg -1
Postinfección (h)
Fig. 5. Actividad de superóxido dismutasa en P. vannamei después de una infección experimental con EHP. El gráfico de barras verticales representa la media ± SD de tres tanques réplica por tanque (n = 3). Los asteriscos (***) indican la presencia de THC significativamente diferente entre los grupos (SPI, HPI y Controles) en diferentes intervalos de tiempo según lo determinado por el análisis simple de efectos principales (p < 0.05). ns representa una diferencia no significativa entre los grupos. Las diferentes letras (a,b,c) sobre barras indican las diferencias significativas (p < 0.05) entre los grupos en un intervalo de tiempo determinado.
Actividad de catalasa unidades/ml
Postinfección (h)
Fig. 6. Actividad de catalasa en P. vannamei después de la infección experimental con EHP. El gráfico de barras verticales representa la media ± SD de tres tanques réplica por tanque (n = 3). Los asteriscos (***) indican la presencia de THC significativamente diferente entre los grupos (SPI, HPI y Controles) en diferentes intervalos de tiempo como determinado por análisis de efectos principales simples (p < 0.05). ns representa una diferencia no significativa entre los grupos. Las diferentes letras (a,b,c) sobre barras indican las diferencias significativas (p < 0.05) entre los grupos en un determinado intervalo de tiempo.
Actividad de lisozima unidades/ml
Postinfección (h)
Fig. 7. Actividad de lisozima en P. vannamei después de la infección experimental con EHP. El gráfico de barras verticales representa la media ± SD de tres tanques réplicas por tanque (n = 3). Los asteriscos (***) indican la presencia de THC significativamente diferente entre los grupos (SPI, HPI y Controles) en diferentes intervalos de tiempo como determinado por análisis de efectos principales simples (p < 0.05). ns representa una diferencia no significativa entre los grupos. Las diferentes letras (a,b,c) sobre barras indican las diferencias significativas (p < 0.05) entre los grupos en un determinado intervalo de tiempo.




- DICIEMBRE 2022 33 PATOLOGÍA
PATOLOGÍA
HPI y SPI tenían la PCR anidada positiva para EHP a las 24 hpi y la primera PCR fue positiva a las 72 hpi. En otro estudio, se demostró que la alimentación oral con tejido infectado con EHP da como resultado un EHP-PCR positivo a los 5 días posteriores a la infección (Santhoshkumar et al., 2016). La diferencia de tiempo en la detección de la infección por EHP podría deberse a la concentración de EHP presente en los tejidos infectados y los métodos utilizados para la transmisión experimental. La cohabitación de P. vannamei sanos con camarones infectados con EHP hizo que los camarones experimentales fueran positivos para EHP después de 7 días (Salachan et al., 2017). Aunque el modo de infección de cohabitación es un método no letal y seguro para provocar una infección por EHP, podría no ser un método efectivo para estudiar la respuesta inmune del huésped ya que la concentración de inóculo de EHP a la que están expuestos los camarones no se puede evaluar con precisión (Mai et al., 2020). Además, la alimentación oral de tejido infectado con EHP también tiene la limitación de que los tejidos infectados no se pueden almacenar a baja temperatura, ya que el tejido HP congelado no produjo infección por EHP en animales sanos expuestos en el experimento (Mai et al., 2020). Mientras tanto, la inyección a través de la ruta del seno ventral podría usarse como un método candidato para poner a prueba a los camarones con una concentración conocida de EHP para evaluar las respuestas inmunes del huésped, ya que facilita la infección experimental con una cantidad conocida de inóculo de EHP (Munkongwongsiri et al., 2021; Sathish Kumar et al., 2022).
En este estudio, se demostró por primera vez la infección experimental de P. vannamei con EHP mediante la inyección de esporas viables de EHP a través del seno ventral del cefalotórax en P. vannamei. Göpel y Wirkner, (2020) demostraron que el sistema lacunar de la hemolinfa está involucrado en la circulación de la hemolinfa en P. vannamei.
Por lo tanto, al inyectar a través del seno ventral, las esporas de EHP se introdujeron directamente en el sistema lacunar de la hemolinfa, que posiblemente fluirá junto con la hemolinfa y llegará a la glándula del intestino medio donde es capaz de producir infección al llegar al hepatopáncreas.
El sistema inmunitario innato del camarón comprende respuestas inmunitarias celulares y humorales, que trabajan en conjunto
Fig. 8. Expresión del gen Toll en P. vannamei después de la infección experimental con EHP. El mapa de calor representa la expresión de los genes Toll en términos de cambio de pliegues (Final-inicial/ inicial). La significancia de los dos efectos principales (Grupos e Intervalos de tiempo) y la interacción (Grupos*Intervalos de tiempo) se analizaron mediante ANOVA de dos vías. Los efectos principales simples (***) indican la presencia de una regulación significativamente diferente (p < 0.05) de los genes Toll entre cada grupo en diferentes intervalos de tiempo. Las comparaciones múltiples de Tukey revelan la diferencia por pares entre cada grupo en intervalos de tiempo a un nivel de significancia de 0.05 (**). Las diferentes letras (a,b,c) sobre barras indican las diferencias significativas entre los grupos en un determinado intervalo de tiempo (p < 0.05).

para ofrecer protección contra infecciones microbianas (Iwanaga y Bok, 2005; Kurata et al., 2006). Las respuestas celulares involucran varias funciones inmunitarias como la fagocitosis y la apoptosis a través de células inmunitarias como los hemocitos, el sistema de profenoloxidasa, el sistema antioxidante como las especies reactivas del oxígeno (ROS), superóxido dismutasa (SOD), catalasa, etc., (Wang et al., 2014). Mientras tanto, las respuestas humorales involucran varias enzimas o factores no específicos como lisozimas, lectinas, etc., que eliminan los patógenos ya sea por muerte directa o por inhibición de su crecimiento y propagación (Marques y Barracco, 2000; Tassanakajon et al., 2013). Como primer paso, el sistema inmunitario innato de los camarones identifica los patógenos a través de receptores de reconocimiento de patrones (PRR) para activar una serie de vías de señalización inmunitaria “downstream” que median la activación de las respuestas inmunitarias celulares y humorales (Li et al., 2019). Los receptores tipo Toll (TLRs) son una familia evolutivamente antigua
de PRRs que se presentan en animales que van desde los cnidarios hasta los mamíferos y que pueden detectar todo tipo de patógenos (Janeway y Medzhitov, 2000; Robalino et al., 2004). Confirmando esto, en nuestro estudio encontramos un aumento inicial en la expresión del gen Toll en grupos experimentalmente infectados a las 6 hpi, seguido de un aumento marcado a las 24 hpi y una expresión máxima a las 72 hpi. Simultáneamente, hubo un marcado cambio en las respuestas celulares. Los niveles THC en grupos experimentalmente infectados significativamente (p < 0.05) disminuyeron de 6 hpi. Por el contrario, la actividad de la profenoloxidasa aumentó significativamente (p < 0.05) a partir de las 6 hpi en comparación con los grupos control. Se observaron resultados similares sobre la regulación al alza de la expresión del gen Toll a las 24 hpi en un ensayo de P. monodon con Vibrio harveyi y WSSV (Dechamma et al., 2015; Arts et al., 2007) y a las 5 hpi en un ensayo de Fenneropenaeus chinensis con Vibrio anguillarium con la expresión máxima a las 23 hpi (Yang et al., 2008).
- DICIEMBRE 2022 34
suma
suma
Expresión del gen Toll
cambio de pliegues
de cuadrados grados de libertad valor f valor p
de cuadrados grados de libertad valor f valor p suma de cuadrados grados de libertad valor f valor p intervalos de tiempo Grupos *intervalos de tiempo Post infección (h) Grupos ANOVA de dos vías
La observación de nuestro estudio sugiere que el aumento de la expresión del gen Toll en respuesta a la infección por EHP puede haber activado las vías “downstream” que median las respuestas celulares como el THC y la proPO. Se encontró que la expresión de genes relacionados con la vía de señalización del sistema inmunitario innato está modulada en gusanos de seda en respuesta a la infección por N. bombycis (microsporidian) (Ma et al., 2013).
Los hemocitos son los inmunocitos más importantes en camarones y otros crustáceos (Vazquez et al., 2009). Desempeñan un papel importante en la respuesta inmunitaria innata, como la melanización, la fagocitosis, la coagulación, la formación de nódulos, la comunicación de célula a célula, la producción de encapsulación de péptidos antimicrobianos (AMPs), etc., para luchar contra patógenos invasores (Tassanakajon et al., 2013; Söderhäll, 2016). En nuestro estudio, el THC disminuyó significativamente en P. vannamei después de la infección por EHP. La reducción significativa (p < 0.05) de THC se observó a las 6 hpi hasta las 72 hpi cuando los camarones estaban severamente infectados (primera PCR positiva para EHP). Esta disminución de THC puede deberse a la migración de hemocitos al sitio de infección por EHP para fagocitosis o para curar la lesión creada por la extrusión de tubos polares cerca de las células epiteliales del hepatopáncreas (Sahul Hameed, 1989). Se ha observado una disminución en los niveles de THC en camarones cuando se experimentó con los principales patógenos de camarones como Vibrio harveyi (Bhoopathy et al., 2021; Huang et al., 2013), WSSV (van de Braak et al., 2002).
La proPO es la principal vía de respuesta inmunitaria en crustáceos ya que está asociada a una serie de funciones inmunitarias como la fagocitosis, producción y encapsulación de melanina (Ji et al., 2009). Se observó un aumento significativo (p < 0.05) en la actividad proPO de camarones expuestos a EHP (grupos SPI y HPI) a partir de las 6 y 60 hpi, que es aproximadamente un 42% mayor en comparación con el grupo control no infectado, con una fuerte disminución a las 72 hpi. La proPO puede activarse a través de varios factores como la proteína de unión a β-1,3 glucano, los lipopolisacáridos (LPS) y los peptidoglicanos
de cuerpos extraños, lo cual es facilitado por la cascada de reacciones mediada por serina proteasa en el cuerpo del camarón (Ji et al., 2009). Otro factor que activa la proPO es la enzima de activación de la proPO (PPAE). Una vez que el patógeno invade al huésped, este PPAE activa el sistema profenoloxidasa que convierte la profenoloxidasa en fenoloxidasa activa que es responsable de la melanización en el camarón (Johansson y Söderhäll, 1996). Los resultados de nuestro estudio fueron consistentes con un estudio anterior en el que las respuestas proteómicas y metabolómicas en P. vannamei infectados con EHP revelaron que existe una regulación positiva significativa de muchas proteínas relacionadas con la inmunidad del huésped, incluida la proteína de unión β-1,3 glucano, enzima activadora de profenoloxidasa (PPAE) e inhibidores de serina proteasa (Ning et al., 2019). También se encontró que las proteínas de unión a β-1,3 glucano se expresaban en gusanos de seda en respuesta a la infección por Nosema bombycis (microsporidian) en puntos de tiempo tempranos (Yue et al., 2015). En nuestro estudio, la infección experimental con EHP activó la proPO en P. vannamei, lo que podría ser una interacción entre los componentes inmunes del huésped, como los receptores Toll y las proteínas de unión a β-1,3 glucano o cualquier otra proteína relacionada de la pared de esporas de EHP, desencadenando aún más el sistema de cascada mediado por PPAE o serina proteasa que conduce a un aumento de los niveles de la proPO para luchar contra el EHP invadido. Aunque hay una mayor actividad de la proPO durante los primeros puntos de tiempo hasta 60 hpi, los niveles de infección de EHP no se redujeron, además, también hubo una caída en el nivel de la proPO a las 72 hpi, donde los camarones experimentales se vuelven positivos en el primer paso para EHP. Se observaron resultados similares en gusanos de seda durante la infección por Nosema bombycis (microsporidian), donde hubo un aumento en los niveles de proPO hasta 60 hpi, que disminuyó gradualmente después de 60 hpi, lo que puede deberse a la supresión parcial de la melanización de la hemolinfa debido a los efectos dañinos de las esporas invasoras (Ma et al., 2013). Es probable que los inhibidores de la serina proteasa como las serpinas secretadas por el microsporidio (N. bombycis) participen en la reducción de la actividad de la serina proteasa en los gusanos de seda, inhibiendo así el sistema en cascada mediado por la
serina proteasa (Ma et al., 2013). Esto se confirmó aún más (Ning et al., 2019) donde los camarones infectados con EHP muestran una regulación positiva de los inhibidores de la serina proteasa en casi 8.4 veces, en comparación con camarones sanos.
Las lisozimas son la principal enzima inmunitaria localizada dentro de los lisosomas (Misra et al., 2004) presentes en los hemocitos y se liberan en el plasma tras la desgranulación de los hemocitos durante una respuesta inmunitaria (Ratcliffe et al., 1985). Una vez liberadas, las lisozimas y otras enzimas proteolíticas se liberan en el plasma para combatir los patógenos extraños (Nicholson, 2003). En este estudio, la infección experimental por EHP ha reducido significativamente (p < 0.05) la actividad de la lisozima a partir de las 24 hpi cuando los camarones son débiles positivos (anidada) para EHP por PCR. Como las lisozimas actúan desde el interior de los hemocitos, en este estudio los niveles de THC y LYS disminuyeron significativamente (p < 0.05) en los camarones infectados con EHP en comparación con los camarones control no infectados. Es evidente que los hemocitos migraron a los sitios infectados para curar la lesión tisular causada por la infección, pero es posible que no sean capaz de fagocitar el EHP. En ausencia de fagocitosis o desgranulación de los hemocitos, es posible que las lisozimas no se liberen para combatir el EHP invadido y permitan provocar un aumento de la infección. La ausencia de lisozima condujo a la disminución de los recuentos de hemocitos y provocando un aumento de los recuentos bacterianos en los camarones expuestos a Vibrio sp. (Kaizu et al., 2011). Esta puede ser la razón de la disminución de la actividad de THC y lisozima en los grupos infectados con EHP. Sin embargo, las lisozimas no se desactivaron por completo y pueden expresarse tras la activación exitosa de la fagocitosis. Se encontró que las proteínas de lisozima estaban reguladas al alza en camarones infectados con EHP en las piscinas de cultivo (Ning et al., 2019), sugiriendo que la lisozima puede activarse en los puntos de tiempo posteriores a medida que avanza la infección. Se desconoce el mecanismo exacto de EHP para vencer la lisozima del camarón, pero se cree que muchas lisozimas tienen actividad quitinasa para degradar la quitina, que es el principal componente de la pared de esporas y su importancia en el control de EHP debe
- DICIEMBRE 2022 35 PATOLOGÍA
PATOLOGÍA
estudiarse en profundidad en estudios futuros.
El EHP, al ser un parásito intracelular obligado, carece de su propio mecanismo de producción de ATP para satisfacer por completo sus necesidades energéticas, por lo que depende completamente de su huésped para necesidades energéticas y nutricionales desde el momento previo a la infección (Yang et al., 2021). Cuando un organismo se somete a estrés físico, químico o biológico, se producirá una escasez repentina de oxígeno que dará lugar a rutas metabólicas anormales que resultando en la formación de una cantidad excesiva de oxígeno singlete (O2–) y radicales libres (Rabek y Rånby, 1978) que se denominan especies reactivas de superoxígeno (ROS) producidas por la actividad de explosión respiratoria (RBA). Los radicales libres como anión superóxido (O2 ), hidrógeno peróxido (H2O2), oxígeno singlete y el radical hidroxilo (OH ) son altamente microbicidas y se sabe que son los componentes más importantes de las respuestas inmunes en los crustáceos (Muñoz et al., 2000). Estas ROS no solo son tóxicas para los patógenos invasivos, sino que también exhiben efectos citotóxicos a las células huésped (Forman y Torres, 2001). O2- puede ser dismutado por SOD a H2O2, que puede metabolizarse aún más a H2O por catalasa, impidiendo así la síntesis del radical hidroxilo y contribuyendo a evitar los efectos nocivos de las ROS (Fridovich, 1998). En este estudio, la RBA aumentó significativamente (p < 0.05) desde las 6 hpi, alcanzando el máximo a las 24 hpi en los grupos infectados con EHP y los niveles disminuyeron significativamente (p < 0.05) después de las 24 hpi en comparación con el grupo control no infectado. Estos resultados sugieren que, durante el punto de tiempo temprano de la infección, el EHP ha causado estrés oxidativo en los camarones debido a la absorción de energía y nutrientes del huésped para su desarrollo. La infección por Nosema ceranae en las abejas aumentó el estrés oxidativo en el intestino medio (Aufauvre et al., 2014; Kurze et al., 2016), lo que respalda el hecho de que los microsporidios podrían alterar los procesos del huésped que están involucrados en el metabolismo energético y la respuesta inmunitaria. Se encontró que el SOD y catalasa se alteraron durante la infección con EHP para superar el estrés oxidativo provocado por la
infección. Los niveles de SOD aumentaron significativamente (p < 0.05) en paralelo al RBA a partir de las 6 hpi, alcanzando un valor máximo a las 24 hpi y reduciéndose después de las 24 hpi en los grupos infectados, en comparación con los controles no infectados. Por el contrario, los niveles de catalasa en la hemolinfa se redujeron significativamente (p < 0.05) constantemente de 6 hpi a 72 hpi. Estos resultados sugieren que el aumento de la actividad de SOD y la disminución de RBA después de 24 hpi pueden deberse al aumento de los niveles de aniones de superóxido y otros radicales libres durante el estrés oxidativo. Estos resultados están respaldados por hallazgos previos donde la actividad de SOD disminuyó en P. monodon infectado con WSSV que en los animales control no infectados (Lin, 1998; Chang et al., 2003). Se reportó que el oxígeno singlete y los radicales hidroxilos inactivan la SOD con la consiguiente pérdida de actividad enzimática (Escobar et al., 1996). Este estudio también documentó un nivel más bajo de catalasa en la hemolinfa. Parece que el aumento de la actividad de la SOD puede producir en exceso compuestos de peróxido de hidrógeno de las ROS que podrían volverse tóxicos para la célula huésped y la catalasa presente en la hemolinfa puede utilizarse para metabolizar este exceso de H2O2 a H2O. Un estudio de Mohankumar y Ramasamy (2006) demostraron que la infección experimental de WSSV había disminuido la actividad SOD y catalasa en respuesta al estrés oxidativo causado por el patógeno en Fenneropenaeus sp. El estudio actual ha confirmado la aparición de un mecanismo similar en P. vannamei infectado con EHP. Los antioxidantes pueden desempeñar un papel en la protección de las células huésped del estrés oxidativo causado por EHP, lo que podría ser una razón para la reducción de la tasa de mortalidad en camarones infectados con EHP dejándolos hambrientos de nutrientes y energía con el parásito invadido que conduce a una inmunidad deficiente y un crecimiento retardado como efecto clínico principal. La comprensión de la inmunidad del huésped en P. vannamei durante la infección experimental con EHP será útil para desarrollar medidas inmunoprofilácticas para reducir el impacto negativo causado por EHP en el huésped. Hay varios informes sobre el uso de inmunoestimulantes en camarón para inducir la actividad de parámetros inmunitarios no específicos como THC,
PPO, SOD, RBA, lisozima como medio de protección contra la infección (Apines-Amar y Amar, 2015).
Este trabajo ha arrojado luz sobre las primeras respuestas inmunitarias del huésped en P. vannamei durante la infección por EHP. El hallazgo de este estudio ha demostrado que la infección por EHP da como resultado un aumento del estrés oxidativo (RBA) a partir de las 6 hpi, que fue contrarrestado por SOD y CAT a partir de las 6 h y las 24 h respectivamente para proteger a la célula huésped de dicho daño oxidativo. La expresión del gen Toll se activó como una respuesta temprana a medida que EHP interactúa con el huésped y activa el sistema de profenoloxidasa y la migración de hemocitos al sitio de infección para combatir el EHP invadido desde las 6 hpi. Aunque se activaron las respuestas apropiadas, parece que no son lo suficientemente eficientes para eliminar el EHP. Por otro lado, las lisozimas que actúan desde el interior de los hemocitos parecían ser desactivadas por EHP o incluso tal vez no liberadas de los hemocitos ya que los hemocitos no logran producir una auto desgranulación o son incapaces de fagocitar parásitos intercelulares a medida que los niveles se reducen de 24 hpi. A pesar de que existen múltiples estrategias empleadas por el huésped para luchar contra cualquier infección, los microsporidios pueden invadir las células epiteliales del huésped, ya que su proliferación implica la formación de una fase meronte en la membrana (Troemel et al., 2008). La infección experimental con EHP causó una infección grave en los camarones, ya que se detectaron como positivo el primera PCR para EHP a las 72 hpi. Esto puede deberse a que los microsporidios son capaces de usar una variedad de proteínas secretadas y de superficie para interactuar con sus células huésped y manipularlas (Cuomo et al., 2012).
Conclusión
Este es el primer estudio documentado que proporciona información de referencia sobre respuestas inmunitarias en P. vannamei durante la infección experimental por EHP. Estos resultados pueden ayudar a desarrollar medidas inmunoprofilácticas para inducir la inmunidad innata o no específica para contrarrestar la infección por EHP en P. vannamei•
- DICIEMBRE 2022 36


a) Departamento Investigación y Desarrollo, Applied Blue Biotechnology APB-BIO C.A., Km 4.5 Vía a Taura, Ecuador info@apb-bio.com 38
Biotecnología para el control de patologías de origen bacteriano en los cultivos de camarón. Estudio de caso de utilización de bacteriófagos líticos endémicos contra Vibrio parahaemolyticus Autores: Daniel Aguilera-Pesantesa Joselyn Castroa Patricio Bucheli Doménica Vargasa
Ha sido una constante, desde el nacimiento de la industria camaronera en Ecuador, el desarrollo de prácticas de producción que conduzcan a mayor productividad y sustentabilidad, y consecuentemente más alta rentabilidad. La intensificación de la producción en Ecuador es un reto importante desde varios ángulos, como en la producción de larva de alta calidad en toda la industria, inicialmente trabajada desde el concepto de larva SPR, y más recientemente optimizada en innovadores sistemas de mejoramiento genético, como los descritos por Rocha (2022). Grandes esfuerzos técnicos y económicos se han realizado en la optimización de la oferta de dietas de alta calidad, que cumplen con las necesidades nutricionales de animales de alto desempeño. Se ha introducido y generalizado un número importante de alternativas de sistemas de alimentación inteligente mediante alimentadores automáticos activados con mecanismos de detección acústica (Bravo & Santos, 2019). Se cuenta con una variedad de sistemas de aireación, con diseños variados de recirculación para producción en áreas de limitada disponibilidad de agua, y existe una abundante oferta de insumos de alta calidad que trata de cubrir con las necesidades de prácticamente todos los segmentos de la industria.
Sin embargo, una condición inherente a la intensificación es el incremento sustancial de la deposición de materia orgánica en las piscinas, con los perjuicios que esto acarrea. La estructura productiva en las granjas en Ecuador, a diferencia de aquellos sistemas de producción intensivos en Asia, presentan limitaciones operativas para la aplicación de procesos mecánicos o hidráulicos eficientes en la remoción sistemática de materia orgánica, debido a las dimensiones de las piscinas de engorde (Moreira & Bastidas, 2021). La acumulación de carbono orgánico principalmente por aportes de desechos ricos en quitina y otros residuos en los fondos de las piscinas, se convierten en sustratos ideales para la proliferación de bacterias patógenas, entre ellos Vibrio sp
En los últimos años, cuadros patológicos y síndromes asociados a bacterias se han establecido como importantes retos y problemas a resolver para superar
mortalidades en diferentes estadios dentro del ciclo de producción, no solamente en granjas de engorde, sino también en laboratorios de producción de larvas. Varios de estos problemas en la salud de los cultivos, y no únicamente circunscritos a ellos, se deben a la presencia de Vibrio sp., en particular V. parahaemolyticus Las variaciones más agresivas de estas patologías se observan en la forma de AHPND.
La enfermedad de la necrosis aguda del hepatopáncreas o AHPND por sus siglas en inglés, fue inicialmente referida como EMS (Lightner, et al., 2012) debido a la observación de mortalidad masiva en los primeros 30 días después de las siembras. Al año siguiente Tran y otros (2013), especifican como AHPND a la enfermedad al haber identificado líneas de V. parahaemolyticus involucrados en tal evento que producen toxinas específicas que afectan a las células epiteliales de los túbulos del hepatopáncreas, afectando camarones en cualquier momento del ciclo de producción. Puntualmente se trata de la toxina binaria PirAB (Photorabdus Insect-related) identificada como el factor de virulencia para este grupo de V. parahaemolyticus. (Ikuo Hirono, et al. 2015)
En el presente, la comprensión del impacto de la dinámica microbiana en la calidad del ambiente, ha sido el motor conductor del desarrollo de prácticas asociadas al uso de soluciones tales como la biorremediación y la probiosis. Así, se considera cada vez con mayor intensidad el uso de otras herramientas en el control de enfermedades como esta.
Bacteriófagos

En años recientes se ha vuelto la mirada al uso de Bacteriófagos, también llamados Fagos, como una alternativa para el manejo de cuadros bacterianos en la acuacultura.
Los bacteriófagos son virus que parasitan bacterias (Pal, 2015). Por lo tanto, son agentes antibacterianos de ocurrencia natural. Son los organismos más abundantes de la naturaleza (> 1030) y se encuentran en todos los ecosistemas. Juegan un papel importante en la regulación de las poblaciones bacterianas y su estructura (Middelboe, 2015). De acuerdo con el Comité internacional En Taxonomía de Virus (ICTV), los bacteriófagos han sido clasificados por su morfología. Actualmente, han sido examinados más de 5,500 Fagos, 96% de estos presentan cauda o cola, “Tailed”, y pertenecen al Orden de Caudovirales, el cual está compuesto por tres familias (Myoviridae, Siphoviridae y Podoviridae).
Los bacteriófagos fueron descubiertos en 1915, por el bacteriólogo franco-canadiense Frederick Twort. A pesar de que los fagos fueron fundamentales para sustentar sistemas experimentales en el marco de la ecología y la evolución y que significaron la base de herramientas de biología molecular, su estudio y aplicación directa como agente de control bacteriano sigue estando circunscrito a un ámbito muy especializado. Una de las principales razones por las cuales el desarrollo amplio de tecnología asociada a su uso como terapia, se vio ralentizado de manera significativa, tuvo que ver con el aparecimiento de los antibióticos. En el tiempo, el reconocimiento de los efectos negativos de los antibióticos, causados en parte por su uso indiscriminado, y el aparecimiento de Bacterias catalogadas como MDR (Multi Drug Resistant), o resistentes a muchas Drogas, ha permitido dirigir nuevamente la mirada a estas alternativas para el manejo de patologías.
La capacidad de un bacteriófago para ser usado como agente terapéutico está asociada directamente a su ciclo de vida. De esta manera, se deben emplear los bacteriófagos líticos o virulentos. Estos
- DICIEMBRE 2022 39 PATOLOGÍA
realizan un ciclo de vida lítico (Kuttery Sulakvelidze, 2005; en Elliot, 2014), el cual implica que una vez que han infectado a la bacteria hospedadora, utiliza su maquinaria celular para multiplicarse dentro de ella y dar paso a la progenie viral, la cual se libera al exterior tras la lisis de la misma (Gutiérrez, et al., 2020).
Hay fagos que para su reproducción cumplen un ciclo conocido como lisogénico que, a diferencia de aquellos que son líticos, una vez que el fago ingresa su material genético, este integra su ADN en el genoma de la bacteria. De esta manera, el ADN del fago se replica junto con el de la bacteria y se convierte en un profago. Así, el bacteriófago solo secuestra parcialmente la maquinaria celular de la bacteria y no provoca una liberación de los viriones mediante lisis, sino solamente cuando condiciones adversas propician una respuesta lítica.
Otro factor importante para tomar en cuenta para el uso de fagos en acuacultura, es que estos son específicos para cada grupo bacteriano al cual tienen capacidad de infectar. En este sentido, afectan únicamente a las bacterias en las cuales proliferan y, debido a este proceso, se mantienen en permanente reproducción mientras la bacteria huésped continúe presente. Esta característica resulta de mucha importancia toda vez que significa que el tratamiento en sí se prolonga mientras la infección se encuentre en curso. Por otra parte, los bacteriófagos son autolimitantes, es decir, cuando no existe en el medio una bacteria a la cual el fago pueda infectar, la partícula viral es inerte e incapaz de reproducirse.
En el contexto explicado en líneas anteriores, la información siguiente describe una bioprospección de bacteriófagos con actividad lítica contra cepas de Vibrio parahaemolyticus provenientes de camaroneras ecuatorianas, para caracterizar su potencial para ser empleados como agente terapéutico.

La experiencia en Ecuador
Obtención
de las muestras
Se realizó una amplia bioprospección durante los años 2020 y 2022. Se procesaron aproximadamente 400 muestras provenientes de agua de piscinas de camaroneras, laboratorios de larvas e
instalaciones de procesamiento de camarón; en las provincias del Guayas y Santa Elena. Se utilizó agua debido a que presenta una mayor abundancia y diversidad microbiológica, en comparación con otros tipos de muestras. Simultáneamente, a partir de las muestras procesadas se construyó un cepario de aislados de Vibrio sp. con énfasis en Vibrio parahaemolyticus, y a partir de allí, se realizó el proceso de enriquecimiento y aislamiento de bacteriófagos.
Identificación bioquímica y construcción de cepario de Vibrio sp. De las muestras de agua de las piscinas de camarones se identificaron y aislaron bacterias de la especie V. parahaemolyticus mediante los siguientes medios de cultivo: Agar Tiosulfato Citrato Bilis Sacarosa (TCBS) y ChromoAgar Vibrio (CAV), dando como resultado colonias verdes en el medio TCBS y colonias color malva en el medio CAV. Para verificar los resultados obtenidos de las muestras analizadas se utilizó el sistema API 20E de BIOMÉRIEUX, que consiste en 21 pruebas bioquímicas para la identificación de Enterobacterias y microorganismos Gram negativos. Las cepas aisladas con un rango de similitud de 96-99% para V. parahaemolyticus fueron almacenadas con glicerol+BHI en congelación a -80 °C. El cepario actualmente cuenta con 485 aislados de Vibrio sp, de los cuales 80 son V. parahaemolyticus.
Enriquecimiento de bacteriófagos en las muestras de agua
Cada una de las muestras de agua se filtró empleando tamaños de poro 0,45 y 0,20 μM. Se colocó 50 mL de la muestra con un inóculo fresco de V. parahaemolyticus (huésped previamente aislado proveniente del cepario) y 5 mL de DPBS (extracto de levadura y peptona). Se incubó durante 72 horas a 120 rpm y una temperatura de 37 ° C. Después de ello, se purificó la muestra mediante varios ciclos de centrifugación a una velocidad de 4600 rpm y se realizó una filtración mediante tamaños de poro 0,45 y 0,20 μM, esto con el fin de separar cualquier residuo de bacteria.
Detección de la presencia de bacteriófagos
Se utilizó la técnica de ‘’spot test‘’ para determinar la presencia de bacteriófagos competentes contra las bacterias enriquecidas. Para ello, se suspendió cada bacteria hospedadora enriquecida (Vibrio parahaemolyticus) en una solución tampón PBS (Phosphate buffered saline) en un rango de (0,060-0,070) de absorbancia a una longitud de onda de 600 nm. A continuación, se realizó una siembra vertical de cada bacteria en una caja Petri con agar de soja tríptico (TSA) y se colocó sobre el mismo una gota de 2 µL de cada una de las muestras purificadas del paso 3. Las placas se incubaron durante la noche a una
- DICIEMBRE 2022 40 PATOLOGÍA
Ciclo lítico de un virus bacteriófago
temperatura de 37 °C. Los filtrados en los que se observó zonas de lisis en el medio de cultivo de TSA, se seleccionaron para el aislamiento, purificación y preservación.
Aislamiento y purificación de bacteriófagos Para el aislamiento y purificación de bacteriófagos se realizó una adaptación del ensayo de doble capa de agar descrito por Moreno, et al. (2013). Para ello, se tomaron alícuotas de 100 µL de las muestras con actividad verificada en el spot test y se realizó un estriado en el medio sólido TSA, seguido a ello se mezcló 500 µL del cultivo de bacteria en fase exponencial con agar suave líquido de TSA; este fue colocado de manera uniforme sobre el agar sólido. Se llevó a incubación durante toda la noche a una temperatura de 37 °C.
Transcurrido el tiempo de incubación, se evidenció la formación de placas de lisis bacteriana en la zona del estriado, las cuales fueron transferidas a 1 mL de buffer SM. A continuación, se realizó el proceso de infección del bacteriófago aislado, para lo cual se tomaron alícuotas de 100 µL de la placa viral suspendida en buffer SM y 100 µL del cultivo bacteriano en fase exponencial. Y se realizó el ensayo de doble capa descrito. Para la purificación de las placas virales obtenidas, se repitió el procedimiento descrito 4 veces. Cabe indicar que, se obtuvieron 65 cepas puras de bacteriófagos con actividad para bacterias aisladas de la Vibrio parahaemolyticus del paso 2.
Cinética de inhibición - Eficiencia in vitro.
Se evaluó la capacidad de inhibición de los bacteriófagos aislados sobre las bacterias hospedadoras (V. parahaemolyticus) endémicas de camaroneras del Guayas y Santa Elena. Para ello, se realizó una prueba de cinética de infección de bacteriófagos según el protocolo propuesto por Haq, Chaudhry, & Andleeb (2012).
La prueba consiste en aplicar diferentes valores de MOI (multiplicidad de infección), lo cual se refiere al número de agentes virales que infectan una célula. Es así que, se aplicó un MOI 1 y un MOI 10; se utilizó una concentración de bacteria hospedadora aproximada de 1x108 UFC/ml y las concentraciones de 1x108 UFP/mL y 1x109 UFP/mL, respectivamente para cada MOI de
Análisis de las ventajas y desventajas comparativas en el uso de fagos (Adaptado de Elliot, 2014)
Característica
Alta Especificidad. Tipo de ciclo del bacteriófago. Toxicidad.
Ventajas
Estrategia dirigida a un problema puntual. Afectación mínima a la microflora benéfica normal.
Los Fagos virulentos o de ciclo lítico son agentes bactericidas. La bacteria objetivo es eliminada, y son incapaces de desarrollar resistencia a Fagos, o a otros antimicrobianos.
Desventajas
La bacteria causante de la enfermedad debe estar identificada antes de que la terapia de Fagos pueda iniciarse exitosamente.
Fagos Temperados o de ciclo lisogénico son agentes de transferencia horizontal.
Para terapia con Fagos solo se pueden usar Fagos virulentos, que no poseen genes de resistencia, o factores virulentos.
Los fagos son Ácidos Nucleicos encapsulados en proteínas. Por lo tanto, son inherentemente no tóxicos para plantas, animales y el ambiente.
Existe poca evidencia sobre respuestas inmunes adversas. Sin embargo, es crucial que los protocolos que se desarrollen resulten en preparaciones altamente purificadas, para evitar la presencia de restos bacterianos.
Administración.
La administración de Fagos puede ser oral, en aerosoles, por inmersión, por inyección, en los alimentos, o de manera tópica. La preparación de fagos puede realizarse en tabletas, líquidos, polvo, y puede ser viable por muchos años en algunas preparaciones.
Animales enfermos podrían no estar alimentándose. Inyecciones a grandes números de animales, puede ser problemático.Los Fagos liberados al agua desde alimento no consumido, puede también actuar como un tratamiento por inmersión.
Obtención de fagos para nuevos patógenos bacterianos. Especificidad y oblicuidad.
Seleccionar nuevos fagos es un proceso relativamente rápido y de bajo costo. Argumentos evolutivos apoyan la idea de que los fagos virulentos pueden ser seleccionados contra cualquier bacteria resistente a antibióticos o resistente a otros fagos, por el permanente proceso de selección natural.
Los fagos se replican en el sitio de la infección. Por lo tanto, es posible aislar nuevos fagos en cada brote de una nueva cepa bacteriana patógena.
La selección de nuevos fagos es un proceso que debe realizarse de manera constante. Se deben seleccionar y purificar únicamente fagos estrictamente virulentos, lo cual debe ser verificado.
Los fagos se replican en el sitio de la infección. Por lo tanto, es poco probable que un bacteriófago sea activo contra una bacteria proveniente de un punto geográfico lejano y diferente.
Resistencia de bacterias hacia bacteriófagos.
Las bacterias que se convierten en resistentes a un fago continúan siendo susceptibles a otros fagos. El desarrollo de cocteles de fagos reduce el aparecimiento de resistencias a Fagos. Normalmente una bacteria resistente a bacteriófagos es susceptible a compuestos con actividad antimicrobiana y viceversa. La combinación entre bacteriófagos con compuestos antimicrobianos tiene un efecto potenciador.
Frecuencia de uso.
El crecimiento exponencial de los fagos en el lugar de la infección podría requerir de menos frecuentes administraciones de fagos para alcanzar el óptimo efecto terapéutico.
Las bacterias pueden adquirir resistencia a la infección de bacteriófagos por una diversidad de mecanismos.
En la práctica se ha observado que se requieren múltiples administraciones frecuentes de bacteriófagos para obtener un mejor efecto terapéutico.
- DICIEMBRE 2022 41 PATOLOGÍA
los bacteriófagos aislados y purificados. Se evaluaron combinaciones de bacteriófagos individualmente con distintos hospedadores de V. parahaemolyticus. Se realizaron mediciones durante 9 horas a una longitud de onda de 600nm.
Se evidenció inhibición del crecimiento de V. parahaemolyticus en todos los casos. Se observó diferencia significativa entre la actividad de los diferentes bacteriófagos evaluados y en las condiciones de MOI. Se obtuvo una inhibición de hasta el 50% con un MOI de 1 y de hasta 78% con un MOI de 10 a las 5 horas de infección.

Adicionalmente, se realizó una variante del ensayo de cinética de inhibición descrito anteriormente, tratando de simular las condiciones reales de una piscina de camarones con un evento de vibriosis severo. De esta manera, se partió de una concentración inicial de V. parahaemolyticus 1x108 UFC/ml y se evaluó el efecto sobre su crecimiento mediante la adición de un bacteriófago en niveles de MOI de 1, 10 y 100. Se realizaron cultivos en el medio TCBS a las 8, 24 y 48 horas después de la infección. Se encontró que la concentración de V. parahaemolyticus a un MOI de 100, fue 99.9% menor que el control positivo a 24 horas después de la infección.
Conclusiones
Al finalizar la primera fase de investigación se ha concluido lo siguiente:
Se aislaron 485 cepas puras de Vibrio sp., de las cuales 80 fueron identificadas como cepas puras de V. parahaemolyticus. Además de ello se aislaron, identificaron y purificaron 65 cepas de bacteriófagos.
Se desarrolló una metodología que permite obtener y evaluar bacteriófagos a partir de muestras de agua de camaroneras y laboratorios de larvas.
Se demostró que los bacteriófagos recolectados presentan una alta eficiencia para eliminar bacterias patógenas de la especie Vibrio parahaemolyticus provenientes de camaroneras y laboratorios de larvas de las provincias del Guayas y Santa Elena.

El uso de bacteriófagos representa una
Imagen 1. Esquema del procesamiento para el enriquecimiento y purificación de muestras de agua para la detección de bacteriófagos.
Imagen 2. Esquema de la técnica de spot test para la confirmación de la presencia de bacteriófagos en las muestras preenriquecidas y purificadas. En la foto de la derecha se observa una placa en donde existe lisis bacteriana evidente en tres puntos, confirmando la presencia de bacteriófagos.


Imagen 3.- Esquema del proceso del ensayo de doble capa de agar para la obtención de cepas puras de bacteriófagos. En la foto de la derecha se observa una placa con lisis evidente en la zona de estriado y formación de calvas virales alrededor de esta.
Imagen 4.- Cinética de inhibición del Bacteriófago F9 sobre V. parahaemolyticus V87 durante 9h a un MOI de 1 y de 10.
- DICIEMBRE 2022 42 PATOLOGÍA
alternativa técnicamente viable para el desarrollo de terapias contra patologías ocasionadas por bacterias del género Vibrio sp. en la cría de camarón en todas sus etapas. Así mismo, representa una alternativa al tratamiento con antibióticos para combatir enfermedades en el área de la acuicultura.

Al momento se están llevando aplicaciones en campo en granjas en sistemas convencionales y de recirculación•
Para más información sobre este artículo escriba a: info@apb-bio.com
Agradecimientos: Los autores agradecen al Director del Grupo Naturisa, al Director del grupo Champmar, a sus laboratorios asociados, al Ac. Jaime Baquerizo, al Biol. Jorge Córdova, MSc., y al Biol. Manuel Bajaña, MSc., por su generoso apoyo a este trabajo.
Bibliografía
Bravo, L. K., & Santos, G. E. (2019). Evaluación de dos métodos de alimentación para engorde de camarón blanco (Litopenaeus vannamei) (thesis). CARRERA DE INGENIERÍA AGRONÓMICA, Zamorano.
Elliott, Lisa & Pty, Ausphage & Australia, Ltd. (2014). BACTERIOPHAGE THERAPY IN AQUACULTURE – FRIEND OR FOE?. 10.13140/2.1.4408.2883.
Haq U, Chaudhry W, Andleeb S, et al. (2012). Isolation and Partial Characterization of a Virulent Bacteriophage IHQ1 Specific for Aeromonas punctata from Stream Water. Microbial Ecology, 954-963.

Ikuo Hirono, sasywipa Tinnwongger, Yki Nochiri; Hidehiro kondo (2015) Latest research On AHPND of Penaeid Shrimps. In: Addressing acute hepatopancreatic necrosis disease (AHPND) and other transboundary diseases for improved aquatic animal health in Southeast Asia. Aquaculture Department. Southeast Asian fisheries Development Center).
Ligthner, D.V.R.M. Redman, C. Pantoja, B.L. Noble, L. Tran (2012)Early Mortality syndrome affects Shrimp in Asia. M.Middelboe, Microbial disease in the Sea: Effects of viruses on carbon and nutrient cycle (Princeton University press, Princeton, NJ, 2008)
Moreira, G. G., & Bastidas, C. J. (2021). “Análisis de ciclo de vida del camarón cultivado de la especie Litopenaeus vannamei en la provincia del Guayas (thesis). Facultad de Ingeniería en Mecánica y Ciencias de la Producción, Guayaquil.

Moreno Switt, A., Den Bakker, H., Vongkamjan, K., Hoelzer, K., Warnick, L., Cummings, K., & Wiedmann, M. (2013). Salmonella bacteriophage diversity reflects host diversity on dairy farms. Food Microbiology. 257-285.
Rocha, J; Buchenam, J.; Gezan S.; Towner, R; Stannard, J; Verduga, R. (June, 2022) World´s first fully integrated Pacifica White shrimp Genomic selection program established in Ecuador. Responsible Seaffod Advocate magazine Subharthi Pal (2015) Phage therapy an alternate disease control in Aquaculture. A review on recent Advancements. IOSR Journal of Agriculture and Veterinary Science Vol 8. Issue 9. Ver 1 (pp.68-81)
S.T. Abedon; T.D. Herschler; D. Stopar (2001) Bacterophage latent-Period Evoluction as a Response to Resource availability. In: Applied Environm. Microbiol. Sept 2001 p4233-4341
Tran, L. Numan, R.M. Redmn, L.L. Mohney, C.R. Pantoja, K. Fitzsimmons, D.V. Ligthner. 2013. Fetermination of the Onfectious nature of the agent of acute hepatopancreatic negrosis syndrome affecting penaeid shrimp. Dis.Aquat. Org., 105:45-55
Imagen 4.- Cinética de inhibición del Bacteriófago F9 sobre V. parahaemolyticus V87 durante 48h a un MOI de 1, 10 y 100.
Imagen 5.- Placas de lisis celular del Bacteriófago específico para V. parahaemolyticus V87.
www.cna-ecuador.com
- DICIEMBRE 2022 43 PATOLOGÍA
Tiempo (Horas)
Escanea y mira la entrevista sobre el uso de bacteriófagos para el control de enfermedades en CNA Video Podcast

Dando sentido a la taxonomía de los camarones de mayor importancia comercial Penaeus Fabricius, 1798 s. l. (Crustacea: Decapoda: Penaeidae), un camino a seguir
Autores:

Chien-Hui Yang a, 1
Ka Yan Ma b, c, 1
Ka Hou Chu c, d
Tin-Yam Chan a, *
a Instituto de Biología Marina y Centro de Excelencia para el Océano, Universidad Nacional de los Océanos de Taiwán, Keelung 202301, Taiwán b Escuela de Ecología, Universidad Sun Yat-Sen, Shenzhen, China
c Laboratorio de Ciencias Marinas Simon F. S. Li, Facultad de Ciencias de la Vida, Universidad China de Hong Kong, Shatin, N. T., Hong Kong, China d Laboratorio de Ciencia e Ingeniería Marinas del Sur de Guangdong (Guangzhou), Guangzhou 510301, China
tychan@ntou.edu.tw www.elsevier.com/locate/aquaculture https://doi.org/10.1016/j.aquaculture.2022.738955
El problema de la falta de consenso sobre una clasificación genérica de camarones en el género Penaeus Fabricius, 1798 ha persistido desde la publicación de una revisión de Pérez Farfante y Kensley (1997); y diferentes autores han adoptado taxonomías alternativas (p. ej., De Grave y Fransen, 2011; Tsoi et al., 2014; Tavares y Gusmão, 2016; Psomadakis et al., 2019). Por conveniencia, en este documento nos referimos al uso anterior a 1997 como Penaeus s.l. (sensu lato, es decir, en sentido amplio). En contraste, nos referimos al significado más restringido de Penaeus utilizado por Pérez Farfante y Kensley (1997) como Penaeus s.s. (sensu stricto, es decir, en sentido estricto). Al abordar la controversia, Ma et al. (2011) concluyeron que se necesitaba más trabajo filogenético molecular antes de poder tomar una decisión científicamente sólida con respecto a la revisión taxonómica propuesta por Pérez Farfante y Kensley (1997). Aquí, presentamos dicho trabajo filogenético molecular y, en base a sus resultados, presentamos una propuesta para una solución científicamente sólida para lograr una estabilidad taxonómica.
Los camarones del género Penaeus s.l. son los crustáceos económicamente más importantes (Holthuis, 1980; Dall et al., 1990), con una producción de alrededor de 450,000 toneladas
PATOLOGÍA
PATOLOGÍA
en la pesca (captura) y 6.2 millones de toneladas en acuicultura en 2019 (FAO, 2021). Dado el comercio internacional a gran escala de este grupo, y una historia muy larga con un nombre genérico estable, los cambios importantes en este nombre tienen consecuencias en los costos de los cambios requeridos en el empaque o reetiquetado y en la impresión de documentos de control comercial y documentos o manuales técnicos/científicos. Por lo tanto, es mejor cambiar un nombre genérico de larga trayectoria por especies comerciales cuando existe una taxonomía sólida basada en evidencia filogenética para acomodar los resultados de nuevas investigaciones en un sistema de clasificación natural. Antes de 1997, Penaeus s.l. a veces se subdividía en seis subgéneros. Estos subgéneros fueron elevados al rango de Género por Pérez Farfante y Kensley (1997) utilizando los estados de caracteres existentes. Su nomenclatura fue seguida por muchas personas, pero no todos estuvieron de acuerdo. Esto ha causado mucha confusión y discusiones sobre el uso correcto de los nombres de género para las especies que antes se asignaban a Penaeus (ver Davie, 2002; Alderman et al., 2007; Dall, 2007; Flegel, 2007, 2008; McLaughlin et al., 2008; Liao et al., 2016; Figueredo et al., 2022). Numerosas revistas científicas, como Journal of Crustacean Biology y el Journal of the World Aquaculture Society (Camp, 1999, 2000), han persuadido y requerido la presentación de artículos relacionados con Penaeus s.l. adoptando el esquema de clasificación de seis géneros de Pérez Farfante y Kensley (1997). Aunque el uso de nombres de varios géneros o subgéneros para Penaeus s.l. es más común en la literatura científica reciente (por ejemplo, Zhang et al., 2019; Boonyakida et al., 2020; Toyota et al., 2020; Wiradana et al., 2020; Boyd et al., 2021; Francis et al., 2021; Machado et al., 2021; Collins et al., 2022; Liu et al., 2022), FAO, GBIF (Centro Global de información de Biodiversidad), GenBank (Centro Nacional de Información Biotecnológica, NCBI), WOAH (Organización Mundial para la Salud Animal, anteriormente OIE) y WoRMS (Registro Mundial de Especies Marinas) no utilizan más los nombres multigénero o incluso de subgénero (Psomadakis et al., 2019; FAO, 2021; WoRMS, 2022). Por otro lado, el ITIS (Sistema Integrado de Información Taxonómica) y el BISMaL (Sistema de Información Biológica para la Vida Marina)
Fig. 1. Agrupaciones morfológicas de Penaeus s.l. utilizado en el esquema de 6 géneros de Pérez Farfante y Kensley (1997). *Surco adrostral /carina (ag) surco gastrofrontal largo /carena (gg). ** surco adrostral (ag) corto y sin surco gastrofrontal (gg). # carena gastrofrontal (gg) con el extremo posterior girando hacia adelante. Los símbolos en círculo, triángulo y cuadrado se refieren a los estados de caracteres utilizados en la Fig. 3.
aún adoptan el esquema de seis géneros (ver también Figueredo et al., 2022).
Una breve historia de Penaeus s.l. taxonomía basada en la morfología Hay 32 especies actualmente reconocidas de Penaeus s.l. [Pérez Farfante y Kensley, 1997; De Grave y Fransen, 2011; Ma et al., 2011; Tsoi et al., 2014; Tavares y Gusmão, 2016; Chan et al., 2021, con P. similis (Chanda & Bhattacharya, 2002) y P. konkani (Chanda & Bhattacharya, 2003) consideradas como inválidas, véase Ma et al., 2011]. Las 32 especies se separan en varios grupos según los surcos y carenas del cuerpo y la forma del télico o thelycum (Burkenroad, 1934; Kubo, 1949; Pérez Farfante, 1969; Tirmizi, 1971; Burukovsky, 1972; Holthuis, 1980; Dall et al., 1990; Hayashi, 1992; Pérez Farfante y Kensley, 1997; Chan, 1998; Fig. 1). Los camarones acanalados o estriados se subdividen en “acanalados” americanos por la presencia de un surco dorsolateral en el último somito abdominal o como “acanalados” en el Indo-Pacífico occidental y el Atlántico oriental por la ausencia de dicho surco. El nombre Farfantepenaeus Burukovsky, 1972 se aplicó a la especie

americana “acanalada”. El thelycum o télico en camarones acanalados de otras áreas tiene dos formas muy diferentes. El nombre Melicertus Rafinesque, 1814 se usó para aquellos con una forma general de télico, mientras que Marsupenaeus Tirmizi, 1971 se usó para aquellos con un télico en forma de bolsa. Los camarones sin ranuras se separaron en grupos con o sin carenas hepáticas. Los que carecían de carenas hepáticas fueron colocados en Fenneropenaeus Pérez Farfante, 1969. De los que tenían carenas hepáticas, algunos tienen tipos de télicas muy diferentes. Los de aguas americanas tienen el télico abierto y se les aplicó el nombre de Litopenaeus Pérez Farfante, 1969. El nombre Penaeus s.s. se restringió entonces a los camarones sin surcos del Indo-Pacífico occidental con carenas hepáticas y télicas cerradas. Entre estos caracteres morfológicos clave, un télico abierto sugiere que es ancestral y, por lo tanto, los camarones acanalados se consideran más derivados que los camarones no acanalados (Burkenroad, 1934; Pérez Farfante, 1969).
Los miembros de estos grupos, excepto
- DICIEMBRE 2022 46
Melicertus, son relativamente homogéneos desde el punto de vista morfológico. Por ejemplo, las dos especies de Marsupenaeus solo pueden distinguirse por la coloración (Tsoi et al., 2014). Los juveniles y hembras de Fenneropenaeus, compuesto por cinco especies, son muy difíciles de identificar excepto P. chinensis (Osbeck, 1765) (ver Hayashi, 1992; Chan y Yu, 1990; Chan, 1998).
Las especies del Farfantepenaeus americano (que contiene nueve especies, con una sola de ellas distribuida a ambos lados del Atlántico) y Litopenaeus (con cinco especies) se distinguen principalmente por la forma de los genitales externos. Es difícil identificar positivamente juveniles de la mayoría de las especies en estos dos grupos (ver Pérez Farfante, 1988; von Sternberg y Motoh, 1995; Teodoro et al., 2016; Timm et al., 2019). Algunos análisis cladísticos y genéticos han sugerido que algunas especies de Farfantepenaeus pueden necesitar ser “sinonimizadas” (von Sternberg y Motoh, 1995; Timm et al., 2019). Aunque las apariencias generales de las cuatro especies en Penaeus s.s. son bastante similares, un epipodio está presente en el quinto pereiópodo de dos especies, pero está ausente en las otras dos (ver Chan, 1998; Chan et al., 2021). Por otro lado, de las siete especies en Melicertus, P. plebejus Hess, 1865, P. latisulcatus Kishinouye, 1896 y P. hathor Burkenroad, 1959 son similares en apariencia (Burkenroad, 1959; Gray et al., 1983; Chan, 1998). Las otras cuatro especies de Melicertus tienen grandes diferencias morfológicas en varias partes del cuerpo (p. ej., número de dientes rostrales ventrales, surco mediano en la cresta post rostral, espinas en los pereiópodos, espinas en telson) y pueden separarse fácilmente incluso para los juveniles (ver Chan, 1998).
Estas clasificaciones de Penaeus s.l. fueron construidas por diferentes interpretaciones sobre los caracteres morfológicos sin probar vigorosamente su validez, es decir, si realmente reflejan las relaciones evolutivas de las especies. Es difícil determinar si los caracteres morfológicos son apomórficos, plesiomórficos o sinapomórficos. Los dos únicos análisis de clados (von Sternberg y Motoh, 1995; von Sternberg, 1997) sobre las relaciones entre los miembros de Penaeus s.l. siguen estrictamente argumentos anteriores (Pérez Farfante, 1969; Bauer,
1986, 1991) en la determinación de los estados pleomorfos y apomorfos de los caracteres, por lo que los resultados no son independientes sino sujetos a las mismas limitaciones. Estos autores concluyeron que un télico abierto (es decir, el grupo Litopenaeus) es el más primitivo, mientras que un télico en forma de bolsa (es decir, el grupo Marsupenaeus) es el más avanzado.
Por lo tanto, aunque los camarones con surcos representan un grupo monofilético, los camarones sin surcos comprenden un grupo parafilético con el desarrollo de carena hepática y no una sinapomorfía. Además, el Penaeus s.l. Americano (es decir, los grupos Litopenaeus y Farfantepenaeus) es polifilético y evolutivamente muy distante. El énfasis excesivo en la forma de los genitales externos como tendencia evolutiva incluso sugirió que Penaeus s.l. es parafilético (von Sternberg, 1997).
Taxonomía basada en análisis genético molecular
En general, ahora se considera que el análisis genético molecular refleja mejor las relaciones filogenéticas entre diferentes taxones, incluyendo los crustáceos decápodos (Tsang et al., 2008, 2011, 2014; Bracken et al., 2014; Yang et al., 2015; Chen et al., 2016; Liao et al., 2017, 2019; Ma et al., 2019; Wang et al., 2021). Ha habido una serie de análisis filogenéticos moleculares en Penaeus s.l. durante las últimas tres décadas (Baldwin et al., 1998; Gusma˜o et al., 2000; Maggioni et al., 2001; Lavery et al., 2004; Quan et al., 2004; Wang et al., 2004; Voloch et al., 2005, 2009; Chan et al., 2008; CaloMata et al., 2009; Ma et al., 2009, 2011; Cheng et al., 2018; Hurzaid et al., 2020; Guo et al., 2021; Katneni et al., 2021; Cronin et al., 2022). La mayoría de estos estudios sugirieron que Penaeus ss y Melicertus pueden no ser monofiléticos. Balduino et al. (1998) también indicaron que Litopenaeus era polifilético, pero esto era erróneo debido a la errónea identificación de su material (ver Lavery et al., 2004; Ma et al., 2011). También hay resultados contradictorios entre algunos análisis. Por ejemplo, Hurzaid et al. (2020) demostraron que Melicertus es monofilético, mientras que Cronin et al. (2022) sugirieron que Litopenaeus de hecho puede ser polifilético. Sin embargo, la máxima cobertura taxonómica empleada en un solo trabajo fue solo de 25 especies, y este estudio utilizó cinco marcadores moleculares que consisten en genes mitocondriales y nucleares (Hurzaid
et al., 2020). Otro análisis mitogenómico reciente incluyó solo 12 especies (Cronin et al., 2022).
Este trabajo pretende resolver las controversias taxonómicas de Penaeus s.l. mediante la reconstrucción de una filogenia robusta mediante la incorporación de una cobertura taxonómica integral y más marcadores genéticos. Incluimos todas menos una de las 32 especies conocidas de Penaeus s.l. y se usó siete marcadores (cuatro nucleares: subunidad α de la ATPasa de sodio y potasio [NaK], fosfoenolpiruvato carboxiquinasa [PEPCK], enolasa, histona 3 [H3] y tres mitocondriales: subunidad pequeña de ARN ribosomal [ARNr12S], subunidad grande ribosomal RNA [ARNr16S], subunidad de citocromo c oxidasa [COI]). Las relaciones filogenéticas proporcionan la base para establecer un esquema de clasificación natural para Penaeus s.l. que incluye algunos de los camarones económicamente más importantes.
Materiales y métodos Muestras
Este estudio abarca 31 de las 32 especies conocidas de Penaeus s.l., incluyendo nueve especies del grupo Farfantepenaeus, cinco especies del grupo Fenneropenaeus, cuatro especies del grupo Litopenaeus, dos especies del grupo Marsupenaeus, siete especies del grupo Melicertus y cuatro especies del grupo Penaeus s.s (Tabla 1). La única especie no incluida es una especie del Pacífico oriental P. occidentalis Streets, 1871 del grupo Litopenaeus. Aunque P. occidentalis es una especie pesquera en las costas orientales de América Central, los intentos de obtener material de esta especie adecuado para el análisis de ADN fracasaron y no existe una secuencia de esta especie en GenBank para los genes utilizados en este trabajo.
Los especímenes de prueba o “voucher” con secuencias recién generadas se almacenaron en la Universidad Nacional del Océano de Taiwán, Keelung (NTOU), el Museo Nacional de Historia Natural, el Instituto Smithsonian, Washington D.C. (USNM), la Universidad Internacional de Florida, Miami (HBG) y la Universidad Syiah Kuala, Banda Aceh. (FKPUSK). Según los análisis filogenéticos moleculares más extensos de Penaeidae (Ma et al., 2009; Robalino et al., 2016; Hurzaid et al., 2020), la familia se puede separar en tres tribus Parapenaeini, Penaeini (a la que
- DICIEMBRE 2022 47 PATOLOGÍA
Tabla 1. Especímenes, localidades de muestreo y números de acceso GenBank de Penaeus s.l. y especies externas utilizadas en el estudio. “*” Secuencias recién agregadas. “–” Se refiere a especies sin nueva secuencia añadida. “N.C..” Secuencia No disponible. NTOU: Universidad Nacional del Océano de Taiwán, Keelung. USNM: Museo Nacional de Historia Natural, Instituto Smithsonian, Washington D.C. HBG: Universidad Internacional de Florida, Miami. FKPUSK: Universidad Syiah Kuala, Banda Aceh.

- DICIEMBRE 2022 48 PATOLOGÍA
pertenece Penaeus s.l.) y Trachypenaeini. Se seleccionó una especie en cada tribu como grupos externos estrechamente relacionados en este estudio. Penaeopsis eduardoi Pérez Farfante, 1977, Heteropenaeus longimanus De Man, 1896 y Metapenaeus ensis De Haan, 1844, respectivamente. Además, una especie de cada una de las otras cuatro familias de la superfamilia Penaeoidea se incluyeron como grupos externos distantes. Las especies seleccionadas fueron Aristeus virilis Bate, 1881 (Aristeidae), Benthonectes filipes Smith, 1885 (Benthesicymidae), Sicyonia lancifer (Olivier, 1811) (Sicyoniidae) y Solenocera crassicornis (H. Milne Edwards, 1837) (Solenoceridae). Los especímenes “voucher” para todos los grupos externos se han almacenado en la NTOU.
Análisis de ADN
El ADN genómico se extrajo del quinto pleópodo de las muestras con el kit QIAamp DNA Micro (QIAGEN, Venlo, Países Bajos) siguiendo el protocolo del fabricante. Las secuencias de primers para la amplificación por PCR de los siete marcadores genéticos, las longitudes de las bases, las temperaturas de hibridación y las referencias de fuentes se enumeran en la Tabla S1. En general, las amplificaciones fueron realizadas en 20 μL con 40–100 ng de ADN genómico, 2 μL de 10x de tampón polimerasa, 15 mM de cloruro de magnesio (MgCl2), 2.5 mM de miX desoxirribonucleótido trifosfato (dNTPs), 3 μM de cada primer y 1 unidad de polimerasa Taq (5 U/μL; Super-Therm, Takara Bio, Kusatsu, Japón).
Los perfiles de ciclos de la PCR fueron los siguientes: 3–5 min a 95°C para la primera desnaturalización, luego 40 ciclos de 30 s a 94°C, 40–50 s a 46.5–58°C (dependiendo de los diferentes genes), 40 s a 72°C, y una extensión final de 10 min a 72°C. Después del control de calidad mediante electroforesis en gel de agarosa al 1%, los productos de la PCR se secuenciaron en un ABI 3730 analizador genético (Applied Biosystems, Center for Integrated BioSystems, Logan, UT, EE. UU.; servicio proporcionado por Mission Biotech, Taipei, Taiwán). Las secuencias se ensamblaron en contigs por SeqManPro™ (LASER-GENE®; DNASTAR; Madison, WI, EE. UU.) y se “blastearon” (Herramienta de búsqueda de alineación local básica, BLAST, Centro Nacional de Información Biotecnológica, NCBI) en GenBank para identificar la posible contaminación.
Las secuencias de genes que codifican proteínas (NaK, PEPCK, enolasa, H3 y COI) se tradujeron en las secuencias de aminoácidos correspondientes mediante EditSeq (LASERGENE®; DNASTAR) para evitar la inclusión de pseudogenes (Song et al., 2008). En este estudio se adquirieron un total de 74 secuencias (61 de Penaeus s.l.) (números de acceso OP697857-OP697868, OP697995-OP697997, OP700389OP700391, OP700401-OP700406, OP716637-OP716687) y depositados en GenBank.
Análisis de data
Además de las 75 secuencias generadas recientemente, se descargaron 200 secuencias de los genes utilizados en este trabajo del NCBI GenBank para su análisis (Tabla 1). Las secuencias de GenBank se seleccionaron eligiendo la secuencia más larga o eligiendo aleatoriamente una de las secuencias más largas de cada gen para cada especie. Aunque GenBank contiene muchas secuencias de varias especies de Penaeus s.l., muchos nombres registrados están desactualizados o mal identificados (algunos incluso pertenecen a diferentes grupos o no a Penaeus s.l.), y algunas secuencias representan pseudogenes (ver ejemplos en la Tabla S4). Por lo tanto, la mayoría de las secuencias utilizadas en este presente análisis se adquirieron de trabajos moleculares previos (Lavery et al., 2004; Tsoi et al., 2005; Ma et al., 2009, 2011; Timm et al., 2019; Hurzaid et al., 2020) con el último autor (TYC) y nuestro colaborador H. D. Bracken-Grissom (ver Agradecimiento) involucrado en la identificación de especímenes voucher. Se seleccionaron cuidadosamente otras secuencias a través de evaluaciones de resultados BLAST. En total, el conjunto de data actual consta de 275 secuencias, lo que da como resultado una ocupación de data de especies y genes del 90%. La alineación de secuencias se realizó mediante MAFFT v.7 (Katoh y Standley, 2013) utilizando la estrategia “automática”. Se usó BioEdit v.7.2.5 (Hall, 1999) para refinar manualmente la alineación de las secuencias de ARNr 12S y 16S. Las secuencias de los siete genes se concatenaron para la reconstrucción filogenética.
Se seleccionó un modelo de mejor ajuste de sustitución de ADN del set de data combinada por IQ-TREE v.2 (Minh et al., 2020) basado en
el criterio de información de Akaike corregido (AICc), y luego se utilizó para análisis filogenéticos por máxima verosimilitud (ML) usando IQ-TREE v.2 e inferencia bayesiana (BI) usando MrBayes v.3.2.6 (Ronquist et al., 2012). El análisis ML se realizó con procedimientos de arranque “Bootstrap” estándar utilizando las notaciones de partición y el máximo de “100” réplicas. Se realizaron tres BI independientes con 2 × 107 generaciones muestreadas cada 1000 generaciones, y los parámetros del modelo se aplicaron en el set de data particionado. La convergencia de cada ejecución de BI se evaluó mediante Tracer v.1.7 (Rambaut et al., 2018) y se confirmó observando la probabilidad (LnL) para decidir los periodos de sobrecalentamiento. Los valores de soporte de bootstrap de máxima verosimilitud (MLBP) > 80 y probabilidad posterior (PP) de BI 0.95 se consideraron soportes sólidos (p. ej., Golightly et al., 2022).
Para determinar si Penaeus s.l. es monofilético, la prueba imparcial (AU) (Shimodaira, 2002), la prueba de KishinoHasegawa (KH) (Hasegawa y Kishino, 1989) y la prueba de Shimodaira-Hasegawa (SH) (Shimodaira y Hasegawa, 1999; Goldman et al., 2000) se realizaron tal como se implementaron en Consel v.0.1i (Shimodaira y Hasegawa, 2001). El mismo set de data particionado basado en el modelo GTRGAMMA se ejecutó para el análisis ML en RAXML v. 7.2.6. (Stamatakis, 2006) y aplicó los siguientes algoritmos ‘-f d’ (—#200 iteraciones de árboles iniciales aleatorios) para encontrar el árbol óptimo. Se utilizó el algoritmo ‘-f g’ para estimar los puntajes de probabilidad logarítmica por sitio para estos dos árboles y luego se evaluó la significancia (si P < 0.05) con Consel.
Reconstrucción del estado ancestral Los cinco caracteres morfológicos clave propuestos por Pérez Farfante y Kensley (1997) así como por trabajos previos (ver Fig. 1) al separar Penaeus s.l. en diferentes grupos están codificados (Tablas S2, 3) para un análisis de Reconstrucción del Estado Ancestral (ASR) (Pagel, 1999) en todos los taxones del grupo interno y externo del árbol filogenético (Fig. 2) para evaluar la transición del estado del caracter en estos camarones. La máxima parsimonia y probabilidad para el análisis ASR (Figs. S3, S4) se realizó en Mesquite v.3.70 (Maddison and Maddison, 2021) que considera todas las probabilidades del estado de los caracteres
- DICIEMBRE 2022 49 PATOLOGÍA
PATOLOGÍA
durante el análisis de reconstrucción.
Resultados
Con los grupos externos, el set de data de este estudio constaba de 275 secuencias (Tabla 1, con 75 secuencias recién generadas), incluidas: 36 secuencias NaK (308–582 pb), 36 secuencias PEPCK (252–524 pb), 28 secuencias de enolasa (351 pb), 32 secuencias H3 (327 pb), 37 secuencias ARNr 12S (369–507 pb), 38 secuencias ARNr 16S (403–467 pb), 37 secuencias COIa (COIb, 514–657 pb) y 31 COIb secuencias (419–577 pb). No existió ninguna inserción o eliminación en el set de data de genes codificadores de proteínas nucleares (NaK, PEPCK, enolasa y H3) y mitocondriales (COIa y COIb). El set de data concatenado final incluía 4000 pb de 38 especies. El modelo “GTR” (Rodríguez et al., 1990) con proporción invariante, frecuencias base empíricas y distribución gamma (I+F+G4) seleccionada del set de data concatenado, se utilizó para la configuración en el análisis ML. Los árboles ML y BI resultantes tenían una topología casi idéntica, excepto por la posición de P. plebejus, que es hermano de un clado que consta de P. latisulcatus y P. hathor en el árbol ML (Fig. S1) pero forma un clado con P. longistylus Kubo, 1943 en el árbol BI (Fig. S2). El árbol filogenético combinado final presentado (Figs. 2, 3) se basa en la topología del árbol ML.
Aunque los análisis moleculares previos descubrieron relaciones filogenéticas ligeramente diferentes entre las especies de Penaeus s.l. y se han descrito más especies en la última década (Tsoi et al., 2014; Tavares y Gusmão, 2016; Chan et al., 2021), nuestro análisis molecular (Figs. 2, S1, S2) de 31 de las 32 especies conocidas hasta la fecha reafirma los resultados de Ma et al. (2011) quienes sugirieron la presencia de tres clados fuertemente relacionados en Penaeus s.l. Cada uno de estos tres clados contiene dos géneros en la clasificación de seis géneros de Pérez Farfante y Kensley (1997). En el clado Marsupenaeus/Melicertus (MLBP/ PP 100/1.0), se revela que Melicertus es parafilético y Marsupenaeus es un grupo derivado de este clado. De manera similar, en el clado Penaeus s.s./Fenneropenaeus (MLBP/PP = 99/1.0), Penaeus s.s. es parafilético con el Fenneropenaeus monofilético anidado dentro (MLBP/PP = 100/1.0). Solo uno de estos tres clados, el clado Farfantapenaeus/Litopenaeus (MLBP/ PP = 100/1.0), tiene miembros de los dos géneros recíprocamente monofiléticos (MLBP/PP = 100/1.0). Todas las relaciones anteriores tienen relacionamientos muy sólidos en los análisis de ML y BI (es decir, MLBP/PP 99–100/1.0, respectivamente). Por tanto, de los seis géneros propuestos por Pérez Farfante y Kensley (1997), sólo cuatro (Farfantapenaeus, Fenneropenaeus,

Litopenaeus, Marsupenaeus) son monofiléticos, lo que representa una agrupación natural en la clasificación. Además, especies de Penaeus s.l. constituyen un clado fuertemente respaldado (MLBP/ PP 83/0.99, Figs. 2, S1 y 2), aunque las tres pruebas de monofilia (AU, KH y SH) no pueden rechazar la hipótesis alternativa de que Penaeus s.l. no es monofilético (AU, KH 0.52; SH 0.73). Los resultados del análisis ASR de los cinco caracteres morfológicos clave utilizados para separar Penaeus s.l. en diferentes géneros por Pérez Farfante y Kensley (1997) en la Fig. 1 reveló que ninguno de ellos representa una sinapomorfía distinta (Figs. S3, S4).
Discusión
El análisis filogenético molecular más completo hasta la fecha entre todas, excepto una especie de Penaeus s.l. basado en siete marcadores genéticos (cuatro nucleares y tres mitocondriales), confirma nuevamente que dos (Penaeus s.s. y Melicertus) de los seis géneros propuestos por Pérez Farfante y Kensley (1997) no son grupos naturales (Fig. 3 primer esquema izquierdo). Aunque Marsupenaeus ahora contiene dos especies y es monofilético, este grupo está profundamente anidado dentro del grupo Melicertus. El télico en forma de bolsa en Marsupenaeus, considerado de suma importancia en la evolución de Penaeus
- DICIEMBRE 2022 50
Fig. 2. Árbol filogenético de Penaeus s.l. resuelto por un análisis de máxima similitud (IQ-TREE) basado en las secuencias combinadas de los genes NaK, PEPCK, enolasa, H3, ARNr 12S, ARNr 16S y COI.
s.l. por Pérez Farfante y Kensley’s (1997), es por lo tanto una apomorfía. Mantener a Marsupenaeus como género daría como resultado la división de Melicertus en al menos cuatro géneros más para reflejar las relaciones filogenéticas dentro del clado Marsupenaeus-Melicertus (Fig. 3). Entre los diferentes grupos de Penaeus s.l., los miembros de Melicertus presentan las mayores variaciones morfológicas que también se reflejan en su divergencia genética (Figs. 2, 3). Las cuatro especies en Penaeus s.s. se dividieron en dos grupos, con uno de ellos filogenéticamente más cercano a Fenneropenaeus. Por lo tanto, será necesario crear un nuevo género para acomodar las dos especies en este grupo (por ejemplo, P. esculentus Haswell, 1879 y P. semisulcatus De Haan, 1844, ya que la especie tipo de Penaeus es P. monodon Fabricius, 1798), o se amplía el género Fenneropenaeus para incluir estas dos especies de Penaeus s.s.
Sin embargo, morfológicamente, estas dos especies Penaeus s.s. son muy diferentes de Fenneropenaeus y no se ha encontrado ningún caracter adecuado para unirlas en un solo género y separarlas de las demás especies de Penaeus s.l. (Fig. 3, ver también Ma et al., 2011). Los análisis genéticos recientes siempre muestran a Penaeus s.l. como un grupo monofilético (Ma et al., 2011; Cheng et al., 2018; Hurzaid et al., 2020, Katneni et al., 2021; Figs. 2, 3) y esto está fuertemente respaldado por los árboles filogenéticos que se presentan (Fig. 2, S1, S2; MLBP/PP 83/0.99). Los árboles de algunos estudios genéticos más antiguos (Chan et al., 2008; Voloch et al., 2009; Ma et al., 2009) que cuestionaron la monofilia de Penaeus s.l. tienen poco sustento, aparentemente debido a la baja resolución de los marcadores de ADN utilizados. En una morfología combinada y un análisis molecular de múltiples genes que incluye fósiles, incluso se propuso un nombre
informal Agripenaeina (langostinos cultivados que adquirieren un gran tamaño corporal a pesar de las limitaciones fisiológicas de sus hábitats de aguas cálidas y poco profundas) y un clado evolutivo particular (Robalino et al., 2016). Aunque la hipótesis alternativa de un Penaeus s.l. no monofilético no puede rechazarse por completo en el presente análisis, la evidencia disponible aboga por la monofilia de Penaeus s.l.
Las clasificaciones superiores construidas artificialmente tienen que resistir la prueba del tiempo y la metodología. Con el reciente y rápido desarrollo de la tecnología molecular, la data genética se emplea ampliamente en la actualidad para probar hipótesis filogenéticas en crustáceos decápodos (Tsang et al., 2008, 2011, 2014; Bracken et al., 2014; Yang et al., 2015; Chen et al., 2016; Liao et al., 2019; Ma et al., 2019; Wang et al., 2021). Los conceptos evolutivos
Fig. 3. División de Penaeus s.l. según
(1997) [original-6-géneros] o deducidas de relaciones filogenéticas moleculares basadas en data genética disponible. Para ver el color de los grupos de especies, consulte la Fig. 1, con símbolos que representan: círculo completo = acanalada, círculo abierto = no acanalada, triángulo completo = con carena hepática, triángulo abierto = sin carena hepática, cuadrado negro = télico cerrado, cuadrado gris = télico en forma de bolsa, cuadrado abierto = télico abierto. En diferentes esquemas, el color rojo representa agrupaciones no naturales de clados parafiléticos o polifiléticos, el color negro y gris representa el clado monofilético.

- DICIEMBRE 2022 51 PATOLOGÍA
Pérez Farfante y Kensley
actuales también consideran que la divergencia genética se puede utilizar para inferir relaciones filogenéticas para evitar la interpretación errónea de caracteres morfológicos similares resultantes de una evolución convergente o paralela.
El esquema de seis géneros de Pérez Farfante y Kensley (1997) nunca ha sido respaldado por estudios filogenéticos moleculares (ver Baldwin et al., 1998; Maggioni et al., 2001; Lavery et al., 2004; Voloch et al., 2009; Ma et al., 2011; Hurzaid et al., 2020; Figs. 2, 3), lo que implica que se trata de una clasificación artificial. Estos estudios también refutan completamente la afirmación cladística (von Sternberg y Motoh, 1995; von Sternberg, 1997) de que la forma genital tiene una importancia evolutiva primordial en Penaeus s.l. Nuestro análisis de la data genética disponible de todas las especies de Penaeus s.l. menos una falsea dos de los seis géneros propuestos por Pérez Farfante y Kensley (1997). En otras palabras, Penaeus s.s. y Melicertus según lo definido por Pérez Farfante y Kensley (1997), no son válidos. Para mantener estos dos géneros, dadas las relaciones evolutivas inferidas entre camarones en este estudio, será necesario crear al menos cinco géneros más (es decir, separar Penaeus s.s. en dos géneros y Melicertus en cinco o más géneros), ¡lo que daría como resultado un total de 11 géneros en Penaeus s.l. (Fig. 3)! Dividir a los miembros de un clado en diferentes rangos taxonómicos, incluso hasta un género (o familia, etc.) para cada especie individual como el Marsupenaeus previamente definido por Pérez Farfante y Kensley (1997), pueden ser solo interpretaciones subjetivas. Los defensores recientes de la taxonomía integrada (Dayrat, 2005; Dall, 2007; Pante et al., 2015) aconsejan que la mejor manera de avanzar es implementar data de diferentes orígenes para formular clasificaciones y conclusiones taxonómicas para un mejor reflejo de la historia evolutiva. Para Penaeus s.l., se ha pensado durante mucho tiempo que tres caracteres morfológicos, como los surcos en el caparazón, la carena hepática y la forma del télico, son sinapomorfias importantes en su evolución (Fig. 1); la sinapomorfía de estos caracteres ahora está refutada por data genética y análisis ASR (Figs. 2, 3, S3, S4). El nombre Melicertus fue propuesto originalmente por Pérez Farfante (1969) para dar cabida a todos los
camarones acanalados, incluyendo todos los miembros de Farfantepenaeus. El Penaeus s.l. Americano (es decir, Farfantpenaeus y Litopenaeus), se pensaba que estaban relacionados de forma lejana, ya que incluyen camarones “acanalados” y “no acanalados”, así como miembros con télico abierto y cerrado (Fig. 1). A pesar de estas diferencias, se agrupan genéticamente en el mismo clado (MLBP/PP 100/1.0, Figs. S1, S2). Aún no se ha identificado ninguna sinapomorfía morfológica para este clado. Sin embargo, el surco dorsolateral del último somito abdominal (aunque a veces indistinto e incluso ausente en Litopenaeus, véase también Pérez Farfante y Kensley, 1997), previamente no considerado filogenéticamente importante en Penaeus s.l. (ver von Sternberg y Motoh, 1995; von Sternberg, 1997), usado para agrupar las especies “acanaladas” (ver Pérez Farfante y Kensley, 1997) se encuentra que es una apomorfía para este relativamente más derivado clado americano (Figs. 2, S3, S4). Aunque el último somito abdominal carece por completo de un surco dorsolateral en todas las demás especies de Penaeus s.l. no americanos, dos grupos externos (Metapenaeus y Heteropenaeus) tienen tal surco dorsolateral.
El télico en forma de bolsa de Marsupenaeus también se muestra como una apomorfía ya que Marsupenaeus es un clado derivado dentro de Melicertus (MLBP/PP 99/1.0, Figs. S1, S2, S3, S4). De manera similar, se revela que las dos especies (P. esculentus y P. semisulcatus) con carenas hepáticas están más estrechamente relacionadas con aquellas sin carenas hepáticas (Fenneropenaeus, que se muestra relativamente más derivada) que con otros Penaeus s.s. con carenas hepáticas (MLBP/PP 88/0.99, Figs. S1, S2). Aunque Farfantepenaeus, Fenneropenaeus, Litopenaeus y Marsupenaeus son clados respaldados por data morfológica y genética, las relaciones evolutivas de estos cuatro clados entre Penaeus s.l. en el árbol genético (Figs. 2, 3) no se ajustan al concepto de evolución de Penaeus s.l. de Pérez Farfante y Kensley (1997) (ver Figs. 2, 3 vs. von Sternberg y Motoh, 1995: Fig. 1; von Sternberg, 1997: Figs. 2, 4). Por ejemplo, se pensó que el télico abierto de Litopenaeus era ancestral en Penaeus s.l. (von Sternberg y Motoh, 1995; von
Sternberg, 1997), pero se revela claramente como un caracter derivado, igual que el télico en forma de bolsa de Marsupenaeus (Figs. 3, S3, S4). Hay varias formas de conservar todos o algunos de los nombres de géneros establecidos por Pérez Farfante y Kensley (1997) para que sigan representando grupos naturales (Fig. 3). Como Marsupenaeus es un grupo derivado dentro de Melicertus, preservando los seis nombres genéricos utilizados por Pérez Farfante y Kensley (1997) tendrá que utilizar un esquema de al menos 11 géneros como se discutió anteriormente (Fig. 3, segundo esquema a la izquierda). Otra opción, que representa un nuevo esquema de seis géneros (Fig. 3, tercer esquema izquierdo), es sinonimizar a Marsupenaeus con Melicertus, redefiniendo a Penaeus s.s. para P. monodon y P. simplex Chan, Muchlisim & Hurzaid, 2021, y erigir un nuevo género para acomodar a P. esculentus y P. semisulcatus. Aunque un sistema de seis géneros modificado de este tipo tiene soporte genético y puede definirse bien mediante caracteres morfológicos, aún no se ha encontrado sinapomorfía para los nodos más profundos (ver Lavery et al., 2004; Ma et al., 2011; Hurzaid et al., 2020).
Por lo tanto, este esquema revisado de seis géneros en realidad infiere un concepto evolutivo muy diferente al propuesto por Pérez Farfante y Kensley (1997). Otras alternativas son dividir Penaeus s.l. de acuerdo con la data molecular y usar el nombre “Melicertus” para el clado general de Melicertus (incluido Marsupenaeus) y “Penaeus” para el clado restante que no es de Melicertus (compuesto por Penaeus s.s., Fenneropenaeus, Litopenaeus y Farfantepenaeus) en un esquema de dos géneros (Fig. 3 primer esquema a la derecha). Alternativamente, el nombre “Penaeus” puede restringirse solo al clado Penaeus (incluido Penaeus ss y Fenneropenaeus) y el nombre “Litopenaeus” puede usarse para el clado Litopenaeus (compuesto por Litopenaeus y Farfantepenaeus) como lo sugiere Lavery et al. (2004) y Ma et al. (2011), dando como resultado un esquema de tres géneros (Fig. 3, segundo esquema a la derecha). De nuevo, el problema es que no se puede encontrar ningún caracter sinapomórfico para tales esquemas de dos o tres géneros. En consecuencia, un esquema de clasificación natural que divide a Penaeus s.l. basado en data morfológica y molecular
- DICIEMBRE 2022 52 PATOLOGÍA
es requerida (ver también Dall, 2007).
Es evidente que especies de Penaeus s.l. constituyen un grupo monofilético y dividirlos de acuerdo con Pérez Farfante y Kensley (1997) creará una clasificación artificial que no está respaldada por data genética. Además, todas las ideas previas sobre la evolución de caracteres (es decir, la importancia primordial de la forma genital, el “surco”, la carena hepática) en estos camarones parecen ser engañosas, mientras que las sinapomorfías para la mayoría de los clados principales (o nodos profundos) reveladas por nuestro análisis filogenético molecular aún no se han identificado (ver también Ma et al., 2011). Construir una clasificación natural, es decir, dividir Penaeus s.l. en diferentes géneros solo debe hacerse cuando se pueden encontrar caracteres morfológicos sólidos que también coincidan con la evidencia genética, por ejemplo, que cumplan el criterio de un marco taxonómico integrado. Esto es particularmente importante ya que todos los miembros de Penaeus s.l. tienen un alto significado económico y el cambio de su clasificación
debe ser muy cauteloso.
Dado que se considera que una clasificación superior refleja las relaciones evolutivas entre especies, el subgénero es un rango taxonómico formal y tiene los mismos inconvenientes que el género si no se ajusta a las agrupaciones filogenéticas. Revertir el esquema de seis géneros de Pérez Farfante y Kensley (1997) a seis subgéneros es, por lo tanto, también antinatural. De momento, manteniendo Penaeus s.l. como un solo género es el curso de acción taxonómica más satisfactoria e informativa ya que representa un esquema de clasificación natural que refleja correctamente el conocimiento actual de las relaciones evolutivas de sus miembros (es decir, un grupo monofilético estrechamente relacionado). Además, si todavía se desea separar Penaeus s.l. por las razones que sean, como las discutidas en la Fig. 3, el subgénero en lugar del género será una opción más apropiada para los diferentes grupos porque este es el enfoque menos perjudicial para los nombres de las especies de estos importantes camarones comerciales. Aunque el subgénero es

un taxón formal, usarlo en el nombre de una especie es trinominal [p. Penaeus (Litopenaeus) vannamei Boone, 1931] y puede fusionarse sin problemas con el nombre general de la especie binomial [p. Penaeus vannamei] en base de datos y literatura, y requiere muy pocos o ningún cambio en los sectores comerciales. Dado el comercio internacional a gran escala de estos camarones, subdividir Penaeus s.l. en subgéneros tendrá consecuencias prácticas mucho menos negativas para todas las partes interesadas cuando los subgéneros sean empleados o abandonados por varios usuarios simultáneamente y en diferentes períodos•
Data complementaria de este artículo se pueden encontrar en línea en https://doi.org/10.1016/j.aquculture.2022.738955 .
Declaración del autor
Conceptualización y abastecimiento de muestras, T.Y.C. y KHC; metodología y análisis, C.H.Y. y K.Y.M.; recursos, T.Y.C., C.H.Y. y K. H. C.; preparación del borrador original, T.Y.C. y C.H.Y. Todos los autores contribuyeron a la revisión del manuscrito y dieron su aprobación final para su publicación.
- DICIEMBRE 2022 PATOLOGÍA


Proliferación de dinoflagelados en camaroneras, alternativas de control
Espinoza-Ortega1 Carlos Mora-Pinargote1 Diva Aldama-Cano Cesar Molina-Poveda1*
La producción acuícola de camarón en Ecuador ha experimentado un crecimiento anual en promedio del 19% en los últimos 5 años (CNA, 2022). Un desarrollo de este tipo, caracterizado por un rápido crecimiento no está exento de desafíos entre los que destaca la necesidad de llevar a cabo seguimientos sanitarios rigurosos para asegurar principalmente la calidad del agua. Esto ha generado que los productores desarrollen de manera práctica y en base a prueba y error (empírico), protocolos de manejo en finca que los ayuden a controlar parámetros sanitarios, tales como desinfección, floculación y biorremediación en la columna de agua.

Hay que tomar en cuenta, sin embargo, que las condiciones del medio ambiente y de cultivo cambian de manera estacional con relación a los meses del año, localización geográfica y resistencia con relación con la línea genética del camarón. Dentro de los problemas de calidad de agua a los que nos enfrentamos, además de factores bióticos tales como las fluctuaciones de poblaciones bacterianas y presencia de virus, contamos también con el exceso de concentraciones de microalgas tóxicas en sistemas de cultivo de camarón.
En cultivos semi-intensivos existe una relación bien establecida entre la calidad del fitoplancton y el desarrollo del camarón (Dall et al., 1990; Llario et al., 2019). Los beneficios que aportan llevan a las granjas camaroneras a la utilización de fertilizantes con el fin de promover el crecimiento del fitoplancton. En ocasiones una adición desmedida de los fertilizantes beneficia el desarrollo de especies poco deseadas, cómo los dinoflagelados, causando los llamados “blooms” de microalgas que ponen en riesgo la producción de la piscina camaronera (Alonso-Rodríguez y Páez-Osuna, 2003).
Los dinoflagelados son protistas con flagelos pertenecientes al grupo de fitoplancton, su nombre proviene del griego “dinos” que significa girar y del latín “glagellum” que a su vez significa látigo, que describe el movimiento rotatorio propio de estos organismos. Estos organismos que no son ni plantas ni animales, pero muchos tienen características similares a las de las plantas, como la fotosíntesis, paredes que
- DICIEMBRE 2022
Autores:
Viviam Rugel
Carla Torres
Manuel
1Skretting Innovation Aquaculture Servicio Técnico Skretting Ecuador *cesar.molina@skretting.com
contienen celulosa y la síntesis de almidón como producto de almacenamiento de energía. Las características similares a las de los animales de muchos dinoflagelados incluyen fagotrofia (alimentarse de presas u huéspedes), natación rápida, manchas oculares y tricoquistes. Los dinoflagelados por su tamaño que varía de 5 a 500 µm solo se pueden ver a través de un microscopio, pero algunos de ellos que hacen colonias se podían ver claramente macroscopicamente por el color de su pigmento amarillo verdoso o rojizo.
Históricamente los dinoflagelados han sido descritos como tecados (que tienen placas de celulosa) o desnudos (sin placas). En cualquier caso, un dinoflagelado móvil típicamente tiene los siguientes rasgos característicos (Fig. 1): un surco o faja transversal que se denomina cíngulo, el cual rodea la célula y la divide en epiteca (porción anterior) e hipoteca (porción posterior). El cíngulo alberga un flagelo en forma de cinta que es responsable del movimiento giratorio durante la natación (Fig. 1A, B). Adicionalmente, otro flagelo que actúa en forma de látigo en el surco (o también llamado sulco) le proporciona el movimiento hacia adelante. La combinación de ambos movimientos da como resultado un desplazamiento rotacional mientras la célula se impulsa hacia adelante.
Los dinoflagelados son un grupo muy diverso y abundante que conforma el plancton en aguas marinas y continentales. Están presentes tanto como productores primarios cuanto como parásitos. Aproximadamente 60 especies de dinoflagelados son productores de toxinas hepatotóxicas las cuales están asociadas con la proliferación de microalgas conocidas como mareas rojas (Gómez y Moreira, 2011).
Se ha sugerido que los dinoflagelados tienen el potencial para efectuar grandes cambios a nivel ecológico, con repercusiones económicas, representando un riesgo para la producción acuícola es así cuando ingresan junto con otro tipo de fitoplancton a través de la entrada del agua e inmediatamente al encontrarse con un medio rico en nutrientes como nitrógeno y fósforo, proliferan en floraciones abundantes cuando las condiciones son favorables (Towers,
Figura 1. Ilustración de un típico dinoflagelado tecado mótil (A) Vista ventral. (B) Vista Dorsal (Basado en Carty, 1997).

2014). En la mayoría de los casos las floraciones de dinoflagelados no presentan ningún daño para los camarones; como por ejemplo se ha reportado que la formación de mareas rojas con Peridinum balechii, no afecta la supervivencia (AcevedoGonzález et al., 2010). Por otro lado, ciertas proliferaciones han mostrado ser causantes de mortalidades y la disminución del crecimiento del camarón (Alonso-Rodríguez y Páez-Osuna, 2003; Keawtawee et al., 2012). Steidinger et al. (1998) reportaron en Florida mortalidades en poblaciones silvestres de camarones Peneidos que fueron asociadas a dinoflagelados Gymnodinium pulchellum, los datos del monitoreo revelaron la presencia de altas concentraciones en el agua, así como de fracciones de compuestos neurotóxicos producidos por estos microrganismos. En Ecuador se ha reportado la presencia de dinoflagelados tóxicos como Dynophisis caudata y G. catenatum (Reyes et al., 2001) dentro de una marea roja originada por un dinoflagelado no tóxico (Gyrodinium instriatum).
En el presente articulo muestra la eficiencia de diferentes productos alternativos, no contaminantes, al sulfato de cobre para reducir concentración de dinoflagelados en las piscinas de cultivo de camarón con salinidades de 20 - 25 ppt.
Materiales y métodos
Los ensayos fueron realizados en dos
temporadas, verano e invierno. Las muestras de agua tomadas en piscinas camaroneras ubicadas en la provincia del Guayas con salinidades entre 20 - 25 ppt y temperaturas de 24 y 27 °C en promedio, fueron distribuidas en tinas de 120 litros.
Las concentraciones de dinoflagelados para este ensayo fueron determinadas de forma cuantitativa. Para el conteo de dinoflagelados se recolectó la muestra de marea roja de una de las piscinas de la camaronera la cual se la colocó en diferentes recipientes de 20 L, se homogenizó y de cada tanque se tomó para el conteo inicial una muestra inicial de 500 ml + 1 gota de Lugol con el fin de fijar las células.
Posteriormente se colocó una gota de la muestra, se dejó reposar por aproximadamente 5 minutos y se realizó el conteo de los 4 cuadrantes externos de la cámara de Neubauer con un aumento de 10X. Luego se aplicó el producto a evaluarse y finalmente, con un tiempo de espera de aproximadamente 2 horas se realizó el mismo procedimiento para el conteo final.
Un conteo antes y después de 2 horas de la aplicación de los insumos fue realizado. Los insumos usados fueron: Detergente Industrial (DI); cal viva tipo A (CaO-A) de pureza intermedia; peróxido de hidrógeno al 50% (H2O2); Sulfato de Cobre (CuSO4); tierra de diatomeas (TD); Cal viva tipo B (CaO-B ) de
57 - DICIEMBRE 2022 NUTRICIÓN
alta pureza; y dióxido de Silicio (SiO2). Un total de 3 ensayos fueron realizados con los diferentes insumos, por triplicado e incluyendo una muestra control sin adición de insumo (Tabla 1).
El primer ensayo fue realizado en invierno, a diferentes dosis y concentraciones de dinoflagelados (cel./ml) con condiciones de aireación. Los dos ensayos restantes fueron realizados en verano y sin aireación.
Los ensayos detallados en la Tabla 1 fueron realizados con diferentes concentraciones de dinoflagelados, el primero de ellos con 120 000 células/ml, el segundo con 84 000 células/ml y el ensayo final con 400 000 células/ml. De todas las pruebas realizadas, solamente el experimento 1 tuvo aireación debido a que se realizó en invierno y se simularon las condiciones de camaronera en esta época.
Resultados y Discusión
Caso 1: Ensayo llevado a cabo en invierno con aireación.
Los resultados de la aplicación de los diferentes insumos sobre la concentración de dinoflagelado se detallan en la Figura 3. En este ensayo, con una carga de 120 000 células/ml, el mayor porcentaje de reducción de dinoflagelados (100%) se consiguió usando 6 kg/ha sulfato de cobre (CuSO4), mientras que el segundo tratamiento más efectivo fue el peróxido de Hidrógeno (H2O2 a 8 l/ha), con un porcentaje de reducción del 85% (Figura 1). La cal viva CaO-A dosificada a razón de 125 kg/ha tuvo un menor efecto que los anteriores pero siguió siendo superior al detergente industrial y al uso de tierras de diatomeas como se observa en la Figura 3. Al adicionar al agua detergente industrial (DI) equivalente a 1 kg/ha y en otro tanque tierra de diatomeas (TD) una dosis de 125 kg/ha se pudo cuantificar una reducción del 62% y 59%, respetivamente. El control que no fue tratado con nada, como se esperaba, tuvo una disminución natural del 17%.

Caso 2 Ensayo llevado a cabo en verano sin aireación
En el segundo ensayo la carga inicial de dinoflagelados fue de 84 000 células/ml, que al término de 2 horas de la aplicación se observó una reducción >96% con óxido de calcio (CaO-B), peróxido de hidrógeno y
Figura 2. Diagrama que muestra la secuencia de realización de los ensayos de los diferentes insumos para el control de dinoflagelados.

Tabla 1. Se presentan los tres ensayos consecutivos y las dosis de los insumos usados en cada prueba para la reducción de la carga de dinoflagelados.
Ensayo DI (kg/ha) CaO-A (kg/ha) H2O2 (l/ha) CuSO4 (kg/ha) TD (kg/ha) CaO-B (kg/ha) SiO2 (l/ha)
1 1 125 8 6 125 -2 1 125 8 6 125 125 10 3 2 250 16 12 250 250 20
TD=tierra de diatomeas DI=detergente industrial
Figura 3. Concentración inicial (línea entrecortada en azul intenso), final (barras celestes) y reducción porcentual de dinoflagelados (números dentro de las barras) por adición de diferentes insumos a distintas concentraciones.
sulfato de cobre (CuSO4) dosificados a razón 125 kg, 8 l y 6 kg, respectivamente por el equivalente a una hectárea.
En contraste, el detergente industrial (DI) a 1 kg/ha, CaO-A (125 kg/ha), dióxido de silicio (SiO2) a 10 kg/ha y tierra de diatomeas (TD) a 125 kg/ha tuvieron un pobre efecto sobre la población de dinoflagelados, llegando a un valor que, siendo mayor al control, no sobrepasó el 40% de reducción (Fig. 4).
Caso 3 Ensayo llevado a cabo en verano sin aireación a doble dosis de los insumos
En tercer ensayo (Fig. 5) con 400 000 células/ ml y adicionando el doble de cantidades de
insumos, se logró reducir a 84 000 células/ ml equivalente al 21% de la concentración inicial de dinoflagelados aplicando 250 kg/ ha óxido de calcio (CaO-B), mientras que usando 12 kg/ha sulfato de cobre (CuSO4) se redujo a 96 000 células/ml es decir sobrevivió un 24% de la población inicial de dinoflagelados.
Con el uso de peróxido de hidrógeno (H2O2) a razón de 16 l/ha se alcanzó una reducción de 52%. Adicionalmente 250 kg/ha Cal viva (CaO-A) bajó la carga en un 48%, mientras que 2 kg/ha detergente industrial (DI) logró eliminar el 21%. Finalmente 20 kg/ ha dióxido de silicio (SiO2) redujo el 4%
- DICIEMBRE 2022 58 NUTRICIÓN
de dinoflagelados. En el recipiente control como era de esperarse hubo una reducción mínima del 1%.
El camarón blanco L. vannamei requiere de seguimientos sanitarios constantes, principalmente aquellos referentes a la calidad del agua. Para ello muchas fincas han establecido en base a su propia experiencia protocolos prácticos de desinfección, floculación y biorremediación. Sin embargo, a medida que el cultivo avanza, las condiciones del medio acuícola cambian volviéndose más desafiantes, acentuándose los efectos según la temporada del año.
A pesar de haber tenido la mayor tasa de reducción de dinoflagelados, el uso excesivo y constante de sulfato de cobre (CuSO4.5H2O) tiene efectos negativos en el ecosistema. Al ser un alguicida va a provocar la reducción de otras especies como las diatomeas, daño a especies silvestres (Scotto, 2019) y al mismo camarón dependiendo del pH de agua. A bajo pH, se incrementa la solubilidad del cobre y por ende la concentración en el agua favorece una alta toxicidad para el fitoplancton, pero con el riesgo de también afectar al camarón. Yeh et al. (2004) han reportado que el sulfato de cobre disminuye el conteo total de hemocitos, la actividad de fenoloxidasa, la actividad fagocítica y la eficiencia de eliminación en L. vannamei volviendo susceptible al Vibrio alginoliticus.
De los compuestos que han sido usados como alternativas al sulfato de cobre, el agua oxigenada o peróxido de hidrógeno (H2O2) constituye una alternativa promisoria cuya efectividad se basa en la producción radicales que tienen un efecto en las paredes celulares de los microorganismos por la oxidación de las proteínas, lípidos y DNA (Fan et al., 2013).
El peróxido de hidrógeno no solo puede destruir la viabilidad celular sino también ha mostrado potencial algistático afectando la integridad de las células y la densidad poblacional en cianobacterias a causa de la lisis que produce en la membrana.
Es muy posible que el rápido consumo del peróxido de hidrógeno por parte de compuestos orgánicos disueltos deje menos oxidante residual disponible para producir
lisis en las células y que su acción pudiera ralentizarse. Aunque el Peróxido es una alternativa prometedora comparada con el sulfato de cobre, su manejo y su precio podrían ser limitantes en ciertos escenarios (Fan et al., 2013).


El óxido de calcio también ha sido usado
como un mecanismo para controlar el fitoplancton. El óxido de calcio al ponerse en contacto con el agua de la piscina en lugar de disolverse como se esperaría reacciona para formar hidróxido de calcio, y es el hidróxido de calcio formado el que se disocia en calcio y dos iones de hidroxilo (OH-) tiene un efecto inmediato en la calidad del agua. Aumenta
Figura 4. Concentración inicial (línea entrecortada), final (barras celestes) y reducción porcentual de dinoflagelados (números dentro de la barra) por dosificación de los diferentes productos a distintas concentraciones. Realizada en verano sin aireación con una concentración inicial de 84 000 cel./ml
Figura 5. Concentración inicial (azul intenso), Concentración final (celeste) y reducción porcentual (números dentro de las barras) de dinoflagelados por adición de diferentes productos a distintas concentraciones. (Conteo inicial de dinoflagelados: 400 000 cel./ml).
59 - DICIEMBRE 2022 NUTRICIÓN
el pH, reduce el fósforo soluble y el dióxido de carbono lo que limita la fotosíntesis del fitoplancton. El aumento del pH hace que precipite las partículas suspendidas y el fitoplancton lo que baja su concentración en el agua. Este insumo es de bajo costo si se compara con el sulfato de cobre y el peróxido de hidrógeno, a la vez que es efectivo y de fácil aplicación.
En la tabla 2 se presenta la comparación costo beneficio con relación a los precios del insumo vs la reducción de cantidad de dinoflagelados.
Las reducciones de dinoflagelados no son necesariamente proporcionales a las dosis de los insumos usados (Tabla 2). Una de las principales razones de este hecho es la carga inicial de dinoflagelados, que es distinta para cada caso de estudio. En los dos primeros estudios la carga inicial es de aproximadamente 102 000 células/ ml mientras que en el estudio 3 esta carga se cuadruplica (400 000 células/ml). A más de ello, otras variables que también influyeron para que las disminuciones no sean proporcionales a la concentración del insumo fueron las distintas condiciones ambientales entre casos de estudio, por ejemplo, la temperatura y la aireación que varió entre invierno y verano.
Para una carga de dinoflagelados en un rango de 84 000-120 000 células/ml (Casos 1 y 2) un resultado muy similar de reducción fue encontrado (96-100%) aplicando las dosis indicadas en la Tabla 2. Sin embargo, cuando la carga subió a 400 000 células/ml, el porcentaje de reducción de dinoflagelados disminuyó considerablemente (Tabla 3), esto se explica porque la carga de células aumentó 4 veces pasando de 102 000 hasta 400 000 células/ml, mientras que la dosis se incrementó solamente al doble. Los resultados indican sin embargo que a medida que se incrementa la carga de dinoflagelados, el porcentaje de efectividad de los insumos se ve reducido.
Al ponderar los promedios de los tres casos de estudios para los tres insumos evaluados se confirma que los dos mejores tratamientos para reducir la población de dinoflagelados son el sulfato de cobre y oxido de calcio B (Tabla 3). Los costos por hectárea del sulfato de cobre son los más altos (Tabla
Tabla 2. Comparación costo-beneficio con relación a los precios del insumo vs el promedio de reducción de cantidad de dinoflagelados.
Reducción (%) de dinoflagelados
Producto
Cantidad /ha Precio Producto Costo/ha
Sulfato de Cobre 125 kg/ha $ 4,80/kg $600 96,43 Sulfato de Cobre 125 kg/ha $ 4,80/kg $600 75,83 Sulfato de Cobre 250 kg/ha $ 4,80/kg $1.200 84,50 Peróxido de hidrogeno 8 l/ha $ 1,40/l $11 96,13 Peróxido de hidrogeno 8 l/ha $ 1,40/l $11 51,67 Peróxido de hidrogeno 16 l/ha $ 1,40/l $77 97,02 Oxido de Calcio (CaO-B) 125 kg/ha $0,21/kg $26 78,68 Oxido de Calcio (CaO-B) 250 kg/ha $0,21/kg $53
100
Tabla 3. Promedio ponderado de la reducción de dinoflagelados (%) en los tres casos de estudio.
Caso de estudio
Promedio ponderado (%) * 1 99,72 2 96,44 3 74,54
Producto
Promedio ponderado (%) *
Sulfato de cobre 87,01
Peróxido de Hidrógeno 60,02 Óxido de Calcio B 85,71
*Media ponderada tomando los precios como “pesos” para el cálculo. 2) en todos los casos estudiados. Aunque este compuesto mostró una considerable eficiencia en el rango de 84 000-120 000 células/ml, su utilización es una solución no idónea y poco sostenible, lo cual constituye una limitante mayor, además su costo no justifica la aplicación a la dosis estudiada.
El peróxido de hidrógeno en concentración de 84 000 células/ml parece ser una buena alternativa, sin embargo, si la carga se incremente a 120 000 células/ml, no existe una reducción considerable de dinoflagelados. Si la carga es aún mayor (400 000 células /ml), la eficiencia de este insumo se reduce todavía más.
Bajo las condiciones en que se desarrolló este estudio, el óxido de calcio B mostró ser la alternativa más costo-eficiente inclusive a la más alta carga de dinoflagelados (400 000 células/ml) ensayado, debido a que demostró ser el que causo la mayor reducción con el menor costo siendo a su vez ambientalmente más sostenibles. Adicionalmente, desde un punto de vista práctico, su aplicación debería realizarse en la etapa inicial de la floración de dinoflagelados cuando las densidades celulares son bajas para disminuir la liberación de metabolitos intracelulares•
Bibliografía
Acevedo-González, A., Siqueiros-Beltrones, D.A., Gárate-Lizárraga, I., 2010. Dinoflagellates in shrimp culture ponds under typical production conditions. CICIMAR Oceánides 25, 83–88. https://doi.org/10.37543/ oceanides.v25i1.83
Alonso-Rodríguez, R., Páez-Osuna, F., 2003. Nutrients, phytoplankton and harmful algal blooms in shrimp ponds: A review with special reference to the situation in the Gulf of California. Aquaculture 219, 317–336. https:// doi.org/10.1016/S0044-8486(02)00509-4
Carty, S. (1997). In J. Wehr y R. Sheath (Eds.), Freshwater Algae of North America (p. 687).
CNA Estadísticas, 2022 https://www.cna-ecuador.com/estadisticas/ Accesado 14/11/2022
Dall, W. H. B. J., Hill, J., Rothlisberg, P. C., Sharples, D. J., Blaxter, J. H., y Southward, A. J. (1990). Advances in marine biology. Academic pressKeawtawee, T., Fukami, K., Songsangjinda, P., Muangyao, P., 2012.
Nutrient, phytoplankton and harmful algal blooms in the shrimp culture ponds in Thailand. Kuroshio Science 5, 129–136.
Fan, J., Ho, L., Hobson, P., y Brookes, J. (2013). Evaluating the effectiveness of copper sulphate, chlorine, potassium permanganate, hydrogen peroxide and ozone on cyanobacterial cell integrity. Water Research. https://doi.org/10.1016/j.watres.2013.05.057
FAO (Organización de las Naciones Unidas para la Alimentación y la Agricultura). (2022). WORLD FISHERIES AND AQUACULTURE.
Gómez, F., y Moreira, D. (2011). Avances en el estudio de los dinoflagelados ( Dinophyceae ) con la filogenia molecular Advances on the study of dinoflagellates ( Dinophyceae ) with the molecular phylogeny, 21(3), 343–364.
Llario, F., Rodilla, M., Escrivá, J., Falco, S., Sebastiá-Frasquet, M.T., 2019. Phytoplankton evolution during the creation of a biofloc system for shrimp culture. International Journal of Environmental Science and Technology 16, 211–222. https://doi.org/10.1007/s13762-018-1655-5
Reyes, E., Krauss, E., Barniol, R., Espin, M., Intriago, P., 2001.
Gymnodinium catenatum, Microalga Tóxica aislada en la costa ecuatoriana y sus efectos sobre larvas de Litopenaeus vannamei 2–3. https://doi.org/10.13140/RG.2.1.2592.0405
Scotto, C., 2019. Ciencia y Desarrollo. 22, 49–57.
Steidinger, K.A., Landsberg, J.H., Truby, E.W., Roberts, B.S., 1998. First report of Gymnodinium Pulchellum (Dinophyceae) In North America and associated fish kills in the indian river, Florida. 437, 431–437.
Towers, L., 2014. Harmful Effects on Toxin Harmful Effects on Toxin Dinoflagellates in Shrimp Culture Ponds. thefishsite.com.
Yeh, S.-T., Liu, Ch.-H., Chen, J.-Ch. 2004. Effect of copper sulfate on the immune response and susceptibility to Vibrio alginolyticus in the white shrimp Litopenaeus vannamei. Fish & Shellfish Immunology 17: 437-446.
- DICIEMBRE 2022 60 NUTRICIÓN

Capacidad de carga de las piscinas camaroneras
Autor: John A. Hargreaves, Ph.D. Consultor del Consejo Exportador de Soya de Estados Unidos (USSEC por sus siglas en inglés)
jamezquita@ct.ussec.org
El espectacular aumento de producción de camarón en el Ecuador en los últimos años, acompañado de un aumento en la tecnificación de la producción de las piscinas, plantea interrogantes sobre límites. ¿Cuáles son los límites de producción de las piscinas grandes que se utilizan típicamente en el cultivo de camarón en el país? ¿Cuántas camaroneras se pueden construir y operar en un área en particular? ¿Qué es una trayectoria sostenible de crecimiento para la industria?

La capacidad de carga de piscinas para camarón se puede definir como el número máximo (o biomasa) de camarón que se puede mantener en una piscina dentro de los límites de los recursos naturales disponibles y los servicios ecosistémicos, sin causar algún cambio inaceptable en la calidad del agua. Este concepto implica que un factor limitante en la piscina impone algún tipo de resistencia ambiental —generalmente la disponibilidad de oxígeno disuelto— que limita aumentos adicionales en el número o la biomasa de camarón que pueda soportar. La capacidad de carga se puede definir en términos de densidad máxima de siembra, densidad de biomasa o tasa de alimentación diaria.
La decisión sobre la densidad de siembra es una de las más importantes que toman los productores de camarón porque afecta la calidad del agua, el crecimiento, la salud, la supervivencia y la producción. Algunas de las consideraciones al seleccionar una densidad de siembra incluyen la disponibilidad y las características de la infraestructura (piscinas), la variación estacional, el rendimiento histórico del piscinas, la experiencia del productor y la capacidad de carga del piscinas.
El aumento de la densidad de siembra ejerce presión sobre el entorno del piscinas. A medida que aumenta la densidad de siembra, cambia la calidad del entorno del piscinas (agua y suelo). Con una densidad de siembra baja, la calidad del agua y del suelo es buena y se encuentra en niveles seguros que se encuentran por encima de los umbrales críticos. En cierta densidad de siembra que depende de factores específicos del sitio, la calidad ambiental del piscinas cambia rápidamente alcanzando un
- DICIEMBRE 2022 PRODUCCIÓN
62
punto de inflexión, un nivel máximo más allá del cual la calidad ambiental se deteriora rápidamente a niveles que causan estrés y producción ineficiente.
Los factores de estrés como la baja concentración de oxígeno disuelto, las altas concentraciones de nitrito y sulfuro, y las fluctuaciones de temperatura y pH pueden causar efectos en la inmunocompetencia y, por lo tanto, en la supervivencia, reducción del apetito que afecta la tasa de crecimiento y reducción de la digestibilidad de los alimentos, lo que resulta en una mayor tasa de conversión alimenticia, reduciendo colectivamente el rendimiento y rentabilidad.
A una muy baja densidad de siembra, el principal factor que limita la capacidad de carga es la disponibilidad de alimentos naturales.
A los que se suministra alimento, el factor que probablemente limite la capacidad de carga es la concentración de oxígeno disuelto. En particular, el principal desafío ingenieril asociado con el suministro de oxígeno en piscinas para camarón es el transportar oxígeno desde la superficie, donde es generado por la fotosíntesis de las algas o agregado por aireación mecánica, al fondo de la piscina donde se encuentran los camarones con mayor frecuencia. A medida que aumenta la densidad de siembra, la capacidad de carga podría aumentar gradualmente, mientras se aplique tecnología e insumos desde fuera de la piscina hasta que surjan nuevos factores distintos al oxígeno que limiten esa capacidad de carga.
Se ha demostrado repetidamente que la concentración de oxígeno disuelto es el principal factor que limita la producción de camarón en piscinas semiintensivas e intensivos. La tasa de respiración máxima del camarón —un índice de crecimiento potencial—, es de aproximadamente 6 mg/L. Por lo tanto, a cualquier concentración de oxígeno disuelto inferior a este nivel máximo, el potencial de crecimiento del camarón se reduce correspondientemente porque el camarón se adapta al nivel más bajo de oxígeno disuelto al reducir la tasa de respiración. Por esta razón, muchos productores de camarón en Asia proporcionan altos niveles de aireación mecánica para mantener continuamente la
concentración de oxígeno disuelto en niveles altos. En las piscinas de camarón eutróficos, la concentración de oxígeno disuelto fluctúa ampliamente entre el día y la noche en respuesta a la fotosíntesis de las algas y la respiración de toda la biota en el piscinas. Las condiciones fluctuantes actúan como un factor de estrés para el camarón y, en última instancia, reducen su supervivencia. Es necesario una calidad de agua estable con concentraciones de oxígeno disuelto de alrededor de 5-6 mg/L para maximizar el potencial de crecimiento y hacer un uso eficiente del alimento.
La decisión de construir piscinas grandes (de 5 a 10 ha) que son muy comunes en Ecuador, es una decisión racional basada en los costos de construcción. El costo de construcción de piscinas grandes por hectárea es menor que el de las piscinas pequeños. La relación entre el área de superficie de agua y el área de tierra ocupada también es mayor en piscinas grandes. Una de las ventajas y desventajas asociadas con el uso de piscinas grandes es el sacrificio en cierto grado del manejo y control de la calidad del agua y otros aspectos de la producción, lo que lleva a una menor capacidad de carga que las piscinas más pequeñas.
Una piscina grande de camarón “normal” sembrada a 10-15/m2 sin aireación tiene una capacidad de carga de alrededor de 1500-2500 lb/ha. Mediante la adición de aireación a 2-4 hp/ha, la capacidad de carga puede alcanzar 3500-4500 lb/ha. El aumento de la densidad de siembra en alrededor de 25/m2, con aireación a 2-4 hp/ha y otros componentes de tecnificación (piscinas de cría, comederos automáticos, mejora genética, alimentos de alta calidad), puede resultar en una capacidad de carga del piscinas de 5,500-8,800 lb/ha. El límite superior para piscinas grandes sembrados a 25-30/m2 es probablemente de alrededor de 10,000 lb/ha, pero esto requiere aireación continua a 5-6 hp/ha y tasas de recambio de agua de alrededor de 10-20% por día en la última parte del ciclo de engorde. Es técnicamente posible lograr una capacidad de carga de 13,000 a 14,000 lb/ha con una aireación continua a 10 hp/ha, pero la eficiencia de este nivel de producción es cuestionable. Los valores de la tabla representan resultados empíricos obtenidos
en condiciones prácticas en camaroneras comerciales (Tabla 1).
Para niveles de producción de 10,00015,000 lb/ha, es mejor invertir en modificar la infraestructura del piscinas para reducir el tamaño del piscinas a 1-2 ha, que tratar de forzar la capacidad de carga a este nivel en piscinas grandes. Los rendimientos promedio de los cultivos en otros importantes países productores de camarón —India (7,600 lb/ha), Vietnam (12,300 lb/ha), Tailandia (16,200 lb/ha) e Indonesia (22,000 lb/ha)— se obtienen de piscinas que generalmente son < 1 ha. La intensificación también conduce a aumentos en la eficiencia del uso de la tierra, el agua y la energía.
En piscinas de 5 a 10 ha con comederos automáticos, el piscinas se puede concebir como un piscinas intensivo-extensivo combinado con zonas de alimentación relativamente pequeñas rodeadas de áreas extensas mucho más grandes para el tratamiento de residuos.
La capacidad de carga puede aumentar porque la alta frecuencia de alimentación significa que la carga de residuos se distribuye a un nivel más bajo, pero durante un período más largo durante el día, lo que permite que los procesos naturales de las piscinas se mantengan al día con la carga de residuos. En piscinas con alimentadores automáticos, es probable que el suministro de oxígeno disuelto a la zona de alimentación sea el factor limitante, por lo que es importante el número, la ubicación y el funcionamiento de dispositivos mecánicos de aireación. Se necesita más trabajo para optimizar la gestión de la calidad del agua en las zonas de alimentación. La capacidad de carga en piscinas con comederos automáticos se puede expresar en términos de comederos por hectárea y biomasa por comedero.
Con respecto a las ventajas y desventajas asociadas con la selección del tamaño del piscinas, la consideración principal es el costo de construcción, que es mucho menor para piscinas más grandes. Las piscinas más pequeños, particularmente aquellos con liners, permiten un mayor control sobre la calidad del agua, particularmente la concentración de oxígeno disuelto, que en las piscinas grandes. Con suficiente
- DICIEMBRE 2022 63 PRODUCCIÓN
aireación, las concentraciones de oxígeno disuelto de 5-6 mg/L pueden mantenerse continuamente, maximizando el potencial de crecimiento y minimizando el estrés. Sin embargo, una alta densidad de siembra implica altas tasas de alimentación.
El manejo de la carga de residuos producidos por la alimentación en piscinas pequeños, principalmente manteniendo limpio el fondo de las piscinas, con bajas concentraciones de materia orgánica, es una práctica de importancia crítica para limitar las enfermedades causadas por patógenos oportunistas como Vibrio
Mirando más allá del nivel de las piscinas individual, ampliándose ahora al nivel de sector o región, el concepto de capacidad de carga puede extenderse para estimar el número máximo de camaroneras en un área en particular, considerando que múltiples camaroneras en un área tienen impactos acumulativos.
Esto es particularmente cierto en áreas donde varias camaroneras toman y descargan agua de la misma fuente. En tales áreas, la calidad del agua que abastece a las fincas que están lejos de la desembocadura de un canal estuarino podría verse muy afectada, con densas concentraciones de fitoplancton y baja concentración de oxígeno disuelto. En dichos lugares, no hay aumento en la capacidad de carga asociada al uso de esta agua para el recambio de agua. La recirculación interna a nivel de finca es una mejor opción en este caso. El recambio de agua puede ser beneficioso solo si la calidad del agua en el canal del estuario es mejor que la calidad del agua dentro de la finca camaronera•
Tabla 1: Capacidad de carga de piscinas de 5-10 ha bajo varias condiciones.
Productividad Densidad de siembra Aireación Comentario (lb/ha) (PL/m2) (hp/ha) 2000 10-15 0 piscina de productividad "normal" 2500-2800 10-15 0 piscina de mejor productividad 3500-4500 15 2-4 Ecuador - promedio 6600 límite máximo G1 (McIntosh) 5500-8800 20-25 2-4 Ecuador - mejor 7700 30-50 2-6 Brazil - mejor 8800-10,000 17-20 4 aireación continua 8800-11,000 25-30 5-6 aireación continua (10,000) 13,000-14,000 >25 10 aireación continua

Tabla 2: Productividad promedio por ciclo de producción en varios países camaroneros. La productividad en países distintos al Ecuador se obtiene en piscinas generalmente < 1 ha.
Densidad de siembra Tasa de aireación Horas de aireación Productividad País (nu./m2) (hp/ha) (hr/d) (lb/ha)
Ecuador 21 10 8 4,300 India 38 16 18 7,600 Vietnam 55 24 14 12,300 Thailand 77 43 19 16,200 Indonesia 92 - - 22,000
Para más información sobre este artículo escriba a: jamezquita@ct.ussec.org

- DICIEMBRE 2022 64 PRODUCCIÓN


Eficiencia
del uso de salvado vegetal en sistemas de fertilización simbiótico sobre la calidad del agua y la composición del zooplancton en la fase de cría de Litopenaeus vannamei

Actualmente, el uso de salvado vegetal en la fertilización de cultivos intensivos de camarón es una estrategia que ha sido destacada entre los principales países productores de camarón de Asia y América Latina (Deepak et al., 2020; Khanjani et al., 2022). En este sistema, denominado simbiótico, la fuente de carbono orgánico exógeno procesado por microorganismos probióticos crea un ambiente con condiciones similares a las de un estuario, propiciando el crecimiento de una alta carga de microorganismos, mejorando la calidad del agua y sirviendo como fuente suplementaria de alimento para el camarón (Romano, 2017; Kawahigashi, 2018).
El uso del sistema simbiótico ha sido estudiado en las fases de cría y engorde, mostrando resultados satisfactorios para la calidad del agua y el crecimiento del camarón (Katalani, 2020; Santos, 2020; De
Autores:
Otávio Augusto Lacerda Ferreira Pimentel ¹ Wilson Wasielesky Jr ² Natália Pereira da Silva ¹ Bianca de Oliveira Ramiro ¹ Lucélia do Valle Borges ² Dariano Krummenauer ¹*
1 Laboratorio de Ecología de Microorganismos Aplicada a la Acuicultura, Instituto de Oceanografía, Universidad Federal de Río Grande, Río Grande, Brasil; 2 Laboratorio de Cultivo de Camarón Marino, Instituto de Oceanografía, Universidad Federal de Río Grande, Río Grande, Brasil. darianok@gmail.com
67
Oliveira et al., 2022; Oliveira et al., 2022; Pimentel et al., 2022). Esto se debe a la composición nutricional de alta calidad de la fuente de carbono, que se mejora a través del proceso de fermentación y respiración de los microorganismos (Romano et al., 2018). Este sistema se puede utilizar de forma complementaria al sistema biofloc (BFT), ya que ayuda en el desarrollo del bucle microbiano sin necesidad de manipular la relación carbono:nitrógeno (C:N) (Deepak et al., 2020). Sin embargo, aún no se ha realizado un estudio comparativo de la comunidad microbiana de los dos sistemas.
A pesar de los efectos positivos en varios aspectos del uso del sistema simbiótico, hasta ahora los estudios han utilizado diferentes estrategias de fertilización, con diferentes salvados vegetales como fuente de carbono orgánico (p. ej., salvado de trigo y salvado de arroz) y diferentes concentraciones de probióticos. La falta de consenso entre los estudios hace necesario estandarizar un protocolo de fertilización para este sistema. Por lo tanto, el objetivo de este estudio fue evaluar el uso de diferentes salvados vegetales como fuente de carbono orgánico en el sistema simbiótico sobre la calidad del agua, la composición de la comunidad de zooplancton y el crecimiento de Litopenaeus vannamei en la fase de cría.
Métodos
Se realizó una fase de cría durante 53 días, en unidades experimentales de 50L (Figura 1, a), en la Estación Marina de Acuicultura de la Universidad Federal de Río Grande, Brasil. Se sembraron postlarvas de L. vannamei, con un peso inicial de 0.03g, a una densidad de 2000 camarones m-³ y se alimentaron con un alimento comercial de 40% de proteína cruda. Se establecieron los siguientes tratamientos, con cinco repeticiones cada uno: CW - agua clara (control), BFT - sistema biofloc, RB - salvado de arroz, WT - salvado de trigo y SB - salvado de soya.

Los tratamientos que utilizaron salvado vegetal como fuente de carbono orgánico fueron inicialmente fertilizados con 8 aplicaciones del fertilizante durante 17 días. Durante el tiempo experimental se realizaron 15 aplicaciones diarias del fertilizante siguiendo metodología adaptada de
Figura 1. Unidades experimentales (a) y siembra (b)
diferentes salvados vegetales.
Tabla 1. Composición de los fertilizantes utilizados durante la preparación del agua y en el tiempo experimental.
Preparación Experimento
Salvado vegetal (< 300 µm; g m-³) 30 10 Probiótico (g m-³) 0.15 0.05 Melaza (g m-³) 3 1 Bicarbonato de sodio (g m-³) 3 1 Agua de mar (× cantidad de salvado) 10 10
Kawahigashi (2018) y Pimentel et al. (2022). La composición del fertilizante utilizado en la preparación inicial del agua y durante el experimento se describió en la tabla 1.
Los fertilizantes fueron procesados por una fase sin aireación (24h) y una fase con aireación (24h). Pasado este tiempo, se aplicaron en las unidades experimentales.
En el tratamiento BFT se utilizó melaza como fuente de carbono orgánico, manteniendo una relación C:N de 15:1 según Avnimelech (1999) y Ebeling et al. (2006). En este tratamiento se utilizó un inóculo con una
concentración final de 5 mg L-¹ de sólidos suspendidos totales. En los tratamientos BFT y AC, se aplicó probiótico comercial (INVE Aquaculture, Sanolife PRO-W) a las unidades experimentales los días 7 y 14 a una concentración de 0.35 g m-³ para que todos los tratamientos recibieran la misma cantidad de probiótico.
La temperatura del agua y el oxígeno disuelto se registraron diariamente y la salinidad se registró semanalmente. El nitrógeno amoniacal total (TAN; mg L-¹) y el nitrito (NO2--N; mg L-¹) se analizaron diariamente. En el tratamiento AC se renueva el agua
- DICIEMBRE 2022 68 NUTRICIÓN
de L. vannamei con sistema simbiótico utilizando
diariamente en un 90% del volumen útil de la unidad experimental. Cuando fue necesario, se realizaron cambios de agua para mantener la concentración de nitritos por debajo del nivel seguro para el camarón. Al finalizar el tiempo experimental, se tomaron muestras de agua del cultivo para cuantificar e identificar los principales grupos de microorganismos zooplanctónicos presentes en el sistema, de acuerdo con Utermöhl (1958).

Resultados y discusión
Al final del experimento, el peso medio de los animales en los tratamientos osciló entre 2.6 y 3.2 g (Figura 2, a), y la supervivencia fue superior al 85% (Figura 2, b) en todos los tratamientos. Estos resultados muestran que las diferentes estrategias de fertilización no limitaron el crecimiento del camarón en sistemas intensivos (Figura 3).
Durante el tiempo experimental, la temperatura promedio fue cercana a los 28 °C, el oxígeno disuelto promedio estuvo por encima de los 5 mg L-¹ y la salinidad promedio fue de 33 g L-¹. En cuanto al proceso de nitrificación, se observó el control y estabilización del nitrógeno amoniacal total a partir del día 15 del tiempo experimental, en todos los tratamientos, excepto en el tratamiento CW donde se realizaron recambios de agua diarios para mantener estables las condiciones de calidad del agua (Figura 4, a).
Esto probablemente se debió al establecimiento de bacterias oxidantes de amonio (AOB), que son responsables de la oxidación del amoníaco a nitrito (Samocha, 2019). El nitrito se controló a partir del día 40 del tiempo experimental (Figura 4, b), en todos los tratamientos. Esto puede explicarse por el desarrollo de la comunidad de bacterias oxidantes de nitrito (NOB) en el sistema, que son responsables de la oxidación de nitrito a nitrato (Samocha, 2019). Los patrones de compuestos nitrogenados a lo largo del período experimental fueron similares a los que se observan para un sistema de cultivo intensivo de camarón recién iniciado (Samocha, 2019).

El uso del sistema simbiótico proporciona un medio de cultivo rico en nutrientes con condiciones favorables para el
2. Peso final (a) y supervivencia
simbiótico utilizando diferentes salvados
RB: salvado de arroz, WB: salvado de trigo y SB: salvado de soya.
69 - DICIEMBRE 2022 NUTRICIÓN
Figura
(b) de juveniles de L. vannamei cultivados en un sistema
vegetales. CW: agua clara (control), BFT: sistema biofloc,
Figura 3. Juveniles de L. vannamei producidos al final de la fase de cría utilizando diferentes salvados vegetales.
rápido crecimiento de microorganismos, mimetizando un sistema natural (Romano, 2017). En este estudio, al finalizar el tiempo experimental, se observó una gran cantidad de microorganismos protozoarios como flagelados y ciliados (Figura 5).
En cuanto a la composición nutricional de estos microorganismos, los flagelados y ciliados tienen una alta cantidad de ácidos grasos poliinsaturados (PUFA) (Fernandes da Silva, 2008). Además, los ciliados funcionan como indicadores de la calidad del agua (Decamp et al., 1999). También se observó la presencia de rotíferos y nemátodos en el agua, lo que indica el desarrollo del ciclo microbiano del sistema y similar al tratamiento donde se utilizó el sistema BFT. La presencia de estos microorganismos en el sistema puede influir positivamente en el crecimiento del camarón, ya que actúan como una fuente suplementaria de alimento, junto con los flóculos microbianos que crecen.
Conclusión
Las diferentes estrategias de fertilización no limitaron el crecimiento del camarón en la fase de cría. El uso de salvado vegetal como fuente de carbono orgánico para la fertilización simbiótica también proporciona el desarrollo de la comunidad de bacterias nitrificantes.
Los resultados se parecen a los que se observan en un sistema recién iniciado. Asimismo, el uso de salvado vegetal permite el crecimiento de microorganismos que pueden actuar como fuente suplementaria de alimento para el camarón que se está produciendo• Para más información sobre este artículo escriba a: darianok@gmail.com
Figura 4. Concentración de nitrógeno amoniacal total (a) y nitrito (b) durante la cría de L. vannamei utilizando un sistema simbiótico con diferentes salvados vegetales. CW: agua clara (control), BFT: sistema biofloc, RB: salvado de arroz, WB: salvado de trigo y SB: salvado de soya.

Figura 5. Abundancia relativa (%) de microorganismos zooplanctónicos al final de la fase de cría de L. vannamei utilizando sistema simbiótico con diferentes salvados vegetales. CW: agua clara (control), BFT: sistema biofloc, RB: salvado de arroz, WB: salvado de trigo y SB: salvado de soya.

- DICIEMBRE 2022 70 NUTRICIÓN

Mejores prácticas tecnológicas en transformación digital: automatización de procesos contables y financieros en las empresas ecuatorianas
Este artículo analiza y evidencia la importancia y relevancia del apoyo de las plataformas de tecnología para un mejor desempeño y desarrollo de una empresa, sobre todo, en las Pymes en Ecuador, las cuales son el motor de la economía del país.
La pandemia aceleró los procesos de transformación digital en las empresas y, la necesidad de incorporar plataformas tecnológicas para automatizar procesos internos y facilitar la interacción con los clientes.
Es importante destacar que la adquisición de tecnología empresarial sugiere beneficios efectivos a mediano y largo plazo, dado que el 70% de los líderes empresariales globales toman decisiones significativas basadas en datos financieros inexactos; mientras que, el 55% de los profesionales de finanzas no confían en su capacidad para detectar errores antes de informar los resultados.
Cabe señalar que las cifras de adquisición de plataformas tecnológicas pospandemia demuestran que, el 17 % de las empresas se ha enfocado en sistemas de planificación de recursos empresariales (ERP en inglés) y automatización robótica de procesos (RPA en inglés), seguido de web software (14%), software de procesos de venta (CRM) (5%), intranet (5%) o chatbot (2%), lo que indica que los directivos son cada vez más conscientes de que la tecnología juega un papel súper importante para operar de forma más organizada y lograr mayor productividad.
Análisis
En el Ecuador el 77% de sus más grandes empresas, son empresas familiares. Y si se contabiliza con las PYMES, este porcentaje sube hasta el 95%. Con el cuidado y dedicación de la familia, estos negocios prosperan y quedan como herencia para las nuevas generaciones, de ahí que, las empresas que han sabido adaptarse o mantenerse, se
convierten en grandes empresas de éxito, como es el caso de Industrial Pesquera Santa Priscila, Agripac, Telconet, Grupasa, Tecnova, Solubles Instantáneos, Hivimar e Inverneg (El Universo, 2020).
La tecnología juega un papel sumamente importante para transformarse de una empresa familiar pequeña a una gran empresa. Además, tomando en cuenta la dinámica acelerada del mercado, es necesario realizar cambios fundamentales, como invertir en tecnología y equipos de desarrollo, que permitan mejorar los procesos y el acceso a la información, aportando más valor a la compañía, para desarrollarse a un nivel igual o mayor que el de sus competidores, y de esta forma poder alcanzar mayor participación en el mercado. Para garantizar el crecimiento de una organización se vuelve indispensable la aplicación de ¨mejores prácticas de tecnología¨, donde se optimicen operaciones, se adopten tendencias innovadoras, se modernicen procesos y alineen con los objetivos de negocio.
La tecnología ofrece una de las mejores oportunidades de economía para las empresas, más allá de la digitalización de archivos y documentos para reducir el uso de hojas de papel, la transformación digital en el ámbito laboral permite cortar gastos superfluos que proporcionan poco o ningún resultado.

Una buena práctica tecnológica involucra procesos, estructuras e instrumentos de participación, que siempre van en función de lograr y alcanzar una mejora continua empresarial. El enfoque de este artículo va dirigido principalmente a la automatización de procesos contables y financieros.
Los elementos necesarios para una transformación digital se componen de una visión estratégica y clara sobre qué necesita la organización, a dónde y cómo llegar a esos
- DICIEMBRE 2022 TECNOLOGÍA 72
Autores: Daira Ávila Joseph Merchán hola@corporacionaldia.com
objetivos, además, de otros factores como la cultura organizacional, el involucramiento de las áreas de IT en las decisiones estratégicas y el compromiso de la alta dirección.
La importancia que tiene la transformación digital en los diversos procesos para las pymes, es el acompañamiento de los profesionales en los procesos de cambio tecnológico que pasa por implementar de manera coherente las estrategias de acuerdo al modelo de negocio, teniendo en cuenta criterios de prioridad, metas y presupuestos. Por lo tanto, hablamos de un cambio continuo y permanente que impulsa a la evolución de estos negocios y con una nueva lógica para entender el mundo que nos rodea.
Dentro de una organización, el manejo de la información constituye una parte crucial para el desarrollo de las distintas actividades empresariales y representa la base en la toma de decisiones gerenciales, la transformación digital es la hoja de ruta que se debe seguir para dar continuidad y permanencia de una empresa en el mercado global donde su foco principal es el cliente.
“La transformación digital es una estrategia organizacional o empresarial para impulsar una cultura y mentalidad continua y sistemática, con el objeto de poner a la organización a servicio de los clientes, empleados y accionistas, utilizando para ello herramientas digitales y una serie de metodologías y mejores prácticas que conllevan inexorablemente a una nueva experiencia y forma de trabajar en la denominada era o economía digital”. (StrateDigital, 2022)
La transformación digital, bien hecha, optimiza y transforma el negocio de una empresa. Las empresas deben aspirar a un retorno de la inversión de los esfuerzos de transformación digital impulsados por las mejoras de las prácticas actuales y por un cambio más radical. (Gartner)
Con la transformación digital hay otras formas de trabajo, un software de recursos empresariales como un ejemplo de las nuevas prácticas ágiles en las operaciones de IT y desarrollo de productos, las mismas que empujan nuevas formas de trabajo y de la cultura en las organizaciones.

“La situación actual que atraviesa el mundo exige a los gobiernos intensificar el uso de las tecnologías digitales para hacer frente a la emergencia e impulsar la reactivación económica. En este contexto, acelerar la transformación digital del país es una decisión política fundamental para la nueva convivencia que se está impulsando en este gobierno”.
Entre los beneficios principales de aplicar una plataforma tecnológica dentro de una empresa están: menos inversión inicial y menos riesgo, se reducen los costos, actualizaciones y nuevas funcionalidades inmediatas, dando como resultado que la empresa centre sus esfuerzos en su negocio, tenga mayor disponibilidad y seguridad de los datos.
Hoy en día, hay tecnologías que están impulsando de una forma acelerada a las empresas para la transformación financiera – contable, desplazando la forma tradicional de efectuar las tareas rutinarias de contabilidad.
Y es que, ante los constantes cambios del mercado, las tendencias e innovaciones tecnológicas y una mayor exigencia por parte de los clientes, las empresas necesitan reducir las tareas que toman demasiado tiempo y recursos para seguir siendo competitivas.
El camino de la automatización de procesos parece ser inevitable en los negocios. Por lo que, el uso de un software para automatización de procesos trae consigo una gran cantidad de ventajas para la empresa.
Resultados
En Ecuador, las empresas familiares representan un 40% del valor agregado bruto (VAB) de la economía, emplean a más del 90% de la población económicamente activa (PEA) y representan el 91% del total de empresas privadas formales del país, según el estudio Policy Report: “Empresas Familiares en Ecuador” realizado por la Universidad de Especialidades Espíritu Santo (UEES).
Las pymes en el Ecuador representan el 63% de las empresas exportadoras ecuatorianas, estas contribuyen enormemente en la
- DICIEMBRE
TECNOLOGÍA
2022
73
generación del PIB y el empleo del país, generando aproximadamente unos 250.000 puestos de trabajo.
Las empresas de Ecuador comenzaron a invertir en transformación digital, pero solo para mejorar su productividad y ser más competitivas, sin pensar en nuevos modelos de negocio que les generen nuevos ingresos, según una encuesta publicada en septiembre del 2022 por la consultora PwC. De acuerdo a este sondeo, elaborado por la consultora a 55 empresas ecuatorianas que forman parte de su base de clientes, el 32% ve la necesidad de invertir en transformación digital para mejorar la productividad, el 23% por competitividad y el 16% para reducir costos.
Sin embargo, en el caso de Ecuador, según esta encuesta, el 29% de las empresas encuestadas invierten menos del 1% de sus ventas en tecnología, cuando el rango ideal, según el especialista, es de entre 2,5% y 3%.
Entre las empresas que invirtieron en transformación digital en los 2 últimos años, el 17 % se enfocó en sistemas de planificación de recursos empresariales (ERP en inglés) y automatización robótica de procesos (RPA en inglés), seguido de web software (14%), software de procesos de venta (CRM) (5%), intranet (5%) o chatbot (2%).

En la actualidad nueve de cada 10 pymes en Ecuador está invirtiendo en su desarrollo tecnológico. Así lo señala el estudio ‘Impacto del COVID-19 en pymes: aceleración digital y
cambio de paradigma’, de la multinacional de servicios tecnológicos Microsoft. (Primicias. ec)
La más reciente encuesta sobre las restricciones crediticias de pymes realizada por el Banco Mundial (2017) constata las importantes diferencias en el acceso al crédito que enfrentan las pymes en los países de medios y bajos ingresos respecto a aquellas en países de altos ingresos.
Frente a esta realidad, a una gran mayoría de las empresas les resulta difícil mejorar sus sistemas de producción y su tecnificación.
Un mayor desarrollo de las pymes en Ecuador, y Latinoamérica, también depende de las acciones y las inversiones que hagan los gobiernos y el sector privado para mejorar la infraestructura, sostiene el Banco de Desarrollo de América Latina (CAF). (Primicias.ec)
El estudio ‘Visión pymes 2020, perspectivas sobre tecnología y negocios’, de la firma Brother International Corporation, revela que, el 28% de las Pymes en Ecuador, asegura que ha obtenido recursos del sistema financiero, bancos y cooperativas. El 12% dice que ha accedido a ayudas de gremios y el 10% lo ha hecho del Gobierno. En cambio, el 40% de los pequeños negocios dice que no ha obtenido apoyo, lo que ha llevado a una priorización del ahorro ante una eventual crisis. (Ekos)
El último estudio de la compañía española, Accenture, ‘Da el salto, ¡y lidera! (Make the
Leap, Take the Lead)’, realizado a principios de 2021, apunta que las compañías denominadas “líderes” en innovación tecnológica han incrementado sus ingresos cinco veces más rápido que las “rezagadas”, según la media de los últimos tres años (El Español, 2021).
Todos los niveles jerárquicos de una empresa pueden verse beneficiados con la implementación de una solución tecnológica, ya que cada uno, dentro de su nivel de responsabilidad, debe tomar decisiones que contribuyan al desempeño global.
Según estudios realizados por diferentes organismos existen 16,000 pymes en Ecuador (Fuente: Ekos). Las cuales están divididas entre empresas de manufactura (15%), Servicios (36%), Comercio (18%) y otros. (Fuente: Ekos, 2016) De ellas menos del 15% cuentan con una Solución ERP.
Cuando una empresa analiza en cuanto a la mejora tecnológica, por lo general, las soluciones más nombradas corresponden a productos internacionales, los cuales son desarrollados con estándares locales y adaptados a la normativa local, lo cual genera un incremento en sus precios y un tiempo de espera más largo.
Las mejores decisiones de empresa se han orientado a la incorporación de herramientas tecnológicas dirigidas a:
Automatizar o hacer reingenierías a los procesos habituales de la empresa con
- DICIEMBRE 2022 74 TECNOLOGÍA
Fuente: Microsoft • PRIMICIAS
incorporación de tecnología.
Sistematizar o en caso de ya tener un sistema, cambiarlo si se considera necesario, de acuerdo al nivel en que se encuentre la empresa.
Actualizar los programas informáticos y adquirir equipos modernos que requieran menos mantenimiento.
La información arrojada por las herramientas tecnológicas, para la automatización de procesos contables y financieros, es clave para decidir estratégicamente sobre temas de alto impacto para las finanzas del negocio. Este tipo de automatización optimiza también los datos y sistemas financieros, reduciendo el potencial de error humano.

La automatización permite a las empresas proporcionar información oportuna a las partes interesadas clave. Esta información les ayuda a tomar mejores decisiones y reducir el riesgo. Los procesos de contabilidad manual pueden llevar demasiado tiempo y consumir
Tenencia de crédito por país, según tamaño de la empresa y edad
demasiada capacidad. Evitando la toma de decisiones rápida y precisa.
Para ilustrarlo mejor, cabe indicar que el 70% de los líderes empresariales globales toman decisiones significativas basadas en datos financieros inexactos. Mientras tanto, el 55% de los profesionales de finanzas no confían

en su capacidad para detectar errores antes de informar los resultados. (dynamopymes. com) Además, hay estudios que demuestran que, la automatización de procesos contables puede reducir el coste del procesamiento de facturas en un 75% (Teknei).
La automatización de algunas de las
- DICIEMBRE 2022 TECNOLOGÍA
principales actividades contables significa que los especialistas en contabilidad pueden centrarse en tareas más importantes. Por ejemplo, el software de contabilidad computarizado puede procesar datos y producir hojas automáticamente. El software avanzado puede proporcionar un fácil acceso a las tendencias del mercado y las proyecciones futuras. (dynamopymes.com)
Discusión
Las Pymes en Ecuador están atravesando, quizás, una de las etapas más duras de su vida empresarial, sumado a ello muchas de ellas no estaban preparadas para asumir la coyuntura digital repentina a consecuencia del COVID-19.
Más que un tema tecnológico, que, sí es importante, debemos colocar primero a la gente y la cultura de las personas. La transformación es un tema de liderazgo y cultura digital. (itmadrid.com)
Cada organización tiene la capacidad de beneficiarse de la transformación digital, en mayor o menor medida, sin embargo, es importante resaltar que cada empresa debe realizarla tomando en cuenta sus circunstancias o situaciones particulares. Según Gartner, la mayoría de las empresas todavía no tienen políticas que manejen la evaluación y el uso de SaaS.
La aplicación de Business Intelligence permite identificar al instante los retos que enfrenta la empresa, accediendo a información actualizada, lo que finalmente logra que la empresa sea más competitiva, al reaccionar con mayor rapidez y confianza ante los cambios.
Con la pandemia ha quedado demostrada la imperiosa necesidad de trabajar de manera conectada y más ágil. Precisamente la digitalización de la empresa implica trabajar de forma colaborativa y cooperativa conectados en la nube.
Las empresas familiares ecuatorianas son la columna vertebral de la economía, no pueden posponer más su transformación digital si quieren continuar compitiendo en un mercado cambiante y cada vez más exigente.
En Ecuador se ha visto un incremento de adopción de este tipo de soluciones tecnológicas, las cuales se encuentran principalmente en las grandes empresas, no obstante, algunas de ellas podrían ser de gran utilidad para todo tipo de empresas, incluyendo a las pymes.
Recomendaciones
Un ERP (Enterprise Resource Planning) les permite a las empresas en crecimiento tomar el control total cada uno de sus procesos de negocio a través de sus distintos módulos. Además, existen software ERP que se ajustan a las características y necesidades de los pequeños y medianos negocios.
Los sistemas ERP son herramientas de productividad que han ayudado a empresas que las han implementado a llevar un nuevo nivel de integración y de facilidad al usarlo. Todas estas herramientas son útiles para el éxito de una compañía. Entre sus principales ventajas podemos destacar la posibilidad de compartir datos por toda la empresa, así como extender las mejores prácticas y difundir el conocimiento a lo largo de la organización.
Conclusión
Finalmente, una buena práctica es una intervención que se ha implementado con resultados positivos contribuyendo a una mejora o solución de problemas que sirvan de ejemplo de comportamientos exitosos que aportan valor y ayudan al crecimiento del negocio.
Las empresas ecuatorianas de hoy, deben responder a los desafíos, haciendo uso de herramientas que les permita optimizar recursos, ahorrar dinero, y generar ingresos, de manera que, se pueda tener una mejor gestión, retroalimentación y oportunidades de mejora continua.
Los sistemas ERP surgen por la necesidad de tener integrada la información entre las diferentes áreas de la compañía. Y, a pesar que, los proveedores son los facilitadores de la transformación digital, el negocio es el que tiene que transformarse.
Uno de los principales elementos que retrasan la incorporación de tecnología en las
pequeñas y medianas empresas del Ecuador, se reduce al tema de costos; sin embargo, vale la pena ahondar en las recomendaciones que al respecto hacen expertos en negocios, y revisar las estadísticas de varios estudios realizados en el país.
Las medianas empresas han demostrado necesitar sistemas personalizados para manejar sus cuentas, pagos y facturas, por lo que en Ecuador ha quedado demostrado que los sistemas, para la automatización de procesos contables y financieros, ocupan los primeros lugares en la demanda nacional, dado que son herramientas que además de la automatización del área, ofrecen ventajas de gestión documental, inteligencia de negocios, datos en tiempo real y la generación inmediata de reportes.
Coincidentemente con la finalización de este artículo, hemos evidenciado con la implementación exitosa de nuestra plataforma de ERP, la transformación generada en dos empresas importantes que operan en nuestro país. La una, es una multinacional que elabora productos para la terapia de aromas y otros negocios relacionados con el bienestar de las personas; y la otra, una cadena de cafeterías y reposterías. En ambos casos, tenemos la evidencia de una mejora importante en los controles, en la agilización y simplificación de los procesos, en la elaboración de informes contables y financieros, y reportes gerenciales, que les está permitiendo la visualización óptima para la toma de decisiones•
Para más información sobre este artículo escriba a: hola@corporacionaldia.com
- DICIEMBRE 2022 76 TECNOLOGÍA

TECNOLOGÍA PORTÁTIL NO INTRUSIVA
para el control de seguridad a la carga y el contenedor
 Autores: Evelynne Calle Christian Reyes cargosurveys@marsurveyor.com
Autores: Evelynne Calle Christian Reyes cargosurveys@marsurveyor.com
78
Ecuador se ha convertido en un líder a nivel mundial de producción y exportación de camarón, de acuerdo con cifras en el período del 2002 al 2011 se refleja en promedio en crecimiento anual del 15%, en consecuencia, los últimos 10 años (2012 al 2021) la taza subió al 17%. Según el informe estadístico de la Cámara de Acuacultura.
El camarón ecuatoriano llega a más de 50 destinos en el mundo y este crecimiento en las exportaciones ha conllevado a optimizar su trazabilidad y sus recursos logísticos hasta llegar a diversos mercados internacionales.
Actualmente, una de las necesidades en temas de seguridad se centra en dos puntos muy importantes para el sector camaronero; el primero es el robo en vías durante el trayecto que van desde la planta de embarque hacia las empacadoras o a los diferentes puertos del país; el otro no menos importante es lidiar con la incertidumbre de la contaminación con sustancias sometidas a control por ser ilícitas (drogas) que es donde el gobierno está asentando mayor énfasis en buscar soluciones tecnológicas para mitigar este problema.
Por el puerto de Guayaquil (terminales públicas y privadas) se moviliza más del 85% de la carga de exportación no petrolera del país y, se transporta hacia los diferentes mercados del mundo como China, Japón, Perú, Chile, India, Argentina, Estados Unidos, entre otros. Sus principales productos son: banano, camarón, madera, piña, atún en conserva, minerales, cacao y otros. Según el sitio oficial del Ministerio de Transporte y Obras Públicas.
Ecuador está ubicado en una zona productora de hoja de coca, pues limita con Colombia y Perú considerados por la Organización de las Naciones Unidas ONU como los principales países dedicados a la siembra del arbusto de coca, por lo tanto, este aspecto necesariamente genera que en esta zona se realicen actividades para la producción, refinamiento y comercialización tanto local como internacional de este tipo de alcaloide.
Una “autopista de la cocaína hacia Estados Unidos y Europa”. Así definió a Ecuador el portal especializado InsightCrime, apuntando al hecho de que más de un tercio de la creciente producción de cocaína en Colombia llega a Ecuador y desde los puertos ecuatorianos sale principalmente rumbo a EE. UU. y Europa.
Las cifras sobre el decomiso de sustancias ilícitas, la creciente delincuencia y las luchas internas de carteles en el territorio ecuatoriano han llevado no solo a que las exportadoras mejoren sus procesos de exportación volviéndolos más seguros y minimizando el riesgo de contaminación, sino también que el Presidente Guillermo Lasso firmara en octubre de 2021 el Decreto Ejecutivo 227, mediante el cual otorgó 12 meses de plazo para la instalación de los escáneres en los Terminales Portuarios del país.
Con estos antecedentes la implementación de tecnologías no intrusivas; como la portátil toma fuerza no sólo en puertos, sino también en depósitos, patios Check Point y en las plantas donde

TECNOLOGÍA 79
TECNOLOGÍA
se carga el producto.
La tecnología de reconocimiento no intrusivo (Detección de anomalías) como los equipos de imagen de rayos X permiten tener una imagen de la carga de un contenedor, medio de transporte, unidad de carga sin la necesidad de abrirlo y descargarlo.
En combinación con una estrategia de intervención coordinada esto puede ayudar a reducir de manera significativa el número de reconocimientos físicos innecesarios y disminuir el tiempo que toma realizarlos.
La Norma 3 del Pilar I del Marco de Normas SAFE de la Organización Mundial de Aduana OMA avala la tecnología de reconocimiento no intrusivo NII para la facilitación del comercio y recomienda a las administraciones aduaneras que el equipo de reconocimiento no intrusivo esté disponible y se utilice para efectuar reconocimientos, en los casos en que esté disponible y de acuerdo con la evaluación de riesgo.
Las instalaciones principales de la NII se colocan en el inmueble, tienen un alto grado de penetración y permiten a los medios de transporte pasar a través de ellos, lo que acelera el proceso y reduce el tiempo total del reconocimiento. Para asegurar la instalación y la aplicación adecuada de la tecnología NII, la OMA desarrolló directrices NII que ayudarán a las administraciones aduaneras a optimizar el uso de esta tecnología para el beneficio tanto del control como de la facilitación.
Ecuador ya cuenta con esta tecnología de sistema de retrodispersión; se trata de un avance tecnológico en la creación de imágenes a través del uso de rayos X. Las máquinas tradicionales detectan materiales duros y blandos por la variación en la intensidad de los rayos gamma transmitidos a través del objetivo, comúnmente estas máquinas cuentan con emisor (generador) y un receptor (detector); con el cual, para obtener una imagen o radiografía, el objetivo debe ubicarse en medio de ambos.

Por el contrario, los rayos X de retrodispersión detectan la radiación que se refleja desde el objetivo. Es decir, detecta y lee la radiación que se encuentra en la superficie del objetivo
permitiendo crear una imagen con los residuos de radiación presentes en el cuerpo. Tiene aplicaciones potenciales donde se requiere un examen menos destructivo y se puede operar incluso si solo un lado del objetivo está disponible para el examen.
Este tipo de métodos de imágenes de cuerpo completo se han utilizado para realizar escaneos de pasajeros para aerolíneas con el objetivo de detectar armas ocultas, herramientas, líquidos, narcóticos, dinero y otro contrabando.
Los equipos con sistema de retrodispersión fueron desarrollados en el año 2014 única y exclusivamente para uso militar en Estados Unidos; actualmente se conocen ya en campo otras aplicaciones debido a su versatilidad y potencial; tales como: uso veterinario, seguridad física, entre ellas una de las más conocidas la inspección no intrusiva, que se efectúan con estas máquinas de rayos X (Escáner) o rayos gamma que permite el reconocimiento de la carga sin la necesidad de abrir el medio de transporte

para descargarla, sin afectar los rangos de temperatura en contenedores cargados, y en contenedores vacíos la posibilidad de revisar el interior dentro de cavidades usualmente usadas para negocios ilícitos. Incluso se ha encontrado la aplicación para verificar que las reparaciones en los contenedores sean las adecuadas y no afecten a la refrigeración del mismo.
Amigable con el ambiente y su operador
Al hablar de rayos X; la idea principal que surge, es si éste puede causar o repercutir en la salud del operador, en la carga o en el ambiente.
El ser humano recibe constantemente radiaciones ionizantes, los rayos X son una de las fuentes más conocidas, pero las radiaciones ionizantes se producen de forma natural en el mundo en el que vivimos, la radiación cósmica procedente de otras estrellas y el material radiactivo del entorno, como el potasio de los plátanos. Es decir que como seres humanos
- DICIEMBRE 2022 80
estamos constantemente expuestos a estas radiaciones, la importancia aquí radica en el tiempo de exposición. Para ilustrar, detallamos un par de ejemplos:
•Una radiografía de tórax equivale a 1000 µrem,
•Comer 1000 bananas de un solo bocado es equivalente a 1 radiografía de tórax, •1 hora continua de uso para estos equipos que cuentan con sistema de retrodispersión equivale a comer 5 bananas.

La unidad de medida para indicar la peligrosidad de una radiación, sus dimensiones son energía sobre masa, al igual que el sievert (Sv), la unidad admitida en el Sistema Internacional de Unidades(SI), y su equivalencia es 1 Sv = 100 rem.)
Características de estos equipos manuales

Los escáneres portátiles que funcionan con el sistema de retrodispersión tienen un peso que oscila entre los 4 y 6 kg, en algunos casos, como el PX1 cuentan con una pantalla táctil integrada y conectividad a internet.
Actualmente han alcanzado niveles de penetración > 8 mm de espesor en acero, por otra parte es importante destacar este hecho porque hace poco más de cinco años solo se llegaba a tener 5 mm de penetración; lo que evidencia un gran avance en estos equipos. Al ser de tipo portátil, funcionan con baterías recargables e intercambiables lo que permite el uso continuo del escáner.
Estos equipos de rayos X tienen un recubrimiento y diseño especial que hace que la fuga de radiación sea mínima, sin afectación al medioambiente o su operador.
Algunas características técnicas del escáner modelo PX1 que cuenta con sistema de retrodispersión:
Especificaciones del equipo
•Fuente de poder: 140 keV
•Penetración de acero: > 7 mm
Dimensión y peso del escáner
•Largo: 21.1 cm (8.3 in.)
•Ancho: 28.2 cm (11.1 in.)
•Altura: 18.5 cm (7.3 in.)
•Peso: 4.3 kg (9.5 lbs)
Tiempo de operación
•Batería: 6 horas
•Tiempo de carga de la batería: 4 horas
Sistema operativo
•Software del sistema: Android, versión actual
•Interfaz de usuario multilingüe
Medioambiente
•Temperatura de funcionamiento: -20 °C a 60 °C
•(- 4 °F a 140 °F)
•Temperatura de almacenamiento: de -40 °C a 60 °C (de -40 °F a 158 °F)
•Operable en: Lluvia, nieve, vientos fuertes y altitudes de hasta 4.500 m (14.764 pies) nominalmente
- DICIEMBRE 2022 81 TECNOLOGÍA
Velocidad de escaneo
•Hasta 30 cm por segundo; 15 cm por segundo (velocidad de escaneo nominal para una relación de imagen de escaneo a objeto de escaneo de 1:1)
Características del sistema
•Capacidad de detección en imagen de plomo
•Capacidad de detección en profundidad mediante el detector y la óptica Videray


•Dimensiones compactas

•Conectividad remota con cualquier dispositivo (PC, MAC, iOs y Android)

•Pantalla táctil de 7”
•Sencillas actualizaciones por aire (OTA)
Láseres de línea para perfilar mejor el área de escaneado
Aplicación en otros países de la región En la actualidad esta tecnología se encuentra presente en más de 60 países donde estos equipos (escáner portátil) se utilizan en pasos fronterizos, para transporte de carga, aduanas, recintos carcelarios, entre otros.

Solo en Estados Unidos llevan más de 10 años trabajando y mejorando el uso de sistemas portátiles de rayos X que permitan una eficacia del 100% al detectar en tiempo y espacios dificiles de acceder cualquier tipo de amenazas que atenten a la integridad del bien común.
Las ventajas que ofrece su tamaño y portabilidad permiten que sean trasladados a cualquier punto que desee ser inspeccionado, sean estos transportes, estructuras, oficina, carga.
Se prevé que en poco tiempo estos equipos serán canalizados para usos médicos tanto para el ser humano como uso veterinario, por su baja emisión de radiación se estarían por certificar bajo normas regulatorias para iniciar pruebas en el campo de la medicina.
Uso para control antinarcóticos
Inicialmente el uso de estos equipos fueron diseñados para uso militar en los Estados Unidos, pero así como la tecnología avanza, muchas de las herramientas que en su momento fueron para uso militar, se aplican ahora en el día a día, para no retroceder mucho en el tiempo dos ejemplos claros son los drones y los robots con sensores; equipos diseñados para estrategias militares para pruebas en guerra y reconocimiento, se aplican hoy en sectores de la agricultura, ganadería, pesca entre otros.
Es así que los equipos portátiles de rayos X, también fueron desbloqueados para un uso civil, que permita agilitar procesos en varios campos del día a día.
Recomendaciones
El proceso de revisar los contendores y cargas con los equipos portátiles ya se realizan de forma más rutinaria en las ciudades del país, debido a que permite revisar la carga antes de ser exportada, teniendo un alto porcentaje de eficacia en la revisión de la estructura para luego ser cargado con el producto.
Conclusiones
Requisa: Cocaína Cantidad: 10 kilos Lugar: Tennessee
Fuerza
La implementación de este tipo de tecnología para el control y seguridad en cualquier punto de la cadena de exportación es de vital importancia para disminuir el riesgo de contaminación en la estructura y la carga del contenedor. Además de las revisiones al ingreso y salida de los terminales portuarios porque también se debe identificar en que punto fue contaminado. Tecnología disponible que se convierta en una herramienta alternativa para combatir la contaminación de la carga y las implicaciones legales que esto conlleva•
Bibliografía Fuente: https://www.primicias.ec/noticias/economia/puertos-detalles-escaneo-carga-ecuador/ (Fuente página Naciones Unidas)
- DICIEMBRE 2022 82 TECNOLOGÍA
policial: Nuestro cliente de Tennessee descubrió 10 kilos de cocaína escondidos en un vehículo durante un control de tráfico con ayuda de nuestro instrumento. Ver imágenes adjuntas. Gran trabajo de todos, especialmente porque era su segundo día usando el instrumento.
ESTADÍSTICAS ÍNDICE

Edición 150 - Diciembre 2022 84 88 92 Exportaciones de camarón y tilapia Reporte de mercado de EE. UU. Reporte de mercado de China
COMERCIO EXTERIOR
CAMARÓN: EVOLUCIÓN DE EXPORTACIONES 2010 -2021


Fuente: Banco Central del Ecuador
Elaborado por: Cámara Nacional de Acuacultura
CAMARÓN: COMPARATIVO MENSUAL (Millones de Libras) 2020 - 2022
Fuente: Estadistic S.A.
Elaborado por: Cámara Nacional de Acuacultura
- DICIEMBRE 2022 84
ESTADÍSTICAS
COMERCIO EXTERIOR

CAMARÓN: PARTICIPACIÓN POR DESTINO (Libras)
Fuente: Estadistic S.A.
Elaborado por: Cámara Nacional de Acuacultura
CAMARÓN: PRINCIPALES PAÍSES DESTINOS DE EXPORTACIÓN (Millones de Libras)

Fuente: Estadistic S.A.
Elaborado por: Cámara Nacional de Acuacultura
- DICIEMBRE 2022 85 ESTADÍSTICAS
COMERCIO EXTERIOR
CAMARÓN: EXPORTACIONES POR PARTIDA ARANCELARIA
Enero – Octubre 2022
Fuente: Banco Central del Ecuador
Elaborado por: Cámara Nacional de Acuacultura
CAMARÓN: EVOLUCIÓN DEL PRECIO PROMEDIO ANUAL DE EXPORTACIÓN (Libras)


Fuente: Estadistic S.A.
Elaborado por: Cámara Nacional de Acuacultura
CAMARÓN: EVOLUCIÓN DEL PRECIO PROMEDIO MENSUAL DE EXPORTACIÓN (Libras)

Fuente: Estadistic S.A.
Elaborado por: Cámara Nacional de Acuacultura
- DICIEMBRE 2022 86
ESTADÍSTICAS
COMERCIO EXTERIOR
TILAPIA: EVOLUCIÓN DE EXPORTACIONES MENSUALES A EE. UU.

Fuente: National Oceanic and Atmospheric Administration - NOAA Elaborado por: Cámara Nacional de Acuacultura
TILAPIA: EVOLUCIÓN DEL PRECIO PROMEDIO MENSUAL DE EXPORTACIÓN A EE. UU. (Libras)
Fuente: National Oceanic and Atmospheric Administration - NOAA Elaborado por: Cámara Nacional de Acuacultura

- DICIEMBRE 2022 87 ESTADÍSTICAS
Importación de camarón de China
Autor: Sander Visch Kontali Shrimp sander@kontali.no www.shrimp.kontali.no
Ecuador
En Ecuador, los precios del HOSO y HLSO han bajado para la mayoría de los tamaños esta semana. Con el reciente aumento de brotes de COVID-19 en China, la demanda de este mercado también se ha ralentizado ligeramente. Este es particularmente el caso en el sector de servicios de alimentos, ya que los restaurantes en varias ciudades grandes han tenido que cerrar temporalmente debido a las restricciones del COVID-19. Según nuestras fuentes, los productores ecuatorianos, en particular los más pequeños, están preocupados por la caída de los precios en finca y los altos costos de producción.




Para el HOSO, los precios del tamaño 20/30 cayeron $0.30 para llegar a $5.10/kg, y los precios del 30/40 bajaron $0.60 para llegar a $3.70/kg. Los precios del tamaño 80/100 se mantuvieron estables desde la semana pasada en $3.00/kg, y el 100/120 vio un aumento de $0.20 desde la semana pasada llegando a $2.20/kg.
Precio en finca Portal semana 47 - Ecuador, Guayas - camarón blanco del Pacífico HOSO todos los tipos
Para HLSO, los precios de todos los tamaños experimentaron una caída menor esta semana. Los precios de HLSO han tenido una tendencia a la baja durante algunas semanas debido a la disminución de la demanda de EE.UU. Los precios de 16/20 y 21/25 cayeron $0.22 y $0.11 para llegar a $6.83/kg y $5.84/kg, respectivamente. Para los tamaños medianos, los precios de 41/50 y 51/60 cayeron $0.11 para llegar a $4.08/kg y $3.64/kg, respectivamente.
Precio en finca Portal semana 47 - Ecuador, Guayas - camarón blanco del Pacífico HLSO todos los tipos
- DICIEMBRE 2022 88
MERCADO
India
Después de una caída en los precios la semana pasada, los precios de esta semana se mantuvieron estables en Andhra Pradesh, pero aún son excepcionalmente bajos. Los precios del tamaño 30 se mantuvieron en $4.77/kg, mientras que los de 60 están en $3.39/kg. En Gujarat, los precios de los camarones de mayor tamaño siguieron disminuyendo, mientras que los de menor tamaño experimentaron un repunte. Los precios de 30 unidades cayeron $0.13 para llegar a $4.64/kg, y los precios de 60 unidades experimentaron un repunte de $0.12 para llegar a $3.26/kg.

Si bien se espera cosechar algo a fines de año, es probable que los precios se mantengan bajos hasta principios del próximo año, cuando podríamos ver un aumento de la demanda tanto en el mercado de la UE como en el de EE. UU.

Indonesia
En Indonesia, los precios se están moviendo lentamente, y en Java Oriental, los precios de 40 unidades aumentaron $0.14 a $4.01/kg.

Precio en finca Portal semana 47 - Andhra Pradesh - camarón blanco del Pacífico HOSO todos los tipos
Precio en finca Portal semana 47 - Java Oriental, Indonesia - camarón blanco del Pacífico todos los tipos
- DICIEMBRE 2022 MERCADO
Los precios de 100 unidades aumentaron de $3.14/kg a $3.21/kg. Los precios en Lampung también aumentaron, y los precios de 40 unidades alcanzaron los $4.27/kg, $0.06 con respecto a la semana pasada. Se observó un aumento similar para 60 y 100, alcanzando $3.87/kg y $3.47/kg, respectivamente.
El pequeño aumento de los precios en finca se debe a la baja disponibilidad de materias primas y la baja disponibilidad anticipada de materias primas en el futuro cercano. Los productores han retrasado las siembras por el momento, ya que los precios en la finca apenas cubren sus costos de producción. Como resultado, las procesadoras quieren asegurar algunas materias primas por adelantado, elevando los precios. Sin embargo, la situación general para los productores y procesadoras aún parece sombría, ya que su mercado principal, EE. UU., está menos ansioso por comprar ya que el inventario está lleno y la demanda del mercado final está baja.

Vietnam
Esta semana, los precios del camarón blanco del Pacífico en Vietnam experimentaron un repunte para las tallas de 30 y 100, mientras que las de 60 se mantuvieron estables desde la semana pasada a $4.51/kg.

Los precios de los 30 han fluctuado en las últimas semanas y alcanzaron su punto más alto esta semana durante 2022 después de ver un aumento de $0.68 desde la semana pasada para llegar a $7.68/kg. Los precios de 100 unidades experimentaron un ligero repunte de $0.08 y alcanzaron los $3.88/
Precio en finca Portal semana 47 - Delta del Mekong, Vietnam - camarón blanco del Pacífico, todos los tipos

Precio em finca Portal semana 47 - Ca Mau. Vietnam - camarón tigre negro todos los tipos
kg. Según nuestras fuentes, la producción en Vietnam es relativamente baja y las fluctuaciones en los precios en finca son el resultado de los pedidos del mercado al contado.
Los precios de todos los tamaños del camarón tigre negro continuaron su tendencia a la baja esta semana. Los precios de los tamaños de 20 y 30 cayeron $0.42 cada uno para llegar a $11.81/kg y $8.86/kg, respectivamente. Los precios de 40 vieron la caída más significativa y disminuyeron $0.85
desde la semana pasada. La caída de los precios se debe a la menor demanda en los mercados, ya que las compras de fin de año se han ralentizado•
Este informe fue escrito originalmente en inglés por Seafood TIP. El informe fue traducido por la Cámara Nacional de Acuacultura.
Para más información sobre este artículo escriba a: sander@kontali.no
- DICIEMBRE 2022 90 MERCADO

Importación de camarón de Estados Unidos
Autores: Jim Kenny jkenny@urnerbarry.com
Gary Morrison gmorrison@urnerbarry.com


Importaciones de todos los tipos, por tipo
Lo que quizás no fue una sorpresa para la industria, las importaciones de camarón de EE. UU. en septiembre disminuyeron dos dígitos por tercer mes consecutivo en la última publicación de data. Las importaciones de septiembre fueron 143.303 millones de libras o 12.1 por ciento por debajo de 162.987 millones de libras. Esto respalda aún más las expectativas de que se ha roto la tendencia estructural de aumentos año tras año. Con 1.418 millones de libras, la cifra del año hasta la fecha ahora es solo un 0.2 por ciento superior con respecto al mismo período del año pasado. La brecha se ha reducido rápidamente en los últimos meses.
Si se esperaba importaciones totales más bajas, ahora es igual de probable que las tendencias específicas de cada país también se mantengan. Aparte de Ecuador (+11.5%) continuaron enviando más camarón a Estados Unidos, nuevamente, menos envíos de India (-16.3%), Indonesia (-8.4%), Vietnam (-33.1%) y Tailandia (-15.3%). Argentina (-11.0%) y México (+0.6%) fueron mezclados, pero ambos superaron significativamente al año pasado.
En cuanto al tipo de producto, camarón con cáscara (-16.2%), pelado (-17.2%) y empanizado (-6.0%) fue menor, mientras que cocido (+12.0%) fue mayor.
Ciclos de importación mensual por país (todos los tipos)
India: con suministros locales de EE. UU. aún costosos, India (-16.3%) continuó disminuyendo el ritmo de las exportaciones de camarón a los Estados Unidos en dos dígitos. Si bien la disminución año tras año se desaceleró, sigue siendo una noticia de interés una tendencia más amplia. A pesar de esto, India siguió siendo el socio comercial número uno y representó 60.390 millones de libras o el 42 por ciento de todas las importaciones mensuales. Esto último es significativo dada la tendencia a la baja de la participación de mercado en 2022. Los envíos de camarón con cáscara disminuyeron un 40.2% en el mes, y el pelado cayó un 20.4%; mientras que se envió un 71.9 por ciento más del tipo cocido.
Indonesia: este fue otro país que se mantuvo en la tendencia, enviando un 8.4 por ciento menos de camarón que el año pasado. Los 23.342 millones de libras lo mantuvieron en el tercer lugar en el mes y en lo que va del año, y la brecha con el número dos se amplió aún más. En cuanto a la forma del producto, Indonesia envió menos camarón con cáscara (-14.2%), pelado (-9.7%) y empanizado (-33.8%); pero más cocido (+27.8%).
Ecuador: el cambio dominante en las importaciones de camarón sigue siendo el país de Ecuador. Si bien los factores comerciales durante el COVID-19 lo obligaron un poco a aumentar el comercio con los Estados Unidos, la dedicación continua de ser un socio comercial no va a desaparecer. Las importaciones desde Ecuador aumentaron un 11.5 por ciento en septiembre, elevando el total del año hasta la fecha a 340.025 millones de libras. Todas las categorías mostraron crecimiento con camarón con cáscara (+12.6%), pelado (+4.7%) y empanizado (+104.0%) superior.

- DICIEMBRE 2022
92
Urner Barry
Importaciones de camarón pelado por año (YTD) e importación promedio $/lb

Fuente: USDOC. Urner Barry
Vietnam y Tailandia: otros principales países asiáticos volvieron a enviar menos camarón que el año pasado. Una vez más, no fue una sorpresa que Vietnam (-33.1%) y Tailandia (-15.3%) enviaran menos.
Importaciones de camarón con cáscara, cíclicos y por tamaño
Las importaciones de camarón con cáscara, que incluyen el pelado fácil, fueron casi igual al mes pasado, con un 16.2 por ciento menos en septiembre que en 2021. Luego, las importaciones cayeron un 0.6 por ciento durante los primeros nueve meses.
Ecuador siguió siendo el mejor en esta categoría y el único ganador de los países top. Las importaciones aumentaron un 12.6 por ciento y se sitúan un 11.9 por ciento por encima de los niveles del año hasta la fecha. Indonesia (-14.2%), India (-40.2%) y México (-4.1%) enviaron menos. Casi todos los tamaños disminuyeron, pero hubo ganancias en los tamaños 31-40 y 41-50.
Los valores de reemplazo (importación $/ lb.) fueron más bajos ya que las presiones competitivas están al frente y al centro en el mercado del camarón. Los suministros son muchos y la demanda no sigue el ritmo. El precio promedio por libra cayó $0.14 por libra a $3.87 por libra.
Valor agregado, importación de camarón pelado
Las importaciones de camarón pelado volvieron a caer (-17.2%), encabezadas por descensos generalizados de India (-20.4%), Indonesia (-9.7%), Vietnam (-53.2%), Tailandia (-36.4%) y Perú (-78.0%) superando una ligera ganancia de Ecuador (+4.7%).
Los valores de reemplazo (importación $/lb.) para el camarón pelado también se deterioraron, dado el mismo contexto discutido en la sección anterior. Los precios bajaron otros $0.09 por libra a $4.01 por libra.
Las importaciones de camarón cocido (agua tibia) se revirtieron y fueron un 12.0 por ciento más altas en septiembre y ahora son
un 9.6 por ciento más altas en lo que va del año.
Las importaciones de camarón empanizado disminuyeron un 6.0 por ciento en el mes, pero siguen siendo un 16.0 por ciento más altas en lo que va del año.

Importaciones de camarón cocido, empanizado y otros
El precio del camarón cocido terminó septiembre en $4.98 por libra, $0.15 por libra menos. Las presiones de precios no discriminaron categorías.
Línea de tiempo del precio del camarón; anuncios minoristas
Minoristas: El mes de los productos del mar ayudó a impulsar un aumento en las
Importaciones de camarón distribuidas por tipo de producto
Fuente: USDOC. Urner Barry
- DICIEMBRE 2022 93 REPORTE DE MERCADO
oportunidades de compra para octubre. Urner Barry registró la cifra más alta en octubre desde 2018, un 21% más que en septiembre y un 14% por encima del promedio observado entre 2019 y 2021. Los precios subieron un poco después de la fuerte caída del mes pasado, ya que los minoristas sintieron que el camarón presentaba un valor para el consumidor incluso a precios más altos. El precio minorista promedio fue de $7.92 por libra, en comparación con $7.79 por libra.
Exportación de camarón ecuatoriano
Ha habido una presión significativa sobre los precios, dado el entorno empresarial. Las importaciones han crecido, el interés de compra en los Estados Unidos es mínimo, el costo de capital es alto y el almacenamiento es mínimo. Todo esto ha producido un entorno competitivo para el camarón blanco de cultivo. Incluso donde vimos algún apoyo, en particular en el producto de camarón con cabeza, también ha estado ausente recientemente. China ha ralentizado las compras y también se ha movido gradualmente a través de los precios•


- DICIEMBRE 2022
REPORTE DE MERCADO



Sector camaronero: medida anunciada

precios del mercado
El sector camaronero calculó que el anuncio del Presidente, Guillermo Lasso, en torno a la eliminación del precio diferenciado del diésel incrementará los costos de producción en 16 centavos por libra, lo que afectará seriamente su competitividad e inclusive pone en riesgo de quiebra a productores más vulnerables dada la situación actual de precios internacionales.
A decir de la Cámara Nacional de Acuacultura, la decisión, que afecta al 82% de la superficie camaronera nacional, se toma en el peor momento posible y sin haber sido discutida previamente para implementar medidas compensatorias que eviten afectar al principal producto de exportación, generador de 275,000 plazas de empleo.
“Mientras se anuncia sorpresivamente esta medida, no hay una sola decisión que haya mejorado nuestra capacidad para competir en los mercados internacionales: Los acuerdos comerciales toman tiempo y no pueden considerarse como medidas de corto plazo, el proyecto de la electrificación nunca ha sido prioridad de las autoridades que, al día de hoy no lo han ejecutado; hace más de un año no se da la
CNA a través de CORDEX insiste que el Gobierno debe impulsar la competitividad de los productos de exportación
La Cámara Nacional de Acuacultura, entidad socio fundadora de la Corporación de Gremios Exportadores del Ecuador CORDEX, representante de más del 70% de la oferta exportable no petrolera, generadora de más de 900 mil empleos directos e indirectos para los ecuatorianos y de más de USD 11,000 millones en divisas, insiste en la necesidad de incentivar la competitividad de los productos de exportación para afrontar el escenario de recesión por el que transita la economía mundial.
En este sentido, representantes de CORDEX piden al Presidente de la República, que revise los temas pendientes con el sector exportador, tomando en cuenta que es responsabilidad del gobierno propiciar condiciones favorables para iniciar una transición de un país exportador de petróleo hacia un país exportador nato de productos alimenticios sostenibles y saludables, para lo cual se debe fomentar la competitividad de estas industrias.

CORDEX considera que es preciso realizar una revisión urgente de la estructura de costos de producción en lo que respecta a la carga
reforma arancelaria que baje nuestros costos, nuestros laboratorios oficiales, que deben dar un servicio eficiente por el que nos cobran más de USD 8 millones al año no reciben ni la mitad de ese recurso por parte del Ministerio de Finanzas para hacer sus labor. El Gobierno nos obliga a comprar soya local que cuesta 50% más caro que la soya importada; sólo eso nos cuesta USD 15 millones al año. Es el sector privado subsidiando la ineficiencia del sector público”, reiteró José Antonio Camposano, Presidente Ejecutivo de la Cámara Nacional de Acuacultura.
tributaria, impuestos, , tasas, tarifas de servicios y demás aportes y cargas que han sido trasladados al sector exportador. Requieren viabilizar la reducción arancelaria, como la ejecutada hace más de un año y aplicar mecanismos de compensación como el drawback. Advierten que de no darse una reducción de la excesiva carga de sus gastos será muy difícil competir internacionalmente y los productos ecuatorianos correrían el riesgo de perder cuota de mercado en sus principales destinos.
- DICIEMBRE 2022 98 NOTICIAS
por el Gobierno de Ecuador incrementará el costo de producción afectando seriamente su competitividad en el peor momento de
Centro de Investigación especializado en camarón se inauguró en Guayas - Ecuador

El Centro de Investigación Guayas se encuentra ubicado en el kilómetro 4.5 de la via Durán – Tambo y fue inaugurado el lunes 17 de octubre pasado.
La nueva instalación de 6,1 millones de dólares es una estación de investigación y desarrollo de clase mundial, completamente dedicada al cultivo de camarones, que establece a Skretting en la plataforma ideal para ampliar conocimientos sobre la nutrición y la salud del camarón.
Skretting Aquaculture lnnovation Guayas incorpora tecnología de punta, con laboratorios totalmente equipados y unidades experimentales de última generación, donde se realizarán ensayos críticos en camarones blancos (Litopenaeus vannamei). La estación también cuenta con tanques que permitirán realizar múltiples estudios en condiciones que simulan el entorno de la producción comercial. Estudia todas las etapas de la producción de camarón, desde la primera etapa de larvas hasta los animales en tamaño de cosecha. Las simulaciones y evaluaciones incluyen parámetros de salud y bienestar, así como el crecimiento y la eficiencia alimenticia. Otra área de enfoque clave será la digestibilidad de ingredientes

de alimentos nuevos y existentes y las dietas balanceadas. Para este propósito, se implementarán y desarrollarán biotecnologías sofisticadas.
El equipo humano de la nueva estación contará con el apoyo de la red global de expertos científicos de Skretting y sus unidades globales de investigación.
- DICIEMBRE 2022 NOTICIAS EMPRESARIALES
Cargill formará un Joint Venture para aumentar su capacidad de producción de alimento balanceado para el mercado de camarón en Ecuador
El Dr. Mark Lyons, presidente y CEO de Alltech VISITÓ ECUADOR
A través de este joint venture con Skyvest, Cargill Aqua Nutrition incrementará su capacidad de producción de alimentos para camarones al operar la instalación de producción de balanceado que actualmente es propiedad de la subsidiaria de Skyvest, Empagran, ubicada en Guayaquil, Ecuador. La planta, que ahora será operada por Cargill Aqua Nutrition, fue construida en 2018, tiene una capacidad de producción de 156.000 toneladas métricas y emplea a más de 200 personas. Se espera que la transacción, que está sujeta a aprobaciones regulatorias, se cierre en los próximos meses.


BioMar nombra a Andrew Campbell como CEO de AQ1
El ejecutivo de AKVA, Andrew Campbell, asume el cargo de CEO de la empresa. El fundador, Ross Dodd, permanece en un puesto ejecutivo, contribuyendo al crecimiento futuro de la empresa.

Después de un período de gran crecimiento como el proveedor mundial de sistemas inteligentes de control de alimentación para el cultivo de camarón, Ross Dodd decidió traspasar el puesto de director general de AQ1 a Andrew Campbell, quien ha estado dirigiendo las operaciones internacionales del Grupo AKVA. en América, Australia, Mediterráneo y Reino Unido durante los últimos 20 años.Al adquirir AQ1, BioMar anunció esta inversión como el primer paso hacia la tecnología de alimentación, avanzando hacia convertirse en un verdadero proveedor de soluciones, y Andrew Campbell en adelante liderará una estrategia ambiciosa para ir más allá del suministro de alimentos.
Andrew Campbell y Ross Dodd han trabajado juntos anteriormente en el Grupo AKVA y, durante los próximos meses, trabajarán juntos en un plan de transición.
El Dr. Mark Lyons, presidente y CEO de Alltech, (compañía global líder en la agroindustria con más de 40 años en el mercado internacional y más de 25 años en Ecuador) estuvo de visita en Ecuador dentro de su gira por Latinoamérica. El Dr. Mark Lyons inició su camino por la acuicultura en Guayaquil, evidenciando de primera mano cómo la camaronicultura en el país se ha desarrollado positivamente gracias a las nuevas prácticas de producción de camarón enfocadas en sostenibilidad, las mismas que han permitido al país romper récord de exportación combinado con una alta calidad posicionado como “El Mejor Camarón del Mundo”.
El Dr. Mark Lyons tuvo su primer contacto con la acuicultura justo en Ecuador, definitivamente le resultó grato e instructivo actualizar su conocimiento del sector y confirmar como la visión de Alltech de un “Planeta de Abundancia” cada vez más se alinea con la visión de nuestros clientes y amigos
Conscientes de que el futuro de la industria acuícola dependerá de cuan costo-eficiente, precisa y sostenible logre ser la producción de camarón. Nicovita presentó en Aqua Expo un revolucionario alimentador automático móvil y un servicio de conteo de individuos de alta precisión.
El alimentador automático móvil maximiza la eficiencia de alimentación eficiente, al otorgar una mayor precisión de la dosificación del alimento que se entrega a los camarones hasta de 1.000 kg, al día, de forma automática, reduciendo al máximo la operatividad. Servicio de conteo de individuos en piscina de alta precisión realiza un cálculo de la cantidad de alimento es uno de los principales problemas del productor.. Se trata del Servicio de Conteo de Individuos en Piscina de Alta Precisión.
Hasta este momento, no existía una tecnología que permitiera conocer con certeza el número de camarones que se criaban en una piscina. Para un productor, la limitada precisión de esta cifra involucra una posible sub o sobrealimentación y por ende, impacta el crecimiento y los costos de la producción.
- DICIEMBRE 2022 100 NOTICIAS EMPRESARIALES
en Ecuador.
Wayzata, Minnesota y Guayaquil, Ecuador – Cargill Aqua Nutrition, junto con su socio Naturisa S.A., han llegado a un acuerdo para asociarse con Skyvest EC Holding S.A. para crear un joint venture que atenderá la creciente demanda de alimento de alta calidad para camarón que existe en el mercado del Ecuador.
Instalación de producción de balanceado de Skyvest ubicada en Guayaquil, Ecuador. Foto cortesía de Empagran
Nicovita: Innovación tecnológica desarrollada en Ecuador fortalecerá el crecimiento sostenible de la industria del camarón






























 de Ecuador First Class Shrimp a todos los eventos en los que Ecuador ha participado tradicionalmente y todos los nuevos necesarios, que nos permitan llegar a nuevos mercados y más consumidores”.
de Ecuador First Class Shrimp a todos los eventos en los que Ecuador ha participado tradicionalmente y todos los nuevos necesarios, que nos permitan llegar a nuevos mercados y más consumidores”.














 Jorge Pérez-Bouzada Expositor
Jorge Pérez-Bouzada Expositor




 Lexi Vera Expositora
Lexi Vera Expositora

Autores: Evelynne Calle Christian Reyes cargosurveys@marsurveyor.com
Autores: Evelynne Calle Christian Reyes cargosurveys@marsurveyor.com


















































